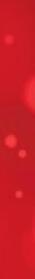

SCULPTED CABLE COLLECTION





































Bright, twinkly lights. Magical displays. A snow-filled wonderland.

![]()






















SCULPTED CABLE COLLECTION






































Did we mention the parade? A visit from the man in red fur himself? Oh, and the lights? Thousands upon thousands of bright, shiny gems lighting everything up just for you. Ahh, a real hometown holiday. Plan your visit at Corinth.net, and come home to Corinth this season.













We uncover some local jewels, with the help of one jolly ol’ elf. 38 Home on the Range
An audacious regenerative farm offers a new model for the regional food economy. ~ by sono motoyama
The Art of Living
David Lusk and Carissa Hussong’s art-filled home is a Memphis treasure.
Finding the Center
Paul Chandler and GPAC have a long history together.
72 Keeping the Beat Alive
Local music organizations are developing creative ways to fund programs and artists. ~ by alex greene and samantha cooke
Jerry Phillips
The son of Sun pours a lifetime of music into a new album cut in his father’s world-famous studio. ~ by alex
Lili Clark brings a fresh approach to the bar at Acre.
The city’s most extensive dining listings.
Searching for the Bear
Paying respects to a legend. ~ by frank murtaugh








































































CEO AND EDITOR-IN-CHIEF anna traverse
EXECUTIVE EDITOR michael finger
MANAGING EDITOR frank murtaugh
SENIOR EDITORS jon w. sparks, abigail morici, bruce vanwyngarden
STAFF WRITERS alex greene, chris mccoy
EDITORIAL INTERN samantha cooke
CONTRIBUTORS jesse davis, michael donahue, sono motoyama, vance lauderdale
4
CREATIVE DIRECTOR brian groppe
ADVERTISING ART DIRECTOR christopher myers
GRAPHIC DESIGNER neil williams
PHOTOGRAPHERS rinn allen, kristen archer, danielle atkins, justin fox burks, houston cofield, michael donahue, jim herrington, chris m. junior, larita mathis, sono motoyama, frank murtaugh, john pickle, jon w. sparks, anna traverse, bruce vanwyngarden
4
SENIOR ACCOUNT EXECUTIVE shaune mcghee
ACCOUNT EXECUTIVES kelli dewitt, chip googe, patrick pacheco




4 published by contemporary media, inc. memphis, tennessee 901-521-9000 subscriptions: 901-575-9470
4 CONTROLLER lynn sparagowski
CHIEF REVENUE OFFICER jeffrey a. goldberg
CHIEF OPERATING OFFICER margie neal
DIGITAL SERVICES DIRECTOR kristin pawlowski
WAREHOUSE MANAGER chet hastings
NEWSSTAND CONSULTANT joe luca
SPECIAL EVENTS DIRECTOR molly willmott
4
PUBLISHER EMERITUS kenneth neill
november 2024


By Anna Traverse
As autumn began, Lily Bear — forager, hiker, earth-sniffer, cat-chaser, truck-barker, big floofer, dog of my heart — left this earth. She was 9 years old, we think, give or take. For the last 7 of those years, I got to be her human. She was my best friend, my adventure buddy, my protector. She came to me nervous and traumatized from a difficult situation, and we learned together how to be braver and bolder. I will miss her forever, and love her longer.
I met Lily in a Waffle House parking lot on a bright July afternoon in 2017. I had first seen her in photographs on my laptop screen as I scrolled a dog-adoption site late one night — her big, deep-dark eyes, her golden caterpillar eyebrows, the way she seemed to be looking straight back at me. She was being fostered on the far side of Tennessee, bordering Virginia — a logistical hurdle — and still an apartment-dweller then, I wasn’t convinced I was ready for a dog. But her licorice jelly-bean eyes, her gold-tipped ears: I looked at her, and knew. She was my dog; I was her human.
To love a dog is to love a mystery. Lily was my shadow, and I was hers; I spent more time with her than I have with any human in my adult life, even more so since the pandemic. But there was so much she could never tell me. I have some inkling of what her life was like before we met, but only some. I know the person who had charge of her before she was rescued didn’t want her, treated her poorly. I don’t know where she was born, or what she looked like as a puppy, or who her parents were. She was flustered around big, diesel-engine trucks, though she couldn’t tell me why, rearing up to warn them off and satisfied when they left. She did not approve of people coming to the door, and she told them so. She never, ever hurt anyone, but if she wasn’t so sure about you, she might show you all her teeth. Just so you’d know. Rrrrr.
amined, given different meds. Still struggling with the leg, she was referred to the vet hospital at Mississippi State in July, and the doctor who examined her there broke the news to us. It wasn’t tendinitis, but an osteosarcoma that had eaten away the elbow and metastasized to her lungs. By the time she had started limping, it was already too late. My girl,

In June, Lily started limping while on a walk around the neighborhood, ginger about stepping down on her front left leg. I called the vet the next morning, took her in to be examined. She was diagnosed with tendinitis in her elbow, given meds, and we saw some mild improvement, but not enough. She was reex-
stoic beyond reason. With aggressive treatment, including an amputation and chemotherapy, we could buy her possibly a year, probably less. But the treatment would be grueling, and she wasn’t a good candidate for amputation, thanks to arthritis in her hips. We spent six heartbreaking, heart-filling weeks with her. On
a sunny morning in October, we said goodbye to Lily at home.
If you’ve been reading this magazine for a while, you’ve met Lily. She was on our cover once — the only dog to be a cover model for Memphis Magazine — pictured in the act of taking down a rainbow sno-cone from the original Jerry’s. (So many sno-cones were sacrificed that day.) On a lark, I suggested we include her in our yearly Who’s Who list among all the local notables, arguing that she was a very notable dog; my colleagues agreed (??) and she was included in the list for several years in a row, directly in between the head of the FedEx St. Jude Championship and Henry Turley. Lily also authored several pieces for us — I confess I was her scribe, but she earned her byline — about her life and times. She was a lady of many talents.
Lily was a dog, but like all dogs who are loved the way they should be, she was also family. I always knew I would struggle when she left, and I have. As I write this, more than a month has passed, and it still feels so strange to walk downstairs in the morning and not shuffle immediately to the back door to let the dog outside. It’s strange to come home from work or errands and not be greeted at the door with wags and twirls.
I doubted initially whether I would write about losing Lily in this space — I’m still so sad, and the sadness feels so personal. But so many of us are dealing with one issue or another that may feel too sad, too personal to share, and here’s the thing: When we talk about those things, the clouds lift just a little. Not a single person I’ve told about Lily has responded coldly or dismissively. People may not be quite as easy to love as dogs, but the folks I’ve surrounded myself with are almost there.








28TH ANNUAL QUILT & FIBER ARTS
SHOW AND SALE View around 100 antique, vintage, and modern quilts, plus meet with vendors and demonstrators and see a new special exhibit. DAVIES MANOR HISTORIC SITE, NOVEMBER 1–3, 10 A.M.– 4 P.M.
WE ALL WE GOT: A BINGHAMPTON PLAY Inspired by hundreds of real Binghampton neighborhood stories, this play follows two girls with starkly different lives as they come of age in the same vibrant and unpredictable neighborhood. FIRST BAPTIST BROAD CHURCH, NOVEMBER 1–3
BROAD AVE. ART WALK Artists and makers, live music, a kids craft area, and fun activities come together for this art walk. BROAD AVE. ARTS DISTRICT, NOVEMBER 2, 11 A.M.–5 P.M.
DIA DE LOS MUERTOS PARADE AND FESTIVAL Honor your ancestors and celebrate the cycle of life and death at this festival of art-making, facepainting, music, performances, and more. MEMPHIS BROOKS MUSEUM OF ART, NOVEMBER 2, 11 A.M.–3 P.M.
IRIS COLLECTIVE ORCHESTRA: TRANSFORMATIONS Memphisnative Randall Goosby and conductor and Iris founder Michael Stern will be joined by Germantown Youth Symphony in this performance. GERMANTOWN PERFORMING ARTS CENTER, NOVEMBER 2, 7:30 P.M.
MEMPHIS JAPAN FESTIVAL Celebrate the history, culture, and people of Japan at this family-friendly, interactive and hands-on experience of Japanese culture featuring food, entertainment, games, crafts, and
more. MEMPHIS BOTANIC GARDEN, NOVEMBER 3, 9:30 A.M.–4 P.M.
THE THREE BS: BACH, BRAHMS, AND BEETHOVEN Memphis Symphony Orchestra presents a two-night performance. CROSSTOWN THEATER, NOVEMBER 1, 6:30 P.M. | SCHEIDT
FAMILY PERFORMING ARTS CENTER, NOVEMBER 3, 2:30 P.M.
TAIKOPROJECT Taikoproject takes audiences on a journey tracing the history and lore of the ancient Japanese drums. BUCKMAN PERFORMING ARTS CENTER, NOVEMBER 7, 7 P.M.
JUNIE B. JONES: TOOTHLESS
WONDER This family-friendly show will take audiences on a humorous journey of growing up with Junie B. Jones. THE CIRCUIT PLAYHOUSE, NOVEMBER 8–DECEMBER 22
THE ORCHESTRA UNPLUGGED: LEONARD BERNSTEIN Music Director Robert Moody of the Memphis Symphony Orchestra guides audiences through the life and legacy of the American Maestro. HALLORAN CENTRE, NOVEMBER 8, 7:30 P.M.
PARALLEL LIVES Two actresses play men and women struggling through the common rituals of modern life. THEATRE MEMPHIS, NOVEMBER 8–23
MEMPHIS CRAFTS & DRAFTS
FESTIVAL: HOLIDAY MARKET Crafts & Drafts showcases local artists and makers, where you can shop for all your holiday gifting needs. CROSSTOWN CONCOURSE, NOVEMBER 9, 10 A.M.–4 P.M.
VALERIE JUNE Born and raised in the flatlands of West Tennessee, Valerie June is an artist steeped in the deep, musical culture which surrounded
her. GERMANTOWN PERFORMING ARTS CENTER, NOVEMBER 9, 8 P.M.
INDIE MEMPHIS FILM
FESTIVAL Discover new independent features, documentaries, and short films from up-and-coming filmmakers, as well as independent powerhouse distributors. VARIOUS LOCATIONS, NOVEMBER 14–17
THE WIZARD OF OZ Dorothy isn’t in Kansas anymore. PLAYHOUSE ON THE SQUARE, NOVEMBER 15–DECEMBER 22 SCIENCE OF SPIRITS This fundraising event mixes spirits tasting, food pairing, and fun activities that explore the science of making spirits. LICHTERMAN NATURE CENTER, NOVEMBER 15, 6–9 P.M. THE ORPHEUM SOIREE Enjoy an evening including glittering entertainment, live auction, specialty cocktails, exciting eats, and fun surprises. ORPHEUM THEATRE, NOVEMBER 15, 7 P.M. CHILLY CHILI 5K AND 1-MILE FAMILY FUN RUN FOR NEURODIVERSITY Hosted by and benefiting Concord Academy. 4942 Walnut Grove Rd. NOVEMBER 16, 9 A.M.
JOHN MCEUEN & THE CIRCLE BAND Founding member of The Nitty Gritty Dirt Band and celebrated banjo player John McEuen brings music and stories from across his legendary career. BARTLETT PERFORMING ARTS & CONFERENCE CENTER, NOVEMBER 16, 7:30 P.M.

CHILLY CHILI 5K AND 1-MILE FAMILY FUN RUN FOR NEURODIVERSITY

THE RAKE’S PROGRESS Opera Memphis presents Igor Stravinsky’s neoclassical opera, where a man trades his soul in exchange for fame and influence. SCHEIDT FAMILY PERFORMING ARTS CENTER, NOVEMBER 22, 7:30 P.M., NOVEMBER 24, 3 P.M.
NUTREMIX New Ballet presents its take on Tchaikovsky’s The Nutcracker, setting the story on Memphis’ iconic Beale Street. CANNON CENTER FOR THE PERFORMING ARTS, NOVEMBER 23–24
WHO’S HOLIDAY Cindy Lou Who returns in this riotously funny and heartwarming adults-only comedy. CIRCUIT PLAYHOUSE, NOVEMBER 22–DECEMBER 22
A MOTOWN CHRISTMAS Celebrate the holiday season with this musical of all your favorite Motown tunes. HATTILOO THEATRE, NOVEMBER 22–DECEMBER 22
HOLIDAY SPIRITS: A CHRISTMAS COCKTAIL FESTIVAL Sip festive cocktails, enjoy sweet treats, snap fun photos, and jingle along to holiday tunes. THE KENT, NOVEMBER 22 CHAPEL HART CHRISTMAS Chapel Hart returns with a special Christmas show, filled with original and traditional holiday songs along with their signature upbeat country music. BARTLETT PERFORMING ARTS & CONFERENCE CENTER, NOVEMBER 22–23, 7:30 P.M.
JUSTIN TIMBERLAKE Memphis’ own renowned musician, actor, and entertainer Justin Timberlake brings his “The Forget Tomorrow World Tour” to the FedExForum. FEDEXFORUM, NOVEMBER 23, 7:30 P.M.
PETER PAN This high-flying musical comes to Memphis. ORPHEUM THEATRE, NOVEMBER 26–DECEMBER 1
To suggest an event for future editions of Out and About, email abigail@memphismagazine.com.

NOV. 29 - DEC. 29 SELECT DATES







GLOW UP YOUR HOLIDAYS!

In business for more than 50 years, Dale’s has become a Southaven institution.
BY MICHAEL DONAHUE



Unlike restaurants that claimed Elvis Presley visited their eating establishment on occasion, Dale’s counts Elvis as a “regular.” Owner Larita Mathis remembers the King eating at Dale’s, her family’s restaurant in Southaven, Mississippi, back when it was known as “Dairy Haven.”
“He had big sideburns, I remember that,” she says. “He had the poofy hair.” Mathis, who was 8 at the time, says, “He had a lot of conversations with my daddy and my mom.”
Her parents, the late Earnest Dale Graham and Lillie Graham, were the founders/owners of the iconic pink-and-green restaurant, which opened in 1966.
e spacious, bustling restaurant, which seats about 300, contains four dining rooms.
e equally bustling menu lists mouth-watering items, including ribeyes, chop steaks, catfish platters, and the ultimately Southern “Chicken Fried Chicken.”
“Chicken fried chicken is one of our best sellers,” says Mathis
the builder he would like to lease it from him and sell ice cream.
“We were going to be some of the first families to move there,” says Mathis. “He thought there needed to be a place where people could get something to eat. Not very expensive and not very fancy.” e family added on five times and changed the name from Dairy Haven to Dale’s in 1981. “We expanded the first time to a roast beef place with a salad bar and burgers. We still had ice cream at that time. en we expanded here again in the early ’80s. When we took out the salad bar and added steaks, we changed the name to Dale’s.”
and he was an old guy to me then.”
Her dad would ask Elvis, “Can you give me an autograph for my daughter?” And she says he always would. She recalls that he ordered milkshakes and corndogs, neither of which they now sell.
Elvis, who often drove up on his motorcycle, wore “the whole leather outfit with the pants and everything.” He sometimes visited with a group.

Desserts include chocolate pie (above) made from Larita Mathis’ grandmother’s recipe, and lemon pie and banana pudding from her mother’s recipes.
People watched her dad cooking steaks in a charcoal pit from a little front window, and “everything smelled like charcoal.” ey added one more room, began serving vegetables, and the menu became what it is today. “We have burgers, salads, and a lot of choices,” says Mathis, adding, “everything is homemade. We don’t cook anything from a can.”
Desserts include chocolate pie made from her grandmother’s recipe, and lemon pie and banana pudding from her mother’s recipes.
“We take a chicken breast, hand-bread it, and deep-fry it.”
With white gravy on the side, of course.
Dale’s also offers a variety of “Specialty Potatoes,” which include stuffed, loaded, “grilled chicken loaded,” and a “grilled steak and cheese potato.” Hamburgers include the “Char-Burger,” “Bacon Burger,” “4-Star Burger,” and “Southaven Burger.”
Both of her parents were from Hurricane, Mississippi, near Ecru. Her father worked for a Memphis box container factory, but things changed when he and his wife “saw this little block building under construction.” In those days, Southaven’s Main Street was “a little dirt road back then” and he told
Dale’s will be open on anksgiving, as they are every year. “We do chicken and dressing. Customers can choose their vegetables. Homemade sweet potato pie comes with it. Yeast rolls and cornbread.”
Celebrity guests over the years have ranged from sports stars to singers. Graham had a photo made of himself with Barbara Bush when the former First Lady visited Dale’s. He put the picture on a wall but, Mathis says, “Everyone would come in and say, ‘Is that your wife?’
“He would take it down and hide it in the trunk of his car. We would find it and hang it back on the wall. It’s not there right now.”
As for the King of Rock-andRoll, Mathis says, “Elvis used to eat here all the time. I was a little kid
“We had a picnic table in front of the building. ey would go sit out at that picnic table and eat.”
Her father owned more than one Dale’s, Mathis says. “He had some 16 franchises for a while in the early ’80s. I would go around to all of them and train the employees and things like that. We eventually decided not to franchise anymore and try to keep it local.”
e family once owned a barbecue restaurant, Dale’s Smokehouse Cafe, in Batesville, Mississippi. And Mathis also owned Rocket City, a ’50s-style restaurant in Hattiesburg, Mississippi. ey kept the Hattiesburg location for a while, but later changed the name of restaurant, which was across the street from the University of Southern Mississippi, to the hipper-sounding Chesterfield’s.
Mathis’ children, Jacquelyn Mitchell and Destin Mathis, today manage Dale’s. Long-time employees include server Crystal Walls, who’s been with the restaurant for 51 years, and kitchen staff member Vita Green, who’s worked there almost 30 years.
Asked if she’d ever open another Dale’s, Mathis says, “I’ll never say I won’t. ere’s always a possibility.”
So, what happened to all those Elvis autographs? “You know what? I don’t know where they are,” says Mathis. “We had a lot of old paperwork that I found here recently and I hope they’re in there.”
Dale’s is located at 1226 South Main Street in Southaven, Mississippi.

Is your accountant familiar with your business?
At HHM, we’re more than accountants. We’re trusted business advisors. This means we provide proactive solutions and ideas to help you build sustainable growth through every season and situation you face. Discover more reasons HHM is the right partner for you at HHMCPAS.COM.

Our history expert solves local mysteries: who, what, when, where, why, and why not. Well, sometimes.
BY VANCE LAUDERDALE

DEAR VANCE: I recently purchased two framed photographs showing an old watchmaker’s shop, and I was told this was in Memphis somewhere. Can you confirm? — H.L., MEMPHIS .
above: Watchmaker
Max Sandler works in the window of his shop across from Court Square. opposite page, top: The busy interior of the U.S. Watch Company, which Sandler opened in 1954 on South Court Street. opposite page, bottom: An old postcard shows South Main, with Perel and Lowenstein marked by the large sign and billboard.
DEAR H.L.: Using the sophisticated equipment in the Lauderdale Laboratories — in this case, an electron-scanning microscope, a Spectrographic Analyzer 479-D, and the Gilbert chemistry set I received for my 12th birthday, I can say with 99 percent certainty that these photographs do indeed show a business located in Memphis.
Of course, it helped that one of the images actually shows the shop owner’s name (twice, in fact), painted on the window and also visible on a sign inside: Max Sandler, Certified Master Watchmaker & Jeweler. So, a quick check of the Memphis city directories confirmed my scientific findings. What’s more, the large clock in the photo above displays the business name: the U.S. Watch Company, which
across the street from the Gayoso Hotel, and turned it into a highclass emporium. The Commercial Appeal observed that the owners spent more than $100,000 remodeling the building — this would be the equivalent of $1.7 million today — and “now it is one of the most excellently appointed jewelry establishments in the country.”
The staff included more than 75 employees, and one of them was Max Sandler, who joined the firm in 1924 in the watch repair department. He was just 21 years old, so it’s possible that this was his first job, but because there is no mention of him in city directories before that date, I don’t know much about his early days — where he was born, or where he worked before coming to Perel and Lowenstein. Within a few years, though, he was promoted to watchmaker, and in 1936, he was doing well enough to buy his own house, at 750 Maury. The purchase price was $4,500 for the home, described as a “six-room brick bungalow, with two bedrooms, living, dining, breakfast rooms.”
was located at …
Wait — if I’m going to talk about a watchmaker, let’s do it in chronological order, and that means I should begin with a downtown business called Perel and Lowenstein. I’ll get to Max Sandler soon enough, if you’ll just be patient.
In 1910, Joseph Perel and William F. Lowenstein, described by a local newspaper as “boyhood pals who came to Memphis from Baltimore,” bought a pawn shop on South Main. Within a few years, they had transformed it into a full-scale department store, but with an emphasis on gifts and jewelry, carrying “more than 100 nationally advertised brands.” In 1929, they had become so successful they were able to purchase a four-story building at 144 South Main, just
That same year, a more important event in his life apparently took place, which I believe prompted the move to a new home. The city directories now list a wife, Anna, but they say nothing about her. If she worked outside the home, before or after the marriage, I wasn’t able to find anything about her.
Sandler — the husband, I mean — took an active interest in other groups associated with timekeeping. In 1942, he was named president of the Tennessee Watchmakers and Jewelers Association, a position he held throughout the 1940s, and also became a board member of the Tennessee Horological Society and the Horological Institute of America. In the late 1940s, Perel and Lowenstein newspaper ads usually focused on their jewelry and watches, which had become the main draw for customers. One ad noted, “Our Watch Repair Department maintains a staff of eight skilled, experienced watchmakers, under the supervision of Mr. Max Sandler,
Certified Watchmaker by the Horological Institute of America. We have the most modern equipment and are in a position to repair and recondition any watch. All our work is electronically tested, and only genuine material is used.”
In March 1954, though, Sandler decided to leave Perel and Lowenstein and branch out on his own, opening two different watchmaking and repair companies downtown. The U.S. Watch Company was located at 105 South Court, across from Court Square. That’s the business pictured here, and in fact, that’s Sandler in the window in the photo at left, and in the photo at right, he’s the fellow wearing the dark suit. His other venture, the Certified Master Watch Shop, was located at 124 Monroe, just a few doors east of Front Street.
A large newspaper ad, with a nice photo of Sandler (which helped me identify him in the two old photographs), announced the opening of the new businesses: “Mr. Max Sandler, Certified Master Watchmaker, and well-known throughout the United States for his knowledge of fine watch repairing, is now operating his own jewelry and watch repairing stores. … At these two prominent downtown locations, Mr. Sandler will personally supervise his staff of competent, efficient watchmakers and will personally take care of any special or intricate watch repair work entrusted to his care, including chronographs, automatics, and other complicated watches which require a Master Craftsman.”
Week after week, smaller ads for both shops ran in The Commercial Appeal. So just two years after he began these new enterprises, it came as some surprise — to me, anyway — when I noticed a small headline in the April 26, 1956, issue of the paper: announcing “WATCH FIRM BANKRUPT.” The story reported that Sandler’s two businesses reported assets of $22,475 against debts of $67,692, and the owner admitted, “The business lost money the past two years.”
But Sandler rebounded very quickly. Within just two weeks, he was back at his old job at Perel and Lowenstein. The store was apparently so pleased by his return that they ran a large newspaper ad, telling readers that Sandler was now the “Head Watchmaker and Technician, in charge of our Watch Department. He has been certified as a Chronograph Technician by the Ensembl-O-Graph Laboratories, has 45 years’ experience, and” — here’s something that hadn’t been mentioned in the past — “has trained in European and Swiss factories.”
Over the years, Perel and Lowenstein had greatly expanded into one of the region’s largest jewelers. By the mid-1950s, while maintaining their downtown location on South Main, they also opened branches in Poplar Plaza, as well as stores in Jackson, Tennessee; Jonesboro, Arkansas; and Mayfield, Kentucky. In the 1970s, additional locations in-
wrong? Well, all it takes, it seems, is a few bad years, and that’s the end. The entire chain closed in 1992, with company president Ron Perel, a descendent of the founder, telling reporters, “We’ve been under duress for three years. We’ve had three
Mason, a member of the Scottish Rite, and past chairman of the Workmen’s Circle, a national organization designed to promote Jewish culture and social justice. Despite all the newspaper articles I discovered over the years that mentioned his watchmak-


cluded Southland Mall and the Northgate Shopping Center.
Described as “the state’s largest chain of jewelry stores,” it would seem that Perel and Lowenstein — which had weathered the Great Depression, World War II, and the demise of downtown during the 1970s — would stay in business forever. They had multiple locations, offered merchandise by catalog sales, and even lured customers with a variety of enticements — including “A Full Year To Pay!” What could go
bad Christmases in a row. The retail economy doesn’t appear to hold any excitement on the horizon. Customers have gotten so guarded in their buying habits, especially for luxury items.”
I don’t know how long Max Sandler stayed with Perel and Lowenstein, but he devoted more than half a century to the watchmaking profession. He passed away in 1986 at age 83. In addition to his lifelong membership in various horological societies, he was a Shriner, a 32nd Degree
ing career, the obituary finally told me more about his personal life, noting that he was survived by his wife, Anna, along with other family members: a daughter, Mrs. Dorothy Hirsh of Memphis; a son, Dr. Nat Sandler of Lexington, Kentucky; three grandchildren, and even three great-grandchildren.
The Main Street location of Perel and Lowenstein (shown here in an old postcard from the 1950s) came down for the construction of Peabody Place. The two smaller buildings where Sandler had opened his downtown watchmaking businesses have survived. The last time I drove by, the Court Square location — where these older photos were taken — was empty, waiting for new tenants. But 124 Monroe Avenue is now part of McEwen’s restaurant.
Got a question for Vance?
EMAIL: askvance@memphismagazine.com
MAIL: Vance Lauderdale, Memphis Magazine, P.O. Box 1738, Memphis, TN 38101
ONLINE: memphismagazine.com/ask-vance Or visit him on Facebook from time to time.
BY JESSE DAVIS

“Food is not rational. Food is culture, habit, craving and identity.”
— jonathan safran foer
At a book-signing not long ago, someone in the audience asked Nashville-based, New York Times -bestselling cookbook author and food writer Anne Byrn why Southern food — and particularly Southern baking — has captured the American imagination. What makes it so special?
As the “Cake Doctor” and former food editor of e Atlanta Journal-Constitution and e Tennessean, Byrn has the bona fides to answer that question, if anyone does. But she didn’t have an immediate answer that day, the author remembers, so she turned the question over to the audience, who chimed in with many answers of their own: Southern
baking is special because it’s your family’s cooking, because it has its own love language. It’s the biscuits. It’s the cornbread. ough no one agreed on the why of the matter, everyone agreed that Southern baking is special. The question stuck in Burn’s head, and she set out to answer it with Baking in the American South: 200 Recipes and eir Untold Stories


(Harper Celebrate).
“I wanted this book to be representative of the South,” Byrn explains. “I wanted a diversity of people, a diversity of ages. I wanted to have cooks as well as some pastry chefs.”
Baking in the American South holds humble as well as over-thetop recipes. e author included

200 recipes from 14 states and wanted to make sure to find a balance between them, to depict the South and its cooks authentically.
In that, Byrn’s newest effort is a triumphant success. e book is a buffet of gluten-fueled gourmet delights, and the author has not neglected rice- and corn-based recipes either. Her measurements are as exact as any chef’s as she doles out delicious recipes alongside U.S. history lessons and heart-warming stories.
Byrn’s beginnings as a writer can be traced back to her time breaking news stories
as the editor of her high school newspaper, Logos II. “I really loved knowing what was going on,” she remembers. “I was always curious, and it was a great way to channel that curiosity.”
Byrn graduated from the University of Georgia with a portfolio full of news clippings. After learning of a job opening for e Atlanta Journal as a food writer, she interviewed for the position. “I had never written about food,” she says, but she thought “what the heck?”
“ ey asked me if I could fry chicken,” the author remembers, “and I said, ‘Oh yeah, I can fry chicken,’ because I used to help my mom.”
It was the perfect job for someone who liked to know what was going on. “ ere was a lot happening. It was Atlanta in the late ’70s, ’80s, and Atlanta was booming,” Byrn remembers.
“I grew up on the job,” she says. Byrn admits that sometimes it felt intimidating to interview people who had been cooking all their lives, who themselves were a thread in a much older tapestry of traditions. Her curiosity served her well, though, and she approached the work as a journalist. Whether she was learning about the pecan business or the shrimping industry, regional variations in cornbread recipes or subtle variations in sugar substitution plans, her strategy remained the same: Ask a lot of questions. “I never acted like I was a food expert,” she says.
That’s why, when The Atlanta Journal wanted her to review restaurants, she put her foot


down. “I don’t have professional experience to do this. I mean, this is someone’s livelihood,” Byrn remembers thinking. So she took a leave of absence and went to France to study cooking.
Such is the level of her commitment. Byrn is not someone who trades in half-measures, and her attention to detail and passion for her work were put to use in the making of her cookbooks.
BAKING BELOW THE MASON-DIXON
Byrn’s newest cookbook is a treasure trove. Baking in the American South is a cornucopia spilling over with mouth-watering recipes, lush and literary remembrances, facts and historical context, and beautiful photographs — of the food, the chefs and cooks who’ve prepared it, and old, handwritten recipe cards. It over-delivers, and the reason why is clear: e author’s curiosity and enthusiasm for the subject matter shine through on every page. And, of course, like every treasured recipe, it’s a bit personal too.
“My mother was a really great baker. Being raised in the South, everything was homemade,” Byrn says of her childhood. She remembers her mother’s chess pie and banana bread, and her aunt’s banana pudding. They were sacred recipes for her family, Byrn says, and every family has their own.
Such is the story of Southern baking. It’s not one story, but an infinite number of individual stories, all of them regional and personal variations on a familiar recipe. Church gatherings,
quiltings, barn raisings, funerals, graduations — the particular ingredients and the event for which the baked goods are made influence what is cooked and how it’s cooked.
“Land and climate in the South differ from the rest of America,” Byrn writes in Baking in the American South. “Sandy Gulf coastlines, snaky bayous, black-soiled farmland, lush river deltas, family farms where fig trees grow as tall as houses, and mountains encircled in a smoky blue haze define our land.”
e author’s indisputable familiarity with her subject matter lends her voice a confidence borne of experience. She has driven these Southern roads herself, for her family and her career. She has lived in the landscape, spoken to the people whose lives and livelihoods are intertwined with the land, and has told the story of the South and its culinary traditions as her career.
Her own family history with baking, her career, and her research have all influenced the making of Baking in the American South, making the fi nal product almost as complex and nuanced as the history of the region it chronicles.
The South, more than any other region, bakes inside the home, though Byrn admits the Midwest is catching up. In this way, the home kitchen has become a central part of public, communal life in the South. ere are many reasons for this. After the Civil War,
While chocolate chess pie is popular in almost every state, it is especially revered in Mississippi, where you’ll find it at funeral wakes, fancy dinner parties, and even filling stations. It’s just pantry ingredients, but when served warm with buttermilk ice cream, it’s suitable for royalty! Best of all, it is a good starter pie for beginning bakers to make on their own. Keep it uncomplicated like it was intended to be. Pass on the fancy chocolate and stick with basic cocoa powder. Opt for canned milk, not heavy cream. Save some time and buy a frozen piecrust. This recipe is adapted from the fan-favorite Junior League of Jackson, Mississippi, cookbook, Southern Sideboards (1978).
Prep: 10 to 15 minutes
Bake: 40 to 45 minutes
1 (9-inch) pie crust
1/4 cup (25 grams) unsweetened cocoa powder
3/4 cup plus 2 tablespoons (175 grams) granulated sugar
1/2 cup (96 grams) lightly packed light brown sugar
1/4 teaspoon salt
2 large eggs, lightly beaten 4 tablespoons (1/2 stick/57 grams) unsalted butter, melted 1 can (5 ounces) evaporated milk
1 teaspoon vanilla extract
Whipped cream or The Lee Brothers’ Buttermilk Ice Cream for serving
1. Crimp the edges of the pie crust and set aside in the fridge.
2. Heat the oven to 350°F, with a rack in the lower middle.
3. Whisk to combine the cocoa, both sugars, and the salt in a large bowl. Add the eggs, melted butter, evaporated milk, and vanilla. Stir to combine. Pour into the unbaked crust and place in the oven.
4. Bake until the crust has lightly browned and the filling has just set, 40 to 45 minutes. Remove and let cool for 1 hour, then slice and serve with whipped cream or buttermilk ice cream.
while the North flourished, the South struggled. Urban centers in the North developed commercial bakeries, but the same trend was not as apparent in the South.
Byrn’s meticulously researched book explores the historical trends that shaped Southern society, and the ways those trends affected recipes. Take, for example, banana pudding. at sweet Southern staple is an example of the way different influences and regional access to goods changed a recipe that’s graced countless backyard cook-outs.
“The South has a decidedly English influence on a lot of its baked goods,” Byrn explains, noting that the British trend of stovetop custard, when combined with an easy access to bananas
from coastal cities, helped birth the recipe.
“If you’re going to cook with an ingredient rather than just eat it out of hand, that means you have access to ingredients,” Byrn says. “If you have a lot of bananas on hand and they’re cheap, you’re going to make a pot of banana pudding.
“Bananas would be dropped on docks,” she continues. “Cooks in the South have foraged for food in all sorts of ways.”
e story of Southern baking traditions is one of resilience, of the search for deliciousness — for life’s fleeting small joys. It is a story of community and family, of scarcity overcome, and it is a story still being told today, in kitchens across America.

– Thurmeisha White, Youth Villages employee
It takes a family to find just where you belong.
Creative, adaptable, focused, resilient and determined. Is this you?
The right path feels less like a job and more like a calling. Is this you?
Doesn’t shy away from hard work with a powerful payo . Is this you?
A company with national reach that feels like a family.
That’s Youth Villages.
BY CHRIS M C COY
The holiday season is supposed to center on togetherness and renewal. And yet, for the next six weeks, you’ll probably find yourself running from office parties to holiday wine and cheese receptions; shopping for the perfect gift for your children, family, and friends; hanging decorations; making travel plans, navigating crowded airports, stewing in traffic jams, eating and drinking a lot, socializing with friends, communing with family, worrying about how much all this is costing, and generally uprooting your normal routines.
is is part of the charm of the holidays, of course, and detaching from your normal routine is a big reason why the season is valuable. But it is also, undoubtedly, a source of much stress. For some people, the holidays are not a time of rejuvenation, but an annual blow to their mental well-being.
“ e holiday time is a time of celebration and joy,” says Lenora Coleman, director of outpatient services at Lakeside Behavioral Health. “Everybody’s happy, and you’ve got family gatherings. But it’s also a time that’s very stressful for the same reasons, because sometimes those family gatherings can be challenging. Challenging in our interactions with our family members. Challenging from the
standpoint of the expectations that family members have with us. It can be overwhelming for us at time.”
Also, she adds, “ e holiday season can be stressful for financial reasons. We have expectations of giving and travel and parties and all of the social events. So it’s celebration and joy, but it’s also very stressful during that time.”
Coleman has been working in the mental health field for more than four decades. “I’ve worked with all populations,” she says, “and done a small amount of work with children, but mostly adults with serious and persistent mental illness: schizophrenia, bipolar illness, major depression, anxiety disorders, and substance use disorders.”

Mental health professionals see an uptick in patients presenting with serious concerns every year around the holidays. “If you happen to be an individual who’s already struggling with mental health concerns or with substance use, then that added stress of the holiday time just adds to it,” says Coleman. “So we tend to see an increase in depression. We see an increase in anxiety. We also see an increase in substance use during that time. Some of that is part of what we call the holiday blues.”
How do you beat the holiday blues? Coleman says the most important part is not to get too caught up in expectations — your own or those of others. Remember that none of the fun is mandatory. If you start to feel overwhelmed, it’s okay to opt out.
Family
















































“A lot of times we’re just not honest with what our struggles, our challenges are. Once you’re able to be honest, then you can draw on support from others.”
—Lenora Coleman director of outpatient services at lakeside behavioral health
“If you’re struggling with substance abuse, and you know the holiday party can be a trigger for you, it’s probably best to skip it. It’s not just the holiday party itself, it’s all of the anxiety around it.”
is is especially true if it’s an environment where people don’t really know you’re struggling with substance abuse. Coleman says people who find themselves in these situations ask themselves, “Okay, what do I do? Do I have one drink, or do I explain what’s going on? at can be a trigger for you [which] can lead to an increase in your sadness and your loneliness.”
She notes that people often have other support systems, “your family members and friends, going to the party and you’re choosing not to go to a party because it is going to be such a trigger or a challenge for you.”
If opting out is the source of more pain than opting in, Coleman says to go in prepared. “ e first thing is — and this is in any situation — you’ve got to have a plan. It may be that you have a support person there with you. ey can be with you when choose to step outside and take a break. Interact with your core friends, family members, or supporters who do not use substances. Draw from your support systems during that time.”
She also says to be honest with your feelings. “A lot of times we’re just not honest with what our struggles, our challenges are. “Once you’re able to be honest, then you can draw on support from others.”
Financial stress is common around the holidays, from pressure to give expensive gifts






and pay for travel. Coleman says not to lose sight of the point of gift-giving: A simple, thoughtful gift can have more meaning than an expensive, generic one. “The special attention that you put into your gift is for your family members. And sometimes, the gift is just the time that you have available to spend with them, more so than the monetary things.”
If you, like millions of Americans, are traveling for the holidays, Coleman says the key is to keep it simple. “If you’re driving, limit the amount of time you’re spending in your vehicle,” by breaking up the trip into smaller sections, she says. “Direct flights are always less stressful than where you’re having to make multiple stops, trying to figure out what
Keep in mind that social media is not reality. Everyone is putting their best foot forward, and editing out their problems. No one puts their kids’ Christmas morning meltdowns on Instagram.
gate you need to get to, worrying if we’re going to get there on time to make your connection, and running through the airport. I can’t think of anything more stressful than that — except missing your flight and having to stay there overnight.”
On top of the holiday stressors, social media can amplify anxieties. “We spend all this time on social media looking at what other families have and what they’re doing,” says Coleman, “and all the great parties and great places that they’re able to go to, and you’re not able to do that,” says Coleman.
But keep in mind that social media is not reality. Everyone is putting their best foot forward, and editing out their problems. No one puts their kids’ Christmas morning meltdowns on Instagram. “It’s a fantasy,” says Coleman. “Kids and adults alike, we need to power down. We need to turn it off. We need to give our brains a break.”
Being with your family and friends is the best part of the holiday season, but Coleman says to save some space for yourself. “Remember to pay attention to your feelings. It’s okay to be unhappy during the holidays. Being able to recognize your feelings helps you start nurturing your feelings, and that’s important.”
She also suggests developing plans for the holidays that involves reaching out to others. “They may be your family members, your support systems, your community,” she says. “Get involved. Go to your local homeless shelter or your church group or something. Help others. Sometimes we can help ourselves when we help others.”
And if the holiday season can be a bit complicated for you, we can promise one thing: The chaos will be over before you know it.









Sometimes it can be a challenge to select the perfect gift for friends or family. It shouldn’t be that hard, though, with so many artisans and delightful shops here. So let our holiday gift guide, with its emphasis on made-in-Memphis items and locally owned stores, help you. And look, we’ve even brought along Santa Claus himself to make suggestions. If he doesn’t know how to choose a good present, who does?

Known for its staff’s proactive curation, Goner will always pique your interest with their displays or simply by playing the records they love. Good listening and good company explain why the shop is consistently named one of the nation’s best by Rolling Stone. And while Goner’s roots are in punk raucousness, they contain multitudes, as one look at their “Just In” listings reveals: jazz, country, international, avant garde, and Memphis music are all well represented. Come Black Friday’s Record Store Day, they’re sure to have all the limited-edition releases, plus their usual rare and collectible vinyl. Can’t decide? Gift cards are available. 2152 YOUNG AVENUE | 901-722-0095 | GONER-RECORDS.COM

It was 40 years ago this month that Millett Vance and Gene Rossetti opened their now-iconic Midtown vintage store. Flashback is a world-class vault of kitsch, color, and collectibles — everything you could imagine, and much you couldn’t begin to. They call it a “vintage department store” for good reason. Clothes, hats, kitchen and glassware, posters and paintings, groovy mobiles, furniture, funhouse mirrors, and even a mounted swordfish. You’re bound to find something at Flashback for everyone on your gift list, no matter your budget. Rumor has it that Flashback is where Santa got that cool red-and-white hat. 2304 CENTRAL AVENUE | 901-272-2304 | FLASHBACKMEMPHIS.COM

Holiday mornings are made magical by small delights, and City & State is a wonderland of stocking-ready delights at any price point. From an array of jewelry made by local Memphians to cocktail supplies (including an impressive selection of non-alcoholic spirits!), from cozy slippers to high-performing and cheerful dishtowels — we challenge you to name someone on your gift list who won’t enjoy a little something brought home from this cozy shop adjacent to an excellent coffee shop. Christmas morning ought to come with at least one stuffed animal, for kids and kids at heart; we’re currently in love with a particular fuzzy blue bunny at City & State. Hint, hint. 2625 BROAD AVE. | 901-249-2406 | CITYANDSTATE.US

The wise Santa knows that when Mrs. Claus wishes to show her impeccable style at Fezziwig’s party, she won’t require drummers drumming or pipers piping (they’ll be performing at the party) or dancing lords, ladies, and maids (also partying), and not all that poultry (so many swans, geese, calling birds, French hens, turtle doves, and the lone partridge), and certainly not even five golden rings — not when all that will make Mrs. C. truly swoon is a single stunning talisman of perfection from Mednikow that will catch the light around the wassail bowl exactly right.
474 PERKINS EXTENDED | 901-767-2100 | MEDNIKOW.COM





As one of the first ready-to-wear menswear stores in the country (founded in 1859), you know you can count on Oak Hall for a luxury shopping experience — now for men and women. Knowledgeable fashion experts are ready to guide you in all your gift-giving needs, whether you’re looking for the perfect pair of loafers or handbag to charm your giftee. That’s not to mention all the apparel, from formal to casual, plus the quickly returned alterations to your purchased apparel. Who doesn’t love a new addition to their wardrobe?
6150 POPLAR AVENUE | 901-761-3580 | OAKHALL.COM





Independent bookstores are known for having a staff that can help you pick out a gift book for almost anyone. Just let them know what your giftee is interested in, and they’ll come up with a great suggestion or two. Now, Novel has taken it to the next level with a personal shopper who can help you find the perfect book while you sit at home eating Christmas cookies. Just fill out the form online and they’ll get right on it. Or wait for Santa to show up. Your call. 587 PERKINS EXT. | 901-922-5526 | NOVELMEMPHIS.COM

This little shop in Cooper-Young (“PeCo” is shorthand for its location at Peabody and Cooper) has gifts for the person in your life who loves everything strange. From candles and perfumes based on Gothic novels, to antique jewelry, to gorgeously illustrated tarot cards and prints, Paradox has something that’s sure to please even the darkest of hearts. 248 S. COOPER STREET | 901-249-7562 | PARADOXATPECO.COM

Located in the South Main Arts district, Stock & Belle curates high-quality unique items for the chic and artsy in your life. From trendy clothing to made-in-Memphis art to industrial-style furniture, it’s like an artisanal department store, and we haven’t even started talking about the “gifty” items like handmade candles, Tennessee Tri-Star tea towels, Elvis ornaments, serving trays, and so much more. So stop by during a South Main Trolley Night, or for a cup of coffee from Dr. Bean’s Coffee & Tea Emporium, located in the store, and browse away.
387 S. MAIN STREET | 901-734-2911 | STOCKANDBELLE.MYSHOPIFY.COM

Walking through Palladio Antiques is half the fun of finding the perfect present. Whether it’s a nineteenth-century chest or a twentyfirst-century vase, you can stuff the stockings of your friends with something that might even increase in value. Palladio has something for everyone. And a bonus, as owner Cynthia Ham says, “It will put you in a festive mood. It’s an enchanting experience. Everywhere you look, it’s beautiful and stimulating. Unlike the big box stores.” 2215 CENTRAL | 901-276-3808 | INSTAGRAM.COM/ PALLADIOMEMPHIS

















and Dine

Upcoming events:







Holiday Open House … November 16
Girls Night Out … November 21 (shops open until 8:00pm)






Tree Lighting … November 26
Shop Small Business Saturday … November 30






Christmas in Collierville: November 30
December 7
December 14
December 21


Home Tour


December 14














































ABOUTUS TheAmericanHeartAssociation, foundedin1924,isthenation’slargest voluntaryorganizationfightingheart diseaseandstroke.IntheMid-South, theAHAworkstirelesslytoimprove cardiovascularhealththrough communityoutreach,education,and lifesavinginitiatives.Heartdisease remainstheleadingcauseofdeath globally,andstrokerankssecond.
Locally,theAHA'seffortshavemadea significantimpact,fromfundingcritical researchtopromotinghealthy lifestyles.Withover$5billioninvestedin research,theAHAisthelargest nonprofitfundingsourcefor cardiovascularresearchafterthe federalgovernment.





















BY SONO MOTOYAMA


espite being several minutes late, Marshall Bartlett lopes unhurriedly toward the wood-frame farm store, his lanky frame topped by wavy blond hair controlled under a baseball cap. e group of seven women — seniors from nearby Sardis with a few of their friends — watch him approach from the shaded porch.
His open and unpretentious manner quickly dissipates any impatience the women may have been feeling. In an employee’s absence, he explains, he has been filling in at his meat processing plant. When one of the women points to a stain on his knee, he says, “ at’s not my blood, but it is blood. It’s not human, though.” e ladies laugh.
They are here in Como, Mississippi, on a pleasant spring day to hear about life on the land that Bartlett and four previous generations of his family have worked for 150 years. And they will get more than they bargained for, with deep dives into industrial and regenerative agriculture, antibiotic-resistant bacteria, the nitrogen-trapping benefits of clover and water irrigation systems — along with the occasional folksy reference to characters like “my eccentric cousin Sherman. Y’all know Sherman?”
e group eats it up.
e farm, which today comprises about 1,800 acres, was always known as “the Home Place,” so Bartlett took the nickname as the official name of his business, Home Place Pastures. It was founded by Bartlett’s great-great-grandfather, Dr. Archibald Yarbrough, who later became a state senator. Yarbrough built the original farmhouse in 1875 after returning from the Civil War. e house burned down about 100 years later. Bartlett’s father, Mike, built the house where Marshall and his two older sibling grew up, across the road from the farm store.
“As a kid who loved to hunt and fish, I had the most idyllic childhood in the world,” Bartlett tells the Sardis group. “I loved this place

and still do. But the style of farming that Dad was engaged in was getting increasingly difficult.”
Bartlett had watched his father become more and more frustrated with the problems inherent in row-crop farming, an agricultural system by which crops such as cotton, corn, wheat or soy are planted in row upon row for efficiency. e choice of crops is made according to what can be sold on commodity markets.
e year begins with a trip to the bank to borrow money to fi nance labor and buy seeds and chemicals (fertilizer, herbicides) from agricultural giants like Bayer and Corteva. During growing season, farmers may contend with insect swarms and the whims of the weather. After the harvest, they must accept whatever price commodity markets assign to their yield, with no consideration for what they might have paid for inputs, or what droughts or infestations they might have endured.
“Dad’s model was very much similar to the previous generations,” he says. “It was all commodity agriculture — mostly cotton and corn.”
Glaringly absent from this process is any sort of self-determination. “You’re basically just doing all the work and making other people money,” Bartlett says.

And as writers like Michael Pollan and documentaries like Food, Inc. and Fast Food Nation have shown over the past several decades, none of this is good for human, animal, or environmental health.
Bartlett held a variety of jobs after graduating from Dartmouth College in 2011, but returned to his father’s farm in 2014 with a bold plan — to convert the family farm from row crops to raising grass-fed beef and pastured hogs.
But even more important to the transformation was Marshall Bartlett’s big bet: seizing control of the entire supply chain.

Alate summer visit to Bartlett’s childhood home reveals a brick house in a stand of oak trees. Meg and Mike Bartlett welcome a visitor into the cool, welcoming interior. In a sitting room adjacent to the kitchen, they recall their son Marshall’s childhood as one filled with outdoor activities and helping out on the farm.
“He always loved farming,” Meg Bartlett says. “He and his friend set up a hoop house to grow vegetables, and then they raised chickens.”
Even early on, he had a mind of his own.
“Marshall was a very assertive kid — more than the other two, I think,” his father says.
“And no matter what kind of adult figure was there, he was always willing to question,” Meg Bartlett says.
“Very true statement,” Mike confirms.
Of all his children, he says, “it’s surprising that an Ivy Leaguer comes back and farms.”
Before returning to farming, though, Bartlett made a brief pass at politics, running in a special election for state representative in 2013. He came in third of four candidates in that race.
Outside of politics, however, his passion did manage to persuade others to his point of view.
John Jordan Proctor, today vice president of Home Place Pastures, grew up on a farm in Glen Allan, Mississippi, and watched his father, as Bartlett watched his, take out yearly loans only to end up in a “crippled financial state,” he says.
Proctor wanted to return to farming but viewed the chemical-dependent monoculture methods of row-crop farming as problematic.
“It just did not appeal to me, applying tons of pesticides, applying tons of herbicide, just the monotony of one plant, just corn,” he says.
One of his professors at the University of Mississippi suggested he meet Bartlett.
“We joke about it now, but when I met Marshall, I





For the holidays, Bartlett says that show pieces like the STANDING RIB ROAST and WHOLE BEEF TENDERLOINS are popular. He personally recommends SPIRAL- CUT HOLIDAY HAM, which is prepared so slices are easy to pull off.
“It’s great to have in the fridge to graze on if you’re having family and friends over at the holidays,” he says. All can be ordered on the website.
Home Place can customize corporate gifts to fit any budget, which it will ship to order; email info@ homeplacepastures.com for more information. It also composes “curated” boxes. THE HOME PLACE GIFT PACK , for example, includes pork chops, sausage, steak, bacon, smoked sausage and ground beef for $129; a gift card can be included.
For the incorrigible carnivore on your gift list, Home Place offers SUBSCRIPTION BOXES at different price points and frequencies, from every month to every three months. You can also compose your own À LA CARTE order of any Home Place products. Most economical is its ANIMAL SHARE PROGRAM, which allows you to buy portions or an entire animal (pickup only). The deadline for Christmas orders is December 15.
Products and recipes are available on the Home Place Pastures website, homplacepastures.com. Check the site and the Instagram page (@homeplacepastures) for special events with chefs, or to book a farm tour or farm stay.
was just like, No, I’m not working for this guy,” Proctor remembers. He viewed Bartlett as an Ivy League elite who did not have realistic ideas about farming. Yet his professor convinced Proctor to meet with Bartlett a second time and tour Home Place.
“When I pulled up, he was fixing a water line,” Proctor says. “He was doing something practical, and I was like, Oh, maybe he does know something.”

Home Place foregoes antibiotics, hormones, and feedlots for the animals.
at afternoon, Bartlett made his pitch about what he wanted to accomplish with Home Place Pastures.
“ en I got really excited to work with him for the summer, just to see what he was up to,” says Proctor (who also serves as the head pitmaster of the Sweet Cheeks barbecue team that annually participates in Memphis barbecue competitions). He began as the farm’s first summer intern in 2014. Bartlett hired him after his graduation the following year, and he’s been there ever since.
Looking back wryly at his younger self, Bartlett recalls the period, after his short-lived foray into politics, when he was establishing Home Place Pastures.


“At the tender age of 24, I thought I had it all figured out,” he says. ough he was not elected as a politician, he felt he could achieve the same goal of helping the community by creating a thriving agricultural practice.
After graduating from college, he had worked as chief of operations for a New Orleans meat supplier. He recognized an avid market among chefs for local products. And he had been inspired by regenerative farmers like Joel Salatin of Polyface Farm in Swoope, Virginia (featured in Food, Inc.),



and, particularly, Will Harris of White Oak Pastures in Bluffton, Georgia, whom he now regards as a mentor.
Harris is a leading light in the regenerative agriculture movement, a holistic approach to farming that seeks to improve or restore soil degraded by the intensive industrial methods that dominate the American food economy. He sees the health of the community as linked to the health of the soil. After spending 20 years as an industrial rancher, Harris reversed his methods. He began to forego antibiotics, hormones, and feedlots for his animals, and eschewed pesticides and herbicides for his

Cuts of meat are available individually or as part of a farm-share program.
land. He began to grow a diversity of mutually beneficial species. Instead of shipping his cattle hundreds of miles to a slaughterhouse, he invested millions in building meat-processing facilities on his own property.
“Today we don’t feed animals, we feed the microbes in the soil,” he says in a short documentary about his practices. “ e microbes feed the soil, and the soil feeds the plants, and the plants feed the animals.”
Bartlett visited White Oak Pastures in 2017. In a recent phone conversation, Harris recalled the fi rst time Bartlett came there, when they toured the farm, discussed livestock production and land management, but also “the recovery of our little rural town of Bluffton, Georgia,” an impoverished area that was gutted as people found it impossible to make a living in farming. He has kept in touch with Bartlett regularly over the years.
Harris’ first impression of Bartlett was of a bright young man, with “a lot of energy, who apparently thought very deeply about things.”
Bartlett is currently on a path that Harris himself traveled, Harris says.
When he visited White Oak, Bartlett knew Harris’ story, but actually exploring the farm was “kind of the holy grail,” Bartlett says.
“For the regenerative ag, vertically inte-

We salute the professional advisors who understand the value of giving through a charitable fund, now and in the future.
Ben C. Adams, Jr.
Baker Donelson
C. Michael Adams, Jr. Evans Petree PC
Sudhir K. Agrawal Ami Financial Group
Daniel Allen Red Door Wealth Management
Kelly L. Bolton Merrill Lynch
Larry H. Bryan Diversified Trust
Thomas R. Buckner
Apperson Crump PLC
G. Rice Byars, Jr. Harris Shelton
Susan Callison Harris Shelton
Frank N. Stockdale
Carney Evans Petree PC
Kenneth F. Clark, Jr. Retired
James S. Dickey, Jr.
The Marston Group PLC
V. Lynn Evans V. Lynn Evans CPA
Katina H. Gaines
Gaines & Associates PLLC
Robert D. Gooch III
Raymond James & Associates, Inc.
Perry J. Green
Waddell & Associates Wealth Strategists
Jay Healy
Beacon Pointe Advisors
Robert S. Hester, Jr. Retired
William B. Howard, Jr.
William Howard & Co. Financial Advisors, Inc.
J. Kenneth Marston, Jr.
The Marston Group PLC
Michael L. Matthews UBS Financial Services, Inc.
William T. Mays, Jr. Glankler Brown PLLC
A. Stephen McDaniel
Williams McDaniel
Kenneth A. Milford Milford & Associates PC
John F. Murrah
Evans Petree PC
George J. Nassar, Jr. Glankler Brown PLLC
Robert E. Orians
Martin, Tate, Morrow & Marston PC
Michael R. Parham Parham Estate Law
Hallie L. Peyton Legacy Wealth Management
John Phillips V Red Door Wealth Management
R. Michael Potter Retired
J. Martin Regan, Jr. Lewis Thomason
Michael A. Robinson
Glankler Brown PLLC
To help your clients achieve more through philanthropy at the Community Foundation, contact Philanthropic Advisor
Jim Marconi at (901) 722-0037
M. Andrew Shaul
Creative Planning
Robert Smithwick III Diversified Trust
Jeffrey E. Thompson
Martin, Tate, Morrow & Marston PC
N. Gordon Thompson TD Capital Management LLC
John W. Ueleke Retired
Michael D. Uiberall Retired
Harish V. Vishria Vishria Bird Financial Group LLC
Steven Wishnia Highland Capital Management LLC
James D. Witherington, Jr. SSM Partners


grated movement, White Oak represents a success story for a lot of us,” Bartlett says, referring to farms that simultaneously produce, process and market agricultural products. “They were able to take this generational farm and totally transition it into something else in a very big, bold way.”
White Oak is also financially profitable. Girded by his inspirations, Bartlett had confirmation that he could reach a niche market of people who wanted naturally raised pigs and cattle — that was his customer base. Then there were farmers who were telling him they wanted an alternative to the exploitational commodity agriculture merrygo-round — they were his producers.
The key was to connect farmers to consumers directly, without going through the commodity market. In other words, the key was the modern structure visible from the farm store: a $4 million processing plant — needed because consumers don’t want to purchase a whole cow. “You want to come out here and buy a steak,” he says.
Bartlett now allows that constructing the plant, one of the few farm-based slaughtering facilities in the country, was “an incredibly ambitious plan” for a young entrepreneur. He received grants from the state and federal governments, but also had to go, hat in hand, like his father before him, to the bank for loans.
Memphis is published monthly. Annual subscription $18. Publisher/Editor Anna Traverse. Managing Editor: Frank Murtaugh. Memphis is owned by Contemporary Media, Inc., P.O. Box 1738 Memphis, TN 38101. Stockholders: Ward Archer Jr., 1902 Nelson, Memphis, TN 38114; Jack Belz, 100 Peabody Pl. #1400, Memphis, TN 38103; Kate Gooch, 177 N Highland, #4206, Memphis, TN 38111; Josh Lipman, P.O. Box 45, Memphis, TN 38101; Gustave Lipman, Ira A. Lipman Estate, 781 Fifth Ave., 17th Floor, New York, NY 10022; Benjamin Lipman, Guardsmark Holdings, 651 OakLeaf Lane, Memphis, TN 38117; Henry Turley Jr., 65 Union Ave., 12th Floor, Memphis, TN 38103.
AVERAGE NUMBER COPIES EACH ISSUE DURING PRECEDING 12 MONTHS: Net press run - 16,161. Paid outside county mail subscriptions - 2,631. Paid inside county mail subscriptions - 10,146. Sales through dealers, carriers, street vendors, counter sales and other Non-USPS paid distribution - 357. Other classes mailed through the USPS - 0. Total paid distribution - 13,134. Free or Nominal rate outside-county copies - 385. Free or Nominal rate inside-county copies - 1,406. Free or Nominal rate copies mailed at other classes through the USPS - 0. Free or Nominal rate distribution outside the mail - 795. Total Free or Nominal distribution - 2,586. Total distribution - 15,718. Copies not distributed - 443.
ACTUAL NUMBER COPIES SINGLE ISSUE NEAREST TO FILING DATE: Net press run - 17,740. Paid outside county mail subscriptions - 3,029. Paid inside county mail subscriptions11,229. Sales through dealers, carriers, street vendors, counter sales and other Non-USPS paid distribution - 793. Other classes mailed through the USPS - 0. Total paid distribution - 15,051. Free or Nominal rate outside-county copies - 379. Free or Nominal rate inside-county copies - 1,426. Free or Nominal rate copies mailed at other classes through the USPS - 0. Free or Nominal rate distribution outside the mail - 795. Total Free or Nominal distribution - 2,600. Total distribution - 17,651. Copies not distributed - 89.




















Well-known animal behaviorist Temple Grandin consulted on the design of the plant to help minimize stress for the animals. But Bartlett’s father was instrumental in getting the initial building constructed.
“He is an incredible builder,” Proctor says. “I’ve never met anyone like him. He built most of the plant, most all of it.”
Mike Bartlett is more modest in the estimation of his contribution.
“We got this thick sheath of paperwork from the United States Department of Agriculture giving us guidelines,” he says. “And I took them seriously.”

Home Place endeavors to use all parts of the animal to minimize waste and maximize sustainability.
e original building began its USDA-inspected meat processing in 2016, with the slaughterhouse opening in 2018. Home Place completed a $2.5 million expansion of the plant in November 2023.
“We should have built it bigger in the first place,” Mike Bartlett says, “but we didn’t know what we were getting into.”














With the plant built, Home Place has been recruiting farmers who are willing to raise animals naturally in exchange for premium prices over commodity-market prices. Bartlett admits that his farm makes up a minuscule portion of the livestock industry in this country. (He manages about 300 acres; part of the farm is rented to other farmers; and 680 acres were recently put in a conservation easement and planted with 290,000 trees.)
Yet by giving farmers an incentive — and the local economic infrastructure — to raise and sell their livestock in the region, “we’ve really made a big impact on our local producers,” Bartlett says.


When an emergency changesyour plans, plan to get great care. Our experienced teams are readyfor emergencies at any time. With online check-in,you can let us know that you’re onyourway. For life-threatening emergencies, call 911









PRESENTED BY


In addition to a dozen farming partners, Home Place itself employees 26 people, with $1 million in annual payroll going back into the local economy.
“Instead of shipping all this stuff up to the Midwest,” he says, referring to industrial slaughterhouses, “and letting Tyson take it all, we’re keeping a little bit of that value here.”
As it establishes the early stages of its farmers-to-slaughterhouse-to-consumer supply chain, Home Place is simultaneously developing its direct-to-consumer channels. Its meat is sold in Memphis at Buster’s Butcher, the Cooper-Young farmer’s market, and South Point Grocery. Local chefs, like Lobbyist chef-owner Jimmy Gentry and Kinfolk’s Cole Jeanes, feature Home Place products on their menus, and vaunt their taste and appearance.
The fact that Home Place animals are “roaming and eating freely, and no antibiotics, that plays a huge role in why the meat tastes different,” says Jeanes. “It’s so nutrient-dense.” e provenance of the meat is also ethically appealing. e fact that Home Place livestock is grown responsibly “is a huge thing for me and our mission at Kinfolk,” Jeanes says. “We say we want to tend to the garden nearest us.”
While chefs are an important part of Home Place’s market, its e-commerce business is essential to growing its business nationally. e trick is to offer a product consumers want at a price point they are willing to pay.
“Everyone’s like, why are you out of filets?” Bartlett says. “We all love filets and we’re used to just getting box meat from industry.” When he tries to explain to customers that Home Place tries to harvest all parts of the animal, “their eyes just glaze over.”
“You’re tempted to sell your principles short because of consumer demand and price sensitivity,” he says. “But the minute I start doing that, I’m going to stop getting out of bed in the morning because the only thing that keeps me going is I’m fired up by what I do.”
But the need to economize and eliminate waste is not lost on the group from Sardis.
“What’s amazing to me is to think back to my grandparents who had a farm near Bruce, Mississippi. Basically, they were doing exactly what you’re doing,” one woman says.
NOVEMBER 23 - 24
“Exactly,” Bartlettt says. “Will Harris calls it radically traditional farming.” Before the introduction of what Bartlett calls “synthetic inputs,” farmers would rotate the pasturing of livestock, for example, because it was effective for the health of the animals and the soil.
The ethos of frugality “formed this identity of rural living that we have,” Bartlett continues. “It’s really tragic that in our rural communities now, you can’t find pig’s feet or fatback. … Our goal is the same as your ancestors. We want to sell every single piece of that animal from nose to tail.”
At Baptist Women’s Health Center, we’re taking breast care to a whole new level.
• Our highly trained, all-female clinical staff and board-certified breast radiologists specialize in delivering leading-edge, compassionate care.
• Now offering contrast enhanced mammography, another tool in the fight against breast cancer that uses iodine-based dye to help detect breast cancers early.
Learn more about our services at baptistonline.org using the QR code or call 901-226-0810 for an appointment.


baptistpink.com

David Lusk and Carissa Hussong’s art-filled home is a Memphis treasure.
BY CHRIS M C COY ■ PHOTOGRAPHS BY JOHN PICKLE


H e owns and runs an art gallery; she leads a pioneering art museum. We were curious about the art and design choices the two have made in the home they share — and we weren’t disappointed.
David Lusk has run his eponymous art gallery for almost three decades. After starting in Memphis in 1995, selling the work of local and regional artists to an ever-expanding list of clients, he expanded to Nashville, where his reach has grown.
Carissa Hussong is executive director of the Metal Museum, one of only a handful of museums in the world which focus on metalsmithing. Under her watch, this Memphis institution has expanded its programming and visibility. They are currently embarked on their biggest expansion of all — taking over Rust Hall, the former Memphis College of Art building in Overton Park. When complete, the renovated facility will feature greatly expanded gallery space and more accessibility to the community. The $25 million project is on pace to open in 2025.
“It’s a great building. It has really good bones,” Hussong
says. “It’ll be really nice to see all of those spaces opened up again, because they covered windows and cut up all of these rooms. If you’d ever been in the ground floor of the building, it was kind of crazy, just a maze of spaces.”
After years of planning and fundraising, renovation work has begun in earnest. “They just started [asbestos] abatement,” Hussong says, “so really, you won’t see much happening on the outside until November, when they start taking down the additions.”
Lusk was raised in Missouri and moved to Memphis to attend Rhodes College; he has lived here ever since. Hussong grew up in Honolulu. “My father went to the university. He got his Ph.D. there, and then stayed,” she says. “My mother’s a harpist.”
She says her interest in art was stimulated by her grandmother. “She collected abstract expressionism and it was a pretty important collection in Seattle.”
The couple met in Seattle in the early 1990s. “I was actually interning — that was my first year at Art Fair Seattle. He was exhibiting with Lisa Kurts Gallery. And then the following year, we started dating,” says Hussong.
Upstairs in their Midtown home is a painting by artist Mary Sims depicting a radiant Hussong in her wedding dress. On the ground is an old-fashioned diving helmet with an air hose reaching up and out of the frame. The effect is a little disorienting: Hussong seems to be getting married at the bottom of the sea. That’s

left: Gallery owner David Lusk and Metal Museum executive director Carissa Hussong are a Memphis art scene power couple. Their Midtown home is full of impressive artwork. above: The homeowners love the work of the late Mary Sims, an artist based in Eureka Springs, Arkansas, who taught painting and printmaking at Rhodes College. This huge canvas, based on the biblical story of David and Bathsheba, hangs in their upstairs TV room.

just one of the many moments of serendipity and wonder to be found in their art-filled home.
After they married, Lusk and Hussong lived in a cozy starter house. “We were in Central Gardens before and needed a bigger house than we had there,” says Lusk.
When they were contemplating expanding their family, they started to think about what kind of place they would want to live with their children. “We had been at Thanksgiving dinner, and I said to my sister-in-law that I wanted a four-bedroom house with a guest
house, and just kind of laughed it off, thinking we would never be able to find it or afford it,” Hussong recalls. “But here we are.”
Space for their ever-growing art collection was a top priority.
“We looked at a lot of houses and knew that we needed at least five walls to display art, or somewhere close to that. That was item number one,” says Lusk.
After much deliberation, they settled on a 1912 vintage Arts and Crafts house in a quiet corner of Midtown. “It’s a solid neighborhood,” says Lusk. “It’s diverse, and that certainly appealed to both of us when we
were looking for neighborhoods.”
The home was in good shape. “The interior woodwork had not been messed up or ever painted, so that was good. The outside had been tuckpointed. Somebody took good care of it in the ’80s. And then we added new lighting and more cosmetic things.”
They finished part of the attic and made it into a bedroom, but the biggest change in the main house was to the kitchen. “The kitchen was three separate little areas. It hadn’t been touched since the ’50s,” says Lusk.
The new owners tore down the walls to create a more
modern, practical space. “We moved it all around. It had been a service kitchen. It was a different kind of practicality from the 1920s,” says Hussong.
The backyard was dominated by a long concrete slab — someone who lived here in the past had been a fan of shuffleboard. They removed the concrete and planted grass and moss between paving stones. The biggest improvement they made to the property was to the carriage house, which had been a bare-bones affair. “It didn’t even have stairs!” says Hussong.
“The guest house had two rooms,” says Lusk. “It didn’t




top: Another Mary Sims painting, Ship of Fools, dominates one wall of the living room.
above left: Tad Lauritzen Wright’s The Philosophy of Beauty, based on a word-finder puzzle, hangs over the fireplace. above right: This periodic table entry is by metal artist Gary Griffin, who cast the chemical symbols (Au is gold) for every material he has used over the years.
have water when we got the house, so we added a bathroom up there, and a kitchen.”
The couple have found the guest house to be an invaluable addition, especially while the couples’ two daughters, Grayson and Phoebe, were still living at home. It allowed the family to have guests for an extended period without feeling crowded. “We’ve had artists stay there for weeks, and we barely see them. So that works nicely.”
“It’s perfect for us when we have















a bunch of relatives and artists in town all the time, but not all under the same roof,” says Lusk.
Over the years, as their daughters grew up and then moved out on their own, the couple continued to tweak the space to their liking.
“We’d flip these rooms, so the dining room became the living room for a while,” says Lusk.
The couple furnished the home themselves, with a little help. “We have a lot of design friends,” says Lusk, most notably Grace Megel,
whom the couple singled out for her help making everything fit just right.
Hussong believes the home’s flowing spaces and well-designed traffic areas helped bring the overall aesthetic into focus. “One thing I would say about this house: I think it’s really worked having a blend of old family pieces, and also contemporary pieces. It’s felt very natural and comfortable, being able to combine all of those things, which I don’t think works in every house.”
But the thing that really sets Lusk and Hussong’s home apart is, of course, the art.
Over the living room fireplace is a painting by Tad Lauritzen Wright called The Philosophy of Beauty It is not a portrait or landscape, as you might expect from the title. Instead, it is a giant grid with letters in each square, in the familiar style of a word-finder puzzle. Gaze at it for a moment and words and phrases start to jump out at you: “Hot as a two-dollar pistol,” “God’s handwriting,” “Store complexion.”
“When you look at it, you’re
playing the game,” says Lusk. “That’s always been the crux of Tad’s practice for almost 30 years: That people would spend a little more time with it than perhaps an abstract painting.”
Lusk and Hussong’s art collection, which fills their home’s ample wall space, is vast and varied. It encompasses sculpture, painting, abstraction, and realism. There’s an early piece from Memphis minimalist Terri Jones, consisting of a glass jar mounted on a wall. At first glance, it appears to be an ordinary vessel, but when you look at the shadow cast by the ceiling-mounted spotlight, a single word appears: “remember.”
Lighting, Lusk says, is a crucial consideration when hanging art in your home. Accent lights for wall-mounted paintings should be at an angle, not just beaming straight down from the ceiling. “It should be at least 30 inches away from the wall,” says Lusk. “A lot of times they can’t do that, or the fixtures are way too close to the wall, so it does light it, but it doesn’t flood it.”
The effect of changing lighting

left: An early work by Memphis minimalist Terri Jones projects “remember” on the wall. below: The large canvas in the dining room by Memphis artist Jared Small combines photorealistic imagery with smeared and dripping paint to represent the memory of a lost Midtown Victorian house.

right: At the top of the home’s Arts and Crafts staircase is a treelike sculpture by master metalsmith Kim Crider. The portrait on the facing wall by Paul Stephen Benjamin changes dramatically, depending on the lighting.
below: The 1912 home’s dark wood accents had never been painted, retaining their luster over the years. The painting on the left is an early work by Memphian Pinkney Herbert; the smiley face on the right is by Everett Hoffman.


conditions on a hanging painting is dramatically illustrated by a large portrait by Paul Stephen Benjamin hanging in the stairwell. When it’s well-lit, the exquisitely rendered dark-skinned figure stares back at the viewer. But dim the light, Hussong says, “and he just disappears.”
The late Mary Sims was a special favorite of the couple. Based in
Eureka Springs, she favored huge canvases stuffed with full-length human figures in strange and startling poses. Hussong says the artist would persuade her friends to dress up in costumes which looked like they had been grabbed randomly from a thrift store, and use the photographs for inspiration.
Ship of Fools, the giant Sims painting in the living room, is a riot

of color and form. It dates from the late 1970s. Upstairs is another Sims work, similarly sizable, which was inspired by the biblical story of David and Bathsheba. While Lusk and Hussong regularly rotate pieces in their home, the massive Sims paintings stay anchored. And the paintings are not the only memory they have of their painter friend. Two vinyl
chairs in the living room came from Sims’ Eureka Springs kitchen.
Another large canvas is easily mistaken for an altered photograph. It depicts a Victorian house with a distinctive circular balcony railing that once stood on Vance Avenue in Midtown. The center of the image is in sharp, lifelike focus, while the edges drip like spilled paint.
“Jared Small had painted that house several times,” says Hussong. “Then one day, I was driving by and it was on fire. It went really quickly. Right after I drove by, I called Jared to tell him that it was burning. He painted this afterwards. It’s sort of a memory of the house.”
The collection’s metal artwork shows the full subtlety and variation possible with the medium. Blink and you’ll miss some of the sculpture, such as the airplane-like form hanging from the ceiling in the kitchen, crafted by blacksmith Elizabeth Brim. “It’s an inflated piece,” says Hussong. “So it’s almost like you would sew a pillow. You weld all the edges together and leave a hole. Then you heat it up and blow hot air into it, and it’ll puff up.”
Nearby is a fun piece resembling a light-up smiley face. “That’s by Everett Hoffman. It was in a recent exhibition



[at the Metal Museum.]. He’s an up-andcoming, hot metalsmith right now.”
In the foyer on a glass table is a kinetic sculpture by Brent Kington. “He’s considered one of the key figures in bringing blacksmithing to contemporary art,” says Hussong.
Farther up the stairs is one of the home’s most striking pieces, resembling a tree, bisected vertically to expose the wood grain — except it’s made entirely of polished metal. The artist, Kim Cridler, was master metalsmith at the Metal Museum two years ago. Hussong recalls a reception held here at home where the assembled metalworkers gathered on the staircase landing to ooh and ahh at the gleaming tree.

Memphis has always made a place for eccentrics, artists, and eccentric artists. This particular home has hosted many of the most talented people to pass through the Bluff City. “Covid sort of curbed some of the dinners and parties that we had more frequently before. But we still sit in our living room with guests,” says Hussong.

Much of the home’s art are reminders of past exhibitions, or, like the six-foot light-up mermaid in the backyard, thankyou gifts. “That was from Starry Nights, their first iteration,” says Lusk. “I did a favor for MIFA and they gave me that.”
The couple’s love for Memphis’ unique culture remains undimmed. “You know, all the cool people just accidentally find their way here,” says Lusk.
“Yep,” says Hussong. “And they remain.”






friendships bring new joys!

Some seniors think the days of making new friends are behind them, but our communities offer plenty of opportunities to form genuine connections with likeminded individuals — who share a love for the King of Rock n’ Roll!
Did you know a full social life is associated with improved longevity? It’s true! Seniors who socialize nearly every day experience up to an 87% longer delay in time to death compared to those who never socialize.
Call today to learn more about life with us.
StoryPoint Collierville 901-403-8602
691 S. Byhalia Road Collierville, TN 38017
StoryPoint Cordova 901-329-8015 1600 Appling Road Cordova, TN 38106
StoryPoint Germantown 901-617-7938
6300 Briarcrest Ave. Memphis, TN 38120
StoryPoint.com





















Paul Chandler and GPAC have a long history together.
BY BRUCE VANWYNGARDEN

Thirty years ago this month — November 19, 1994 — Ray Charles became the fi rst artist to take the stage at the then-new Germantown Performing Arts Center. A poster advertising the event still graces the venue’s box office, and a photograph of Charles hangs in GPAC executive director Paul Chandler’s office.
Chandler’s history with GPAC goes back a long way. He was in his mid-twenties and GPAC’s assistant director when Ray Charles played. He spent the rest of the 1990s in that role, helping the nascent facility find its bearings in its early days.
“Back then,” says Chandler, “people used to talk about the ‘wall’ at the border between Germantown and Memphis. I used to tell my friends in Memphis, ‘ ere are only two cool things in Germantown: Bosco’s and GPAC.’ It’s obviously not that way any longer and I feel like GPAC played a big part in helping the wall disappear.”







Programming was eclectic in the early years. Season One featured such acts as classical guitarist Christopher Parkening, the American Indian Dance Theatre, the Vienna Boys’ Choir, the off-Broadway musical revue Forever Plaid, and violin maestro Itzhak Perlman. These days the season lineups are still varied, but GPAC has grown and matured over three decades. The headliners are bigger and the diversity and scope of its programming have expanded dramatically. “Find Your Center” is the organization’s marketing slogan, and GPAC has done just that — finding a successful sweet spot in the Memphis area’s entertainment offerings.
That success in no small measure is the result of Chandler. He’s been executive director since 2012, but it’s his third stint with GPAC. He initially left the organization in 2001 to help form the Resource Entertainment Group, where he helped create the still-thriving Live at the Garden concert series at Memphis Botanic Garden. Chandler returned to GPAC as interim director for the 2004 and 2005 seasons, before returning again for good as executive director seven seasons later.
“When I arrived in 2012, the place was in good order,”











Chandler says. “It had a solid jazz audience, and the Iris Orchestra, which was founded here, was also in a good place. Classical music and jazz were very strong. Through an association I’d developed with a producer in New York, I was able to bring in Lyle Lovett my first year back and people were like, ‘Is he country? Who is he?’ He’s a poet, and a remarkable performer.”
Chandler remembers that show as “a sophisticated act. We sold out instantly and it brought out a lot of Memphians who had never been to this space. We got their attention. And we got the attention of Duncan Williams Asset Management, which gave
us financial support that lasted 11 years and helped us bring in acts this organization couldn’t before.”
The number of acts and activities happening under the aegis of GPAC expanded dramatically again with the 2020 opening of The Grove, the organization’s grand outdoor facility. As readers may recall, 2020 was not a great year to open anything, least of all a performing-arts venue.
“I was sitting in my office in an empty building, on Zoom with contractors all day long,” Chandler remembers. “When The Grove was ready in June, the Shelby County Health Department gave us approval to have outdoor

events for 10 people! So we invited board members and their families to come. We had this great outdoor space and a giant video wall, so we could show movies and concert films and not have to pay bands.”
The number of people allowed to attend slowly increased. “By August,” he says, “the health department said we could have 125 people, so we started having shows five nights a week — anything to stay open, to keep people working, to stay relevant during the pandemic. I like to say that The Grove saved us.”
This season, GPAC has a new principal funder: Highland Capital Management. “Highland Capital has pledged more than $100,000 per year for five years,” says Chandler. “It’s the largest annual contribution in the history of the organization. We’re very grateful.”

And Chandler is grateful to have found a career and a life that suits him. He and his wife, Jennifer Chandler — the food editor for The Daily Memphian — have two daughters, Hannah and Sarah. He is an avid fly-fisherman, a gardener, an amateur chef — and a thoughtful man.
“It was about 10 years ago that I started becoming more self-aware,” he says. “It started with someone saying to me, ‘You’re an empathic person.’ I looked it up and it means I have an ability to sense how someone is feeling, no matter what they’re saying. I realized that during a performance I spend more time and attention observing and listening to the audience rather than what’s on-stage. I’m listening for moments when they hold their breath, when the performance has moved them. I’m reading the energy from the audience.
“I came to realize that I’m not really an arts guy. I love music but I’m not an audiophile with a big vinyl collection. I’m a producer. I like being responsible for helping to create something that people enjoy. I like it when people around me are happy. That’s who I am.”
Spoken like a man who’s found his center.
For a complete schedule of upcoming events, go to gpacweb.com





These days, it takes a village to manage your nancial world. Whether it is managing your assets with a wealth manager, navigating the ever-changing tax landscape, sorting out your estate and succession planning or picking the right life insurance, nding the right team can be a daunting task. In fact, many consumers have a hard time guring out where to even begin.
Sometimes, a few simple questions can put you o on the right path. Asking a professional what makes working with them a unique experience can help you understand how they work and if their style meshes with your own. This is a great place to start! Five Star Professional uses its own proprietary research methodology to name outstanding professionals, then works with publications such as Memphis magazine to spread the word about award winners. Each award candidate undergoes a thorough research process (detailed here) before being considered for the nal list of award winners. For the complete list of winners, go to www. vestarprofessional.com.
In order to consider a broad population of high-quality wealth managers and investment professionals, award candidates are identified by one of three sources: firm nomination, peer nomination or prequalification based on industry standing. Self-nominations are not accepted. Memphis-area award candidates were identified using internal and external research data. Candidates do not pay a fee to be considered or placed on the final lists of Five Star Wealth Managers or Five Star Investment Professionals.
• The Five Star award is not indicative of a professional’s future performance.
• Wealth managers may or may not use discretion in their practice and therefore may not manage their clients’ assets.
• The inclusion of a professional on the Five Star Wealth Manager list or the Five Star Investment Professional list should not be construed as an endorsement of the professional by Five Star Professional or Memphis magazine.
• Working with a Five Star Wealth Manager, Five Star Investment Professional or any professional is no guarantee as to future investment success, nor is there any guarantee that the selected professionals will be awarded this accomplishment by Five Star Professional in the future.
• Five Star Professional is not an advisory firm and the content of this article should not be considered financial advice. For more information on the Five Star Wealth Manager or Five Star Investment Professional award programs, research and selection criteria, go to fivestarprofessional.com/research.
DETERMINATION OF AWARD WINNERS CRITERIA
Award candidates who satisfied 10 objective eligibility and evaluation criteria were named 2024 Five Star Wealth Managers. 1. Credentialed as a registered investment adviser or a registered investment adviser representative. 2. Actively employed as a credentialed professional in the financial services industry for a minimum of five years. 3. Favorable regulatory and complaint history review. 4. Fulfilled their firm review based on internal firm standards. 5. Accepting new clients. Evaluation Criteria – Considered: 6. One-year client retention rate. 7. Five-year client retention rate. 8. Non-institutional discretionary and/or non-discretionary client assets administered. 9. Number of client households served. 10. Education and professional designations. 600 award candidates in the Memphis area were considered for the Five Star Wealth Manager award. 54 (approximately 9% of the award candidates) were named 2024 Five Star Wealth Managers.
DETERMINATION OF AWARD WINNERS CRITERIA
The investment professional award goes to estate planning attorneys, insurance agents and select others in the financial industry. Required: 1. Credentialed with appropriate state or industry licensures. 2. Actively employed as a credentialed professional in the financial services industry for a minimum of five years. 3. Favorable regulatory and complaint history review. 4. Accepting new clients. Evaluation Criteria – Considered: retention rate. 6. Five-year client retention rate. 7. Number of client households served. 8. Recent personal production and performance (industry specific criteria). 9. Education and professional designations/industry and board certifications. 10. Pro Bono and community service work. This year, we honored 1 Memphis-area investment professionals with the Five Star Investment Professional award.
All award winners are listed in this publication.
Financial Planning
William B. Howard Jr.
William Howard & Co. Financial Advisors, Inc.
Kevin Dale Kimery
Kimery Wealth Management
Kent C. Mathis
Wells Fargo Advisors Page 3
Investments
Staci L. Jackson
Strategic Advisory Services, LLC
Hulon O. Warlick
Independent Wealth Management, LLC Page 4
Jim Whitehead
Ameriprise Financial Services, LLC/Crown Financial Group Page 2

This award was issued on 10/01/2024 by Five Star Professional (FSP) for the time period 01/09/2024 through 08/09/2024. Fee paid for use of marketing materials. Self-completed questionnaire award; 54 (9% of candidates) were named 2024 Five Star Wealth Managers. The following prior year statistics use this format: YEAR: # Considered, # Winners, % of candidates, Issued Date, 1/20/20 - 8/21/20; 2019: 544, 54, 10%, 10/1/19, 1/28/19 - 8/16/19; 2018: 548, 69, 13%, 10/1/18, 2/6/18 - 8/27/18; 2017: 400, 52, 13%, 10/1/17, 2/6/17 - 8/28/17; 2016: 447, 105, 2012: 695, 166, 24%, 10/1/12, 3/30/11 - 8/19/11.
Wealth managers do not pay a fee to be considered or placed on the final list of Five Star Wealth Managers. The award is based on 10 objective criteria. Eligibility criteria – required: 1. Credentialed as a registered investment adviser (RIA) or a registered investment adviser resulted in a license being suspended or revoked, or payment of a fine; B. Had more than a total of three settled or pending complaints filed against them and/or a total of five settled, pending, dismissed or denied complaints with any regulatory authority or FSP’s consumer C. Individually contributed to a financial settlement of a customer complaint; D. Filed for personal bankruptcy within the past 11 years; E. Been terminated from a financial services firm within the past 11 years; F. Been convicted of a felony); 4. Fulfilled their firm review served; 10. Education and professional designations. FSP does not evaluate quality of services provided to clients. The award is not indicative of the wealth manager’s future performance. Wealth managers may or may not use discretion in their practice and therefore may no guarantee as to future investment success, nor is there any guarantee that the selected wealth managers will be awarded this accomplishment by FSP in the future. Visit www.fivestarprofessional.com. This year we honored 1 Memphis-area investment professional

WINNER


Jim has more than 30 years of experience serving customers and the local community. His philosophy is to work with honesty and integrity every day and to o er exceptional customer service. He pays close attention to each client’s speci c situation, listens to their needs, works closely with them and makes it his goal to forge lifelong relationships. The complexity of the current nancial marketplace makes it more important than ever to have a balanced approach to investing, risk management, tax planning and wealth management, guided by expert counsel and experience. Jim believes in a proactive approach to wealth management to minimize risks and provide greater opportunities.
Crown Financial Group is a destination practice that is passionate about enabling clients and associates to de ne and achieve their nancial goals and dreams while building relationships that last a lifetime.

1052 Brookfield Road • Memphis, TN 38119 Phone: 901-682-5757
jim.whitehead@ampf.com www.ameripriseadvisors.com/jim.whitehead
Investment products are not insured by the FDIC, NCUA or any federal agency, are not deposits or obligations of, or guaranteed by any financial institution, and involve investment risks including possible loss of principal and fluctuation in value. Investors should conduct their own evaluation of a financial professional as working with a financial advisor is not a guarantee of future financial success. Ameriprise Financial Services, LLC. Member FINRA and SIPC.
STAR WEALTH MANAGER AWARD WINNER
was used for rating. This rating is not related to the quality of the investment advice and based solely on the disclosed criteria. 600 Memphis-area wealth managers were considered for the Research Period. 2023: 542, 51, 9%, 10/1/23, 1/9/23 - 7/31/23; 2022: 489, 46, 9%, 10/1/22, 1/31/22 - 8/5/22; 2021: 548, 50, 9%, 10/1/21, 1/11/21 - 8/13/21; 2020: 542, 42, 8%, 10/1/20, 23%, 9/1/16, 3/30/16 - 8/24/16; 2015: 690, 143, 21%, 10/1/15, 3/30/15 - 8/19/15; 2014: 1,034, 152, 15%, 10/1/14, 3/30/13 - 8/19/13; 2013: 880, 166, 19%, 10/1/13, 3/30/12 - 8/19/12; representative; 2. Actively
through FSP’s consumer complaint process; feedback may not be representative of any one client’s experience; based on internal standards; 5. Accepting new clients. Evaluation criteria – considered: 6. One-year client retention rate; 7. Five-year client retention rate; 8. Non-institutional discretionary and/or non-discretionary client assets administered; 9. Number of client households not manage their clients’ assets. The inclusion of a wealth manager on the Five Star Wealth Manager list should not be construed as an endorsement of the wealth manager by FSP or this publication. Working with a Five Star Wealth Manager or any wealth manager is with the Five Star Investment Professional award.
Financial Advisor, AAMS®,

As a Financial Advisor with Wells Fargo Advisors, I can deliver a full range of investment planning strategies tailored to your unique needs. Whether you are investing for retirement, education expenses or some other goal, I will help you make informed decisions about your investment strategy. You have access to additional resources available through a liates, including trust and estate services, insurance products and much more.
For more information about how I may be able to help you pursue your nancial goals, please contact me.
6445 Poplar Avenue • Memphis, TN 38119 Phone: 901-214-2313 kent.c.mathis@wellsfargo.com www.home.wellsfargoadvisors.com/kent.c.mathis
This award was issued on 10/01/2024 by Five Star Professional (FSP) for the time period 01/09/2024 through 08/09/2024. Fee paid for use of marketing materials. Self-completed questionnaire award; 54 (9% of candidates) were named 2024 Five Star Wealth Managers. The following prior year statistics use this format: YEAR: # Considered, # Winners, % of candidates, Issued Date, 1/20/20 - 8/21/20; 2019: 544, 54, 10%, 10/1/19, 1/28/19 - 8/16/19; 2018: 548, 69, 13%, 10/1/18, 2/6/18 - 8/27/18; 2017: 400, 52, 13%, 10/1/17, 2/6/17 - 8/28/17; 2016: 447, 105, 2012: 695, 166, 24%, 10/1/12, 3/30/11 - 8/19/11.
Wealth managers do not pay a fee to be considered or placed on the final list of Five Star Wealth Managers. The award is based on 10 objective criteria. Eligibility criteria – required: 1. Credentialed as a registered investment adviser (RIA) or a registered investment adviser resulted in a license being suspended or revoked, or payment of a fine; B. Had more than a total of three settled or pending complaints filed against them and/or a total of five settled, pending, dismissed or denied complaints with any regulatory authority or FSP’s consumer C. Individually contributed to a financial settlement of a customer complaint; D. Filed for personal bankruptcy within the past 11 years; E. Been terminated from a financial services firm within the past 11 years; F. Been convicted of a felony); 4. Fulfilled their firm review served; 10. Education and professional designations. FSP does not evaluate quality of services provided to clients. The award is not indicative of the wealth manager’s future performance. Wealth managers may or may not use discretion in their practice and therefore may no guarantee as to future investment success, nor is there any guarantee that the selected wealth managers will be awarded this accomplishment by FSP in the future. Visit www.fivestarprofessional.com. This year we honored 1 Memphis-area investment professional

5050 Poplar Avenue, Suite 2200
Memphis, TN 38157
Phone: 901-844-0370
Cell: 901-848-5527
hulon@i-wmonline.com www.i-wmonline.com



2013, 2015 – 2024 Five Star Wealth Manager
With decades of experience and a passion for serving our customers, Independent Wealth Management, LLC is more than our name — it’s our commitment to you. Our job is to help you establish the foundation for your financial security, uniquely defined by your dreams and objectives. As your life and circumstances change, we will be there to make sure your plan evolves right along with you. Our core values guide us as we guide you. We treat you like a person, not a portfolio balance. It is our privilege to know you, serve you and empower you to achieve financial security and be independent.
Securities and advisory services offered through Commonwealth Financial Network®, Member FINRA/SIPC, a Registered Investment Adviser. Independent Wealth Management and Independent

Sudhir Kumar Agrawal Ameriprise Financial Services, LLC
Shelly Halford Baker Waddell & Associates
William Alexandre Bizot
Wells Fargo Advisors
Becky Ahl Bridgmon
Morgan Stanley
Terry Allen Brough
Raymond James & Associates
Chirag Dinesh Chauhan
Bluff City Advisory Group
James Euart Cochran
Commonwealth Financial Network
Robert Joseph Cremerius Prudent Financial
Richard Schaben Ditter Pier Financial Advisors
Brian Kevin Douglas Ameriprise Financial Services, LLC
Leslie Hill Drummond
Summit Asset Management LLC
Lee Russell Elander IV Ameriprise Financial Services, LLC
Kathleen Marie Fish Fish and Assocates
Julius Randolph Flatt MML Investors Services
Cecil Adair Godman Mercury Investment Group
Sarah Russell Haizlip Summit Asset Management LLC
Stephen Edward Harris Sr. Bluff City Advisory Group
Jay Lawrence Healy Beacon Pointe Advisors
Lance Wayne Hollingsworth
Summit Asset Management LLC
Stacey Stephenson Hyde
Envision Financial Planning
James Johnston
Financial Resource Management
Josh James Joiner
Vere Global Asset Management
Larry Wayne Karban
Atkins Capital Management
Marty Samuel Kelman
Kelman Lazarov
Brian Patrick Kinney
Dominion Partners Wealth Management









assess your short-term goals such as buying a house and show you how that can also benefit any long-term goals you may have overlooked.




All award winners are listed in this publication.
John Norfleet Laughlin
Summit Asset Management LLC
David Jonathan Lee
Summit Wealth Group
Jonathan D. McAlister
Kimery Wealth Management
Sreeni Meka
Lakeland Wealth Management
John C. Miller
Edward Jones
Mark Christopher Miller
UCL Financial Group
David Landon Mills
Shoemaker Financial
George Henry Moore
Ashford Advisors
Hugh Harold Parks
Envision Financial Planning
Vincent Carlton Perry Ameriprise Financial Services, LLC
David Anthony Pickler Pickler Wealth Advisors
Lindsey Donovan Rhea Alia Wealth Partners
Conrad Butler Richards Wells Fargo Advisors
Ivan Juan Rodriguez
New Southern Advisory Services
Bryan L. Roper Wells Fargo Advisors
James Sego Sego Wealth Management, LLC
James Sims
Ameriprise Financial Services, LLC
Edward Tennent Taylor Delta Asset Management
Julie Westbrook Terry Ameriprise Financial Services, LLC
Samuel Alexander Thompson III
Summit Asset Management LLC
Michael Lowell Turner
Ameriprise Financial Services, LLC
Steven Wishnia
Highland Capital Management LLC
Investment Professional
Kaitlyn M. Cornett Baker Donelson
was used for rating. This rating is not related to the quality of the investment advice and based solely on the disclosed criteria. 600 Memphis-area wealth managers were considered for the Research Period. 2023: 542, 51, 9%, 10/1/23, 1/9/23 - 7/31/23; 2022: 489, 46, 9%, 10/1/22, 1/31/22 - 8/5/22; 2021: 548, 50, 9%, 10/1/21, 1/11/21 - 8/13/21; 2020: 542, 42, 8%, 10/1/20, 23%, 9/1/16, 3/30/16 - 8/24/16; 2015: 690, 143, 21%, 10/1/15, 3/30/15 - 8/19/15; 2014: 1,034, 152, 15%, 10/1/14, 3/30/13 - 8/19/13; 2013: 880, 166, 19%, 10/1/13, 3/30/12 - 8/19/12; representative; 2. Actively licensed as a RIA or as a principal of a registered investment adviser firm for a minimum of 5 years; 3. Favorable regulatory and complaint history review (As defined by FSP, the wealth manager has not; A. Been subject to a regulatory action that complaint process. Unfavorable feedback may have been discovered through a check of complaints registered with a regulatory authority or complaints registered through FSP’s consumer complaint process; feedback may not be representative of any one client’s experience; based on internal standards; 5. Accepting new clients. Evaluation criteria – considered: 6. One-year client retention rate; 7. Five-year client retention rate; 8. Non-institutional discretionary and/or non-discretionary client assets administered; 9. Number of client households not manage their clients’ assets. The inclusion of a wealth manager on the Five Star Wealth Manager list should not be construed as an endorsement of the wealth manager by FSP or this publication. Working with a Five Star Wealth Manager or any wealth manager is with the Five Star Investment Professional award.



BY ALEX GREENE AND SAMANTHA COOKE
hile many cities have suffered shrinking budgets for school music programs and local arts funding, Memphis is home to a dedicated coterie of educators and music lovers who are helping us keep the beat swinging in the nongovernmental sector, beginning with three organizations that are helping to carry on the iconic “Memphis Sound” both inside this city and around the world.

Stax Records was more than a record label. It was a bastion of multiracial teamwork and community uplift that fed the entire Soulsville neighborhood — which made its 1975 shuttering due to involuntary bankruptcy that much more tragic. But from the start, when former Stax publicist Deanie Parker began talking with interested parties in the ’90s about ways to honor the Stax legacy, she wanted to preserve that ethos.
“What’s wrong with a museum and a companion school of some sort, an academy or a performing arts center?” she recalls telling potential investors. “I’d like for people to study and preserve and promote what we did. And pass it on, with an educational component and a museum that people could come and see.”
And so, while the Stax Museum of American Soul Music seemed to be the main attraction, an accompanying music academy was baked into the concept from the start. Indeed, as plans for both came to a head in the early 2000s, the Stax Music Academy (SMA) grew in importance.
“We were driven by building the Stax Museum of American Soul Music,” says Parker. “But then I became reacquainted with that community and realized how that area had decayed after Stax was closed. It had deteriorated beyond recognition. People didn’t give a damn because they felt that they had been thrown
away and that nobody cared. So it was good that the board decided to switch horses, and you know what we finished and cut the ribbon on first? e Stax Music Academy. at was opened a year before the museum.”
In the two decades since then, the Stax Music Academy has educated a new generation of musicians wellschooled in the art of music, grounded in R&B and soul but with a firm grasp of music theory and multiple styles. And their alums have excelled. In September 2022, when Booker T. Jones performed at the Stax Museum to celebrate the 60th anniversary of “Green Onions,” he was accompanied with great finesse by “the Franklin triplets,” three brothers playing drums, bass, and guitar who had learned the music of the MG’s well during their time at SMA. Other students routinely perform with Stax greats like William Bell, Carla omas, or Mavis Staples, either at the Overton Park Shell or while touring in Europe, Australia, or Asia.
The sheer creativity of Stax overlaps with the SMA’s fundraising activities. Who else has partnered with the city’s venerable Dinstuhl’s Fine Candies and Memphis Record Pressing to produce a limited-edition, co-branded chocolate record? Then there’s their brilliant red tennis shoe, sporting a design inspired by the tile mosaic outside the Stax museum building. Of course, one can always donate directly, and even send your kid to study there. Find out more at staxmusicacademy.org or on social @staxmusicacademy. — Alex Greene

Summer for the City event in 2023.


Memphis Music Initiative (MMI) offers opportunities for Black and brown young people to learn about music and equip them with professional and personal skills to help them later in life.
“Our mission,” says President and CEO Amber Hamilton, “is to provide young people across Memphis with equitable access to high-quality, transformative music engagement. We just want to make sure that people, with music really being the heart of Memphis, can access music instruction, song-writing, creative liberation, all kinds of things to keep them motivated and interested in the arts.”
be the ground-level for the next generation of Memphis music,” she says.
Those who benefit from these opportunities are also more engaged in school, more confident in their creative abilities, and more likely to advocate for themselves and seek even more opportunities. Interns with MMI Works are able to gain professional experience in the arts and work in teams to create their own projects.
“It’s professional and personal development,” says Hamilton. “We work with organizations across Memphis to create a robust, full ecosystem of music. We support Black- and brown-led organizations, who are regularly underfunded, so that we can preserve the culture of music in Memphis.”
above: MMI students learn the recording arts as well as traditional musicianship.
She defines creative liberation as “the idea that you’re free to make and be whoever you want to be, and how that manifests in your creative practice.” is can be done inside and outside of school, through music lessons, grants, and paid summer internships with art organizations across Memphis. “Songwriting is an important social and emotional outlet,” Hamilton says. “ ese times are very uncertain and challenging for young people in terms of their emotional health, so we need to give young people as many creative outlets to discuss their feelings as possible.” By teaming with local professional artists and creative organizations, MMI works hard to ensure Memphians are getting the outlets and learning opportunities they need to thrive. e results are impressive. “ ey are doing everything from going on to college to pursue degrees in music, or getting advanced scholarships from playing in band at a university level, to becoming musical entrepreneurs and building their own businesses to really
Currently, MMI is working on a campaign called 25x25, where they’re aiming to raise $25 million by the end of 2025. ese funds would significantly boost not only MMI, but 17 additional Black-and brown-led creative development organizations, such as the Memphis Jazz Workshop and Cazateatro, with a whopping $1 million each.
ese organizations typically work with annual budgets under $250,000, so 25x25 would allow them to go above and beyond their normal goals. ey would be able to pour money into vans, help with transportation needs, and invest in infrastructure to reach more Memphian youths than ever. Hamilton notes that the biggest contributions so far have come from individuals in Memphis.
“Every little bit helps,” she says. “We really are hoping that the Memphis community can come together to support this one effort, which will help a very wide range of organizations.”

MMI will have an end of the year event to celebrate what they’ve accomplished in 2024 (date TBD), so be sure to follow their Instagram @mmusinitiative or check out their website at memphismusicinitiative. org for updates and ways to help their cause.
— Samantha Cooke
Music education benefits students is multiple ways, teaching “skills in leadership, teamwork, and discipline,” as the Stax Music Academy website notes. But those select students who pursue music careers can have a rocky road ahead of them. at’s where Music Export Memphis (MEM) comes in. Founded by former publicist Elizabeth Cawein in 2015, it’s dedicated to promoting and supporting Memphis music across the world and here at home. And MEM puts its money where its mouth is.
Take MEM’s Ambassador program, which re-frames touring Memphis artists as representatives of their city, and duly subsidizes their tours. As the organization explains, such touring bands are “playing for music lovers who might be interested in planning a trip to Memphis or may add Memphis to their list of cities for job searching after spending an evening with one of our artists.”
Often, just a small leg-up from MEM can make all the difference for a band playing clubs on the road with very narrow profit margins. Best of all, the nonprofit clearly understands the touring process, judging from the manifold ways that an artist can become an Ambassador. ese include unrestricted cash tour grants, scholarships for attending conferences or professional
development events, grants supporting the creation of merch to be sold on tour (as long as those shirts, hats, and stickers are made in Memphis), and even a catch-all called Ambassador Access, a six-month cohort-style program that offers education, mentorship, cash grants, and booking and marketing support to Memphis artists touring for the first time.
Beyond that, MEM also advocates for musicians on the home front, even conducting market research about audience preferences and musicians’ thoughts on fair pay, to further stoke support for local players. And, thanks to Cawein, the organization also fosters collaboration between local artists with what may be the city’s most creative fundraising event. Sure, one can always visit musicexportmemphis.org to make a direct donation, but it’s even more fun to attend one of the organization’s live showcases or the annual Tambourine Bash.
For the Tambourine Bash, a ticketed benefit concert (the latest one was held at the Overton Park Shell on October 10th), Cawein mixes and matches groups of solo artists and bands, creating ad hoc, collaborative ensembles to perform together for one night only. Cawein’s passion for the actual music being made in Memphis is obvious from her curation, clearly a labor of love.
“Curating this lineup is one of my absolute favorite things that I get the privilege to do,” she says. “And artists around the city know about it, so they get excited. I send that email saying, ‘Hey, are you available on October 10th?’ And they get pumped. I love that.”
To learn more about Music Export Memphis and get involved, readers can visit musicexportmemphis.org or follow them on social media @musicexportmem. — Alex Greene

culminated, true to form, in an allstar performance of classic Memphis hits by all the artists involved, directed by Boo Mitchell of Royal Studios.
above: Elizabeth Cawein, founder and executive director of MEM.

ESTABLISHED: 1973
CLIENTS SERVED: 22,193
EMPLOYEES: 470
LOCATIONS: 10
LOCATION
2220 Union Avenue, Memphis, TN 38104
PHONE
Corporate Office: 901.567.3554
Patient Intake: 901.369.1410
CONTACT
www.alliance-hs.org @alliancehs901 @alliancehealthcareservices901


ALLIANCE HEALTHCARE SERVICES
BOARD
Ron Aven
Murphysteen Counts *
Phyllis Jeans
Norma Lester *
Trent McVay *
Martin Petrusek *
Quinton Robinson
Gabby Salinas *
Karole Shorter
Nina Staples
Anna Stavrum
Altha Stewart
Gary Shorb * Stephen Wilke *
Dianne Young
* Also serves on Foundation Board
ALLIANCE FOUNDATION BOARD
Joe Birch
Andy Cook
Kim Gaskill
Anna Lopez
Laurie Powell (Ex Offi cio)
Beverely Robertson
Stacey Rokas
Memphis and Shelby County are experiencing a mental health crisis and substance use epidemic. It impacts our families, young and old, in every demographic—the greater community and ultimately all of us. Unlike some of the chronic and unexpected situations we face daily, that at times feel insurmountable, this is the thing we can all do something about. Individuals’ and families’ entire lives and futures will be changed for the better as they are treated in a thoughtful, caring, and therapeutic environment.
We believe we can, and we hope you will show you believe in this effort by sharing your own time, talents, and treasures. A new day is coming in which no one will be turned away when suffering through a mental health crisis. We invite you to be part of the solution to this challenge. It’s the thing we can all do something about.
Promoting Wellness in our Community: A community without stigma or barriers to receiving quality behavioral healthcare.
We provide a full continuum of crisis services, including pre-arrest diversion, emergency room diversion, a walk-in center, a mobile crisis unit, crisis stabilization beds, addiction beds, and detox beds. The goal of all our crisis work is to assess patients for mental health and addiction and get them back into the community as soon as possible. All services include referrals and access to appropriate levels of care including outpatient follow-up services.
Alliance provides a full continuum of housing based on an individual’s needs. These needs range from housing for medically fragile patients to independent housing for individuals 18 and older who are ready to live on their own. Housing clients come to Alliance through crisis services and referrals and must have a mental health diagnosis. Our primary goal is to keep patients out of the state institutions and on the road to recovery.
Our approach to treating addiction is based on “no wrong door.” Many patients come to us through crisis services, but we also accept referrals from community partners like the Memphis Area Prevention Coalition, hospitals, Shelby County Mental Health Court, and the Shelby County Division of Corrections.

We provide medical detox, group therapy, basic and intensive outpatient treatment, individual therapy, psychiatric and medication evaluation, and medication assisted treatment. More than half of those we see with a substance abuse issue have an underlying mental health diagnosis.
All of our service areas are connected, but adult mental health lies at the heart of it all. We employ evidence-based intervention to treat a comprehensive array of mental health disorders in adults. Patients come through crisis and community referrals. We approach trauma and every other presenting problem we see with a treatment plan based on the presenting life story of every patient, seeking to reframe the trauma and create a new narrative.
Treating children and families is based on a keen awareness of social determinants of health, the economic and social conditions that influence individual and group differences in health. We see many patients from single parent households and a vast array of trauma and adverse childhood experiences. And like in other service areas, COVID lockdowns and social isolation combined with an increasing acceptance of mental health in popular media means our volume in this area has increased significantly. Our team approach is key — it’s not just a therapist, it’s a whole team wrapping itself around each patient, from psychiatrist and practitioner to case manager and family support therapist.



WehaveanepidemicinMemphisandtheMid-South -amentalhealthcrisisandsubstanceuseepidemic. Itimpactsfamilies,communitiesandultimatelyallof us.Individualsexperiencingamentalhealthcrisis don'tdeservetobesweptundertherug.They deservebetter-andMemphisandShelbyCounty deservebetter.Allianceisaskingforyourhelp-to buildastate-of-the-artWellnessCampusdedicated tocrisisinterventionandcareforchildrenandadults. Willyougivetodaytohelpthethousandswhoneed mentalhealthservices?
AllianceHealthcareServicesisthelargest nonprofitcomprehensivebehavioralhealth providerinWestTennesseeandShelby County.Offeringoutpatient,in-patient,homebased,andcommunity-basedprograms, includingacontinuumofcrisisservicesto adults,childrenandfamilies.
Theseservicesincludeoutpatienttherapy, medicationmanagement,carecoordination, intensivein-hometreatment,peersupport services,jobplacement,independentliving homes,supervisedgroupandresidential homes,detoxandsubstanceabusetreatment.
AsShelbyCounty'ssafetynetprovider,noone isturnedawayregardlessofanindividual's abilitytopay.




ESTABLISHED: 1913
NUMBER OF EMPLOYEES: 3,000
2023 REVENUE: $738,155,000
• Special Events – 24%
• Contributions – 35%
• Bequests – 23%
• Contributed Services, etc. – 16%
• Other - 2%
• Total Public Support– 100%
LOCATION
5101 Wheelis Dr., Ste 100, Memphis, TN 38117
PHONE
800.227.2345
CONTACT
Cancer.org/Tennessee Facebook.com/ACSTennessee @ACS_Tennessee linkedin.com/company/acstennessee/


While most people know us for our research, we do so much more. We promote healthy lifestyles to help you prevent cancer. We research cancer and its causes to fi nd more answers and better treatments. We fight for lifesaving policy changes. We provide everything from emotional support, to lodging, to the latest cancer information for those who have been touched by cancer. And we do it all 24 hours a day, 7 days a week.
The American Cancer Society exists because the burden of cancer is unacceptably high. We are the only organization that integrates advocacy, discovery, and direct patient support to measurably improve the lives of cancer patients and their families. Cancer affects everyone, but it doesn’t affect everyone equally. We are working to ensure everyone has a fair and just opportunity to prevent, detect, treat, and survive cancer.
• Rides to and from cancer treatment for patients through our Road To Recovery program.
• Providing a free place to stay near treatment centers in Memphis at our Hope Lodge, which provides 40 guest rooms near treatment centers in the area.
• Investing in groundbreaking research — Over the last 20 years, the American
• Cancer Society has funded 118 grants totaling $52.8 million in Tennessee.
• Currently, ACS is funding 16 grants totaling almost $12.1 million in TN.
• In 2024, ACS invested $131,000 in transportation and lodging grants for Tennessee health system partners to help patients and caregivers access cancer treatment.
• Mobilizing volunteers in underserved communities through the CHA program to help educate, direct to no cost screening and conduct follow-ups to ensure individuals are making and
keeping screening appointments. In 2023, 70 CHA volunteers educated neary 13,000 Memphis community members.
Road To Recovery — The American Cancer Society is seeking volunteers to drive cancer patients to treatment appointments. To learn more or to volunteer visit cancer.org/drive.
American Cancer Society fundraising campaigns and events provide corporations, individuals, and communities the opportunity to support our mission to save lives and improve access to quality health care for all. Local events include:
• Making Strides Against Breast Cancer of Memphis — participants celebrate and honor breast cancer survivors and caregivers and raise funds to help end breast cancer. Visit makingstrideswalk. org/memphistn to learn more.
• Relay for Life of the Midsouth — brings communities together to honor cancer survivors, remember loved ones lost, and fight back. Learn more at relayforlife. org/memphistn.
• Men Wear Pink of Memphis — distinguished groups of community leaders to raise awareness and money for breast cancer treatment and prevention. Visit menwearpink.org/memphistn to learn more or join us!
EXECUTIVE LEADERSHIP
Sco Holmes
Executive Director, Tennessee
BOARD MEMBERS
Dave Smith - Chair
President, eviCore
Samantha Kirby VP, HCA/Sarah Cannon
Jim Lancaster
Mainstreet Health
John Bearden
Lauren Peach
Amanda Mathis
Dollar General
Sinema & 8th and Roast
Mary Alice Heston
Global VP Alliances, Reltio
Connie French
Darlene Smith
Chattanooga Plastic Surgery Paula Masters
Chad Pendleton



Screening tests can detect cancer before it starts or catch cancer early, when it may be easier to treat. Many tests are available for free or covered by insurance.
Talk to a doctor about which screening tests are right for you.
Age 25+ Cervical screening
Age 45+ Colorectal & breast screening
Age 50+ Prostate & lung screening
Learn more at cancer.org/getscreened


ABOUT US
STUDENTS: 1454
EMPLOYEES: 228
CAMPUSES: 6
ESTABLISHED: 2018
SIX CAMPUS
Berclair (K-8) – 3880 Forest Ave, 38122
Binghampton (K-8) – 2540 Hale Ave, 38112
Frayser (K-8) – 3690 Thomas St, 38127
Hickory Hill (K-8) – 3572 Emerald St, 38115
Midtown (9-12) – 61 N McLean Blvd, 38104
Orange Mound (K-8) – 2718 Lamar Ave, 38114
SOURCES OF FUNDING
Individuals – .37%
Corporations & Organizations – 3.04%
ADDRESS
61 N McLean Blvd, Memphis, TN 38104
PHONE
901.618.7422
EMAIL ADDRESS: info@compassmemphis.org WEBSITE compassmemphis.org facebook.com/compassmemphis instagram.com/compassmemphis

LEADERSHIP
Kristi Baird
Executive Director
BOARD
Dr. Richard Po s
Christian Brothers University
- President
Marty Petrusek
Trane US - Treasurer
Marty Regan
Lewis Thomason LawSecretary
VISION: Following Dr. Martin Luther King Jr.’s ideal of education: “Intelligence plus character — that is the goal of true education.” This true education provided within a supportive, joyful, and hopeful school culture — will prepare our students to be positive agents of change in their community.
Across the nation, schools are closing in urban neighborhoods leaving a gap in school choice. Compass Community Schools represent an unprecedented example of urban charter schools in Memphis, opening to serve predominantly low-income students that would otherwise be left behind by the closing of neighborhood schools. Compass opened its doors to students in July 2019 to welcome all students and diversity in all forms. Today, Compass serves over 1400 students throughout six campuses in the urban Memphis neighborhoods of Berclair, Binghampton, Frayser, Hickory Hill, Midtown, and Orange Mound. Much of our student body is comprised of Latinx (67%) and African American (30%) students. 51% of our students come from homes where English is not the primary language. In Memphis, where 45% of all children live in poverty, 95% of our families are from the urban Memphis area and 77% are from zip codes with the lowest median household income (below $42,100) in Shelby County. Additionally, 46% of Compass students receive multilingual learner services (MLL), and another 6% receive special education services (SPED).
Emily Greer
Greer Leadership Solutions
Leslie Jones
Compass-Midtown parent
Teresa Sloyan
Hyde Family Foundation
Dr. John Smarrelli
Christian Brothers University
Bishop Emeritus J Terry
Steib
Diocese of Memphis
Service learning serves as the intersect between our academic excellence and values-based character education pillars — bringing to life content, concepts, and skills gleaned through hands-on, tangible experiences. While immersed in servicelearning projects, students experience the fulfillment of giving back to their communities and helping others. is program is a significant part of Compass life and sets us apart from other educational options. We have partnerships with agencies that are focused on social services and the environment. We want to empower our students to be able to recognize needs in our communities and identify ways they can be of service. In doing so, we are supporting our students to become agents of change in their communities.
Because Compass opened during a
pandemic, for the first time, we see the effects of a full year of learning as evident through our 2021-2022 TVAAS scores. According to the State of Tennessee, 2 Compass Schools scored a TVAAS of 4, and 4 Compass Schools scored a TVAAS of 5, which is the highest distinction based on TVAAS composite scores. e Tennessee Value-Added Assessment System (TVAAS) measures students’ academic growth over time. e state looks at the data and rates schools from 1 to 5. A Level 5 composite means we are successfully moving students toward proficiency and beyond. Significant growth, as characterized by levels 4 and 5, means our students are rebounding from the negative impacts of the pandemic, our teachers are effectively helping students to reach academic goals, and our curriculum plan is getting results. Additionally, 2 Compass Community Schools (Midtown and Hickory Hill) also earned the esteemed designation of Reward schools by the State of Tennessee. Reward schools are schools that improve overall student academic achievement and growth for all student groups. e Reward designation is the highest honor schools can earn when evaluated via the state’s accountability model. Reward Schools are improving in terms of achievement and growth for all student groups. Only 61 schools in the district earned this honor, and only 13 were charter schools. We are proud of these honors because it affirms that our strategies and teachers are helping students make academic gains.









As this new year begins, we hope you will follow us on our journey and support us as we continue to increase Reading and Math scores by:
•Adding classroom and school libraries to support at-home reading.
•Partnering with Arise2Read to practice reading skills with 2nd grade students.
•Training teachers in the “Science of Reading” with Memphis Literacy Institute.
We must close the gap between what the state pays and what it costs to educate a child. Show the students at Compass Community Schools that they are a priority. Support education. Together, we can bring the dream of a world-class education to the students who need it most.
Level The Learning Gap. compassmemphis.org/invest
Pancreatic Cancer Support
ABOUT US
ANNUAL REVENUE: $250,000
ESTABLISHED: 2003
SOURCES OF FUNDING
INDIVIDUALS: 90%
CORPORATIONS: 5%
ORGANIZATIONS: 5%
ADDRESS
6060 Poplar Avenue, Suite 140,Memphis, TN 38119
PHONE 901.606.7542
WEBSITE www.kostenfoundation.com facebook.com/KostenFoundation/ @KostenFDN
Support Group: The Kosten Foundation in-person and virtual support group is free and open to everyone affected by pancreatic cancer, including patients, family members, caregivers and anyone interested in supportIng those impacted by the disease and learning more. Everyone is welcome. The Support Group meets on the second Saturday of every month. If you would like to join the support group and for additional information, please visit KostenFoundation.com.
Kick It 5K: The Kick It 5K takes place on the last Sunday of October and is the largest fundraiser for the Kosten Foundation. The all-ages event includes a 5k run, 1-mile fun walk, opportunities for spirit runners, an inspirational memorial and survivor ceremony, entertainment and food vendors.
Tribute at Twilight: For Pancreatic Cancer Awareness month in November, the Kosten Foundation is proud to host the Tribute at Twilight. The event is for survivors of pancreatic cancer, Kosten Foundation support group members and those who have lost loved ones to the disease. Participants share stories and there is a symbolic presentation in remembrance and honor of those lost to pancreatic cancer and those still fighting it.
Alan L. Kosten
Chairman Of The Board
Jeffrey A. Goldberg
President
Thomas Craig
Director Of Community Engagement


To establish support and a forum for communication among those afflicted with pancreatic cancer via support group meetings, our website, social media channels, and events. To assist with the training of future pancreatic cancer surgeons. To provide funding for a yearly Memphis public lecture on pancreatic cancer delivered by a nationally and or/ internationally renowned expert on the disease.
To provide funding for clinical and basic research toward improving outcomes for those afflicted with pancreatic cancer. It is our sincere hope that we can provide an informative, compassionate, and humane approach toward improving the quality of life for those afflicted with pancreatic cancer and their families. Additionally, through research efforts, it is our very realistic passion to find a path to the early diagnosis and cure of pancreatic cancer in our lifetimes.
ABOUT THE HERB KOSTEN FOUNDATION: The Herb Kosten Foundation for Pancreatic Cancer Research was founded in 2003 by the family of Herb Kosten after his death due to pancreatic cancer. Kosten’s family sought to improve community support, awareness, and funding for pancreatic cancer, one of the deadliest known cancers.
As the only organization of its kind in a five-state area, the group focuses on providing access to resources and support through a combination of communication, initiatives, programs, and events. All members of the Foundation are volunteers who donate hundreds of hours each year and believe in leading by example. The organization has raised more than $2,500,000 for pancreatic cancer research and hosts a very active monthly support group meeting for patients, their families, and anyone interested in learning more about pancreatic cancer.
In 2004, in honor of Kosten’s love of tennis, the Memphis-based organization began hosting annual tennis tournaments to raise money to fight pancreatic cancer and in

2011 the group held its first Kick It 5K run/ walk. Money raised from the Kick It 5K and other Kosten Foundation events help fund pancreatic cancer research. For more information about the Kosten Foundation, its programs, and events, visit the website at kostenfoundation.com.
The inaugural Kick It Pickleball Tournament was held on June 1 - 2, 2024. The event raised over $37000, attracting 200 participants and spectators for a weekend filled with Pickleball matches, community engagement and fundraising. 2025 dates are to be determined. All proceeds from the tournament are used for pancreatic cancer research and support.

ABOUT US
ANNUAL REVENUE: $6.6M
EMPLOYEES: 66
ESTABLISHED: 1916
SOURCES OF FUNDING
City - 10.1%
Contributed Income - 73.7%
Earned Income - 9.5%
Endowment - 6.7%
ADDRESS
Open in Overton Park 1934 Poplar Avenue, Memphis, TN 38104
PHONE
901.544.6200
WEBSITE brooksmuseum.org facebook.com/brooksmuseum instagram.com/brooksmuseum/

LEADERSHIP
Zoe Kahr
Executive Director
Jennifer Draff en
Director of Collections, Exhibitions & Publications
Kathy Dumlao
Director of Education & Interpretation
Bethann Easterly
Executive Assistant & Board Liaison
Rosamund Garre
Chief Curator
Johnny Hill
Director of Security and Facilities
Jeff Rhodin
Chief Revenue Officer
Shawn Taylor
Director of Finance
Melissa Whitby
Chief Development Officer

MISSION & VISION: We create joy through the power of art.
GIVING:
ere are many ways for individuals, foundations, and corporations to support Memphis Brooks Museum of Art. Your generosity makes a profound impact on the community by:
Elevating the arts:
Memphis’ treasured collection of over 10,000 artworks spans 5,000 years of global culture. Your support brings that art to life in meaningful ways for thousands of visitors each year.
Enriching the community: Memphis‘ art museum is committed
B OARD
Carl Person, Chair
Owner - Customized Solutions
Milton L. Lovell, Vice Chair
President & Chief Investment Officer
Element40 Management
Mat Parker, Jr., Treasurer
Community Volunteer
Tanya Hart, Secretary
Chief Human Resources Officer - First
Horizon
Sol Aponte
Co-Founder - Art Melanated
Jenna Bedsole
SVP, General Counsel, and SecretaryAutoZone
Nathan A. Bicks
Attorney - Burch, Porter & Johnson, PLLC
Gloria Boyland
Community Volunteer
Nelda Burroughs
Co-Owner - First Choice Sales & Marketing Group
Kristi Carmichael
Community Volunteer
Rob Carter
Community Volunteer
Trevia Chatman
President - Bank of America Memphis
Erica Coopwood
Community Volunteer
Mary Lee Copp
Community Volunteer
Deborah Craddock
Community Volunteer
Brandice Daniel
CEO - Harlem’s Fashion Row
Sonia Eden
Neurosurgeon - Semmes Murphey Clinic
Oxford
Derek Fordjour
Artist - Fordjour Studio
Adam Hanover
CEO - Union Main Group
Debi Havner
Community Volunteer
to serving our city. Our duty extends beyond providing access; it is about fostering inclusivity and embracing the richness of our city’s diversity.
Advancing education:
Your generosity helps to fuel our essential education programs, opening doors of artistic exploration and inspiration for more than 20,000 school-aged children annually, many from Title I schools. anks to you, our community’s youth have been able to build empathy, tolerance, and critical thinking skills by participating in the museum’s award winning educational programs.
Robert Heard III
EVP, Private Banking Director - First Horizon
Rodney Herenton
Founder & Co-CEO - Channing Capital
Management
Barbara R. Hyde
Chair & CEO - Hyde Family Foundation
Linda Ivy-Rosser
Vice President - Forrester Research
Greg Jackson
Director of IT Technical Services -
International Paper
Jay Keegan
President & CEO - Adams Keegan
Kim MacQueen
Community Volunteer
Shanea McKinney
Clinical Account Manager - Cigna
Pharmacy
Logan Meeks
President Principal - A2H
Logan Scheidt
Real Estate Broker - Crye-Leike Real
Estate
Gail Schledwitz
Community Volunteer
Melyne Strickland
Johnson & Johnson
David Willmo
Co-Founder - Collins Willmott & Co.
Tate Wilson
CEO - Kemmons Wilson Family
Foundation
Amy Wright
Co-Founder & CEO - Macro Solutions/ Ditty TV
Gail George (ex-offi cio)
Member - Decorative Arts Trust
Haley Simmons (ex-offi cio)
City of Memphis - Chief of Policy and Programs




Supported by the Terra Foundation for American Art, the Henry Luce Foundation, the Arthur F. and Alice E. Adams Charitable Foundation, and Humanities Tennessee. Additional support provided by MLK50: Justice Through Journalism, Bill and Lisa Courtney, Underground Art, Inc. and Isabel



• Hospice – 5%
• General Support – 6%
• Humanitarian Fund & Help Funds – 5%
• Research & Education – 10%
LOCATION
1211 Union Ave., Suite 450, Memphis, TN 38104
PHONE
901.478.0704
WEBSITE
www.methodisthealth.org/give CONTACT
facebook.com/methodisthealth @methodisthealth
@MethodistHlth @MethodistHlth linkedin.com/company/methodist-le-bonheurhealthcare

METHODIST LE BONHEUR HEALTHCARE VISION: To enhance your health and well-being through high-quality, innovative and compassionate care.
METHODIST HEALTHCARE FOUNDATION MISSION: To uplift Methodist Le Bonheur Healthcare’s compassionate care for our entire community through philanthropy, health advocacy and a vision of healing and hope.
Cardiology, to advance research, treatments and technologies available to our patients and families.
Hospice Care, to ensure that quality, compassionate, end-of-life care and bereavement services are accessible to all.
Mental Health, to provide resources, support and navigation to address the behavioral health needs of our community.
Neurology, to advance our knowledge through research, expand supportive resources and programs for patients and families and advance the forms of treatment and technologies available to our community.
Oncology, to provide excellent clinical care, advance treatments through research and technology and combat disparities through improved access to preventative screenings for the underserved.
Sickle Cell, to offer a dedicated medical home and expert care to patients living with sickle cell disease in order to improve their quality of life.
FOUNDATION TEAM Zach
Social Determinants of Health to remove barriers that community members face in improving and maintaining their health and well-being, including social support resources and innovative programs and partnerships.
Transplant, to provide resources to patients and their families throughout the organ transplant process.
WAYS TO GIVE:
Donations can be made in a variety of ways to support programs, clinical service lines, community health programs and other initiatives that are important to our donors, including through:
• Bequests
• Cash Gifts
• Corporate, Government & Foundation Grants
• Employee Matching Giving Programs
• Event Sponsorships & Tickets
• Gifts of Stock
• Honoraria & Memorial Gifts
• In-Kind Contributions
• Shopper Loyalty Programs

Leanne McQuown
Elizabeth Ennis Manager of Annual Giving and Stewardship
Brian Meyers Manager of Grants and Communications
Bandar Khattab
Development Specialist
JoAnn Franklin
Foundation Relations Coordinator
Anna Levina
Finance Coordinator








From treating each patient with compassionate expertise to community programs that elevate the health of everyone we serve.
At Methodist Le Bonheur Healthcare, we believe life-changing transformations are possible with the right care. Whether we’re treating serious illnesses, promoting everyday wellness or launching a community-wide initiative, we’re dedicated to improving the health of our entire community. For over a century, we have been unwavering in our commitment to changing lives for the better.
ABOUT US
ANNUAL GIFT REVENUE: $1.5 million
NUMBER OF EMPLOYEES: 194
ESTABLISHED: 1932
SOURCES OF FUNDING
Individuals: 87%
Corporations: 5%
Organizations: 3%
Foundations: 5%
LOCATION
1245 Madison Avenue, Memphis, TN 38104
PHONE
901.722.3250
WEBSITE sco.edu
@sco.edu/facebook @sco.edu/twitter @linkedin.com/school/southern-college-of-optometry

As one of only two dozen optometry colleges in the United States, Southern College of Optometry is proud to serve as the only optometry college in the tri-state region serving Tennessee, Mississippi, and Arkansas. SCO’s appeal, though, is more than regional; with 530 students coming to Memphis from 46 di erent states and Canada, no other optometry college in America can claim the geographic diversity that SCO represents.
SCO’s national appeal can be explained by a number of factors. Since its founding in Memphis back in 1932, the college has long enjoyed a reputation for providing its students with a strong clinical education. As a result, SCO’s graduates excel at national board scores, professional leadership, and providing the eye and vision care needs of patients across the nation. In all, more than 7,000 American optometrists received their diploma from SCO.
of the Memphis population.
• Caring for school children throughout Shelby County, SCO’s school screening program helps identify and treat vision problems in children at an early age, in turn improving academic performance once sight has been corrected.

PRESIDENT
Dr. Lewis Reich
BOARD CHAIR
Dr. David Cockrell
BOARD MEMBERS
Dr. Allan Barker
Renee Brauns
Dr. Be y Harville Brown
Dr. Arthur R. Dampier
Dr. Anita Davis
Vicki Farmer
Dr. Charles Glaser
Dr. Mark R. Kapperman
Dr. Charles W. Kinnaird
Dr. James K. Kirchner
Dr. Jennifer Lyerly
Dr. Stacey Meier
Lynn Shaw, Sr.
Dr. Stuart Tasman
FACULTY REPRESENTATIVE
Dr. Carrie Lebowitz,
STUDENT REPRESENTATIVE
Kimberly Pham, ’26
OUR IMPACT ON MEMPHIS INCLUDES:
• Providing a major boost to the Memphis economy, with a 2024 economic impact report showing that SCO’s mission results in the creation of more than 1,136 jobs, with a direct economic impact of $179 million dollars.
• Operating three clinical eyecare facilities, all of which are open to the public in Memphis.
• Serving more than 50,000 annually at e Eye Center on SCO’s campus, the college’s FocalPoint location within Crosstown Concourse, and on the University of Memphis campus at University Eyecare.
• Aiding the education of optometry students, these patient care facilities serve a dual purpose by meeting the vision care needs of a large segment
SCO has been working on a campus master plan as well as working to identify funding opportunities to strengthen the college’s stature as a national leader in optometric education. Longer term, the college intends to enhance its campus facilities, improve safety, and work to sustain SCO’s presence into its second century of training optometrists from across the nation.
More than 85 percent of SCO’s employees support an annual campaign to fund college programs. SCO’s Development Team also engages alumni, ophthalmic industry partners, and other donors to secure funding in support of student scholarships and other initiatives.
At the community level, donors may support SCO’s “I Care for Kids” children’s vision program. is program provides vision care to children who could not otherwise afford services. Supporters may use Kroger Community Awards to designate SCO as a charity of choice.






SCO’s 530 students come to Memphis from 46 states and Canada, the most geographic representation of any optometry college in the country.


































































“J really was the prodigal son, you know?”
The son of Sun pours a lifetime of music into a new album cut in his father’s world-famous studio.
BY ALEX GREENE
This fall, news broke that was significant to a hopeful Memphis artist who released his debut album over the summer. As reported by the Independent Blues Broadcasters Association (IBBA), the album, For the Universe, had been the 20th most-played record on its members’ playlists in September. Not bad for the first release by a singer-songwriter who, up to that point, only played occasional gigs. But though he may be a newcomer in certain ways, he’s been making a name for himself since before he was born.





above: Halley and Jerry Phillips in the offices of Big River Broadcasting, home of WQLT-FM, WXFL-FM, and WSBMFM in Florence, Alabama; inset: Sam Phillips with a three-year-old Knox and a three-month-old Jerry; right: Collected photos from the sessions for John Prine's Pink Cadillac at Phillips Recording.
If that sounds like a fanciful line lifted from a Charlie Rich song, all the better. Because the name this artist inherited — Phillips — was deeply connected with musical legends like Charlie Rich, Ike Turner, Johnny Cash, Jerry Lee Lewis, Howlin’ Wolf, and Elvis Presley. is debut artist is Jerry Phillips, son of Sam Phillips and his wife, Becky, and inheritor of his father’s grand legacy in radio, music, and the recorded arts.
Just a toddler in 1950 when his father first opened the Memphis Recording Service that would later evolve into Sun Records, Jerry grew up amid the huge pool of talent that Sun helped propel to stardom throughout the 1950s and beyond. All of which might make his debut album seem like a foregone conclusion.
But nothing could be further from the truth. Part of the beauty of Jerry’s album, as both an artifact of his life and a contemporary work of art, is that it evokes qualities of character and craft embodied by his father and those he recorded, who, while ushering in the







celebrity culture that now surrounds us, did not arise from that culture. e mother wit and earthy grit of those first-generation rock-and-rollers lives on in Jerry’s music, as does the sheer feel: His album rocks, it cries, it sighs, it slinks, and it winks. Above it all sails Jerry’s expressive voice, the record’s greatest revelation, sounding reminiscent of — you guessed it — Charlie Rich, yet unmistakably unique. “Someone else said I sounded like him!” Jerry tells me, rightfully proud of the comparison. “Him and Johnny Rivers.”
Clearly Jerry absorbed enough of those musical forerunners to evoke their blend of the country and the city, the big beats and the ballads, the blues and the crooners, in his own natural, unhurried way. It all comes out in these songs. But so too does a lifetime of perspective and the hard-won wisdom that Jerry alone can claim.
And that may be why, while he’s not necessarily dwelling on his family’s storied past as he promotes his new record, he’s not hiding from it, either. If that history






is thoroughly documented elsewhere, most compellingly in Peter Guralnick’s masterful 2014 biography of Jerry’s father, Sam Phillips: e Man Who Invented Rock ’N’ Roll, it so imbues his current work in more subtle ways that he can’t help but celebrate it whenever he straps on a guitar.
Case in point: the sound of the record. How can you avoid your father while recording in a building — Sam Phillips Recording Service — that bears his name?
Phillips Recording is inescapably distinctive, still emblazoned with pop-art go-go dancer imagery on its mint-green and rose walls. But if the basic design of the studio, built on Madison in 1960, just around the corner from Sun Studio, and cosmetically unchanged since, was the work of Phillips the Elder, it took two Phillips the Youngers — Jerry and his late older brother, Knox — to maintain the place as Sam mostly drifted away from recording by the ’70s. e brothers kept what was most valuable (like the natural reverb chamber)











while updating other gear enough to make the business attractive to today’s artists. Recently, with vintage studios more in demand, that’s meant complementing the vintage vibe at Phillips with other vintage gear, like the newly refurbished Spectra Sonics mixing console once used at Stax Records, installed at Phillips under Jerry’s watch in 2022.
Recording through such equipment, in such a space, lent For the Universe a sound that’s hard to place in time. As studio manager, engineer, and album co-producer Scott Bomar told eCommercial Appeal, “I can’t think of any other studio where you can record in such an iconic room on such an iconic recording console. It’s got a little bit of a vintage sound, but it’s also modern at the same time. at’s the beauty of it. It could be from 1968, or it could be from 2068. It’s just totally timeless.”
Given the studio itself, the band’s tasteful accompaniment (Danny Banks on drums, Matthew Wilson on bass, TJ Bonta on piano, Rick Steff and the acclaimed
above: More from the Pink Cadillac sessions, co-produced by Knox (in yellow) and Jerry (in black), with an assist from Sam (in brown). inset top: Knox and Jerry pal around with Elvis. inset bottom: Jerry (center) played with the Escapades in the mid'60s, though he had more success with the Jesters.





What are the options for senior living? How can you be sure the standards remain high? What if your parents have different needs? What if those needs change?
At Belmont Village, we understand each situation is unique. Our experienced advisors will listen to your family’s story, then help you consider the questions you need for the answers they deserve. So you can confidently navigate the options from active adult to memory care and know what to look for in terms of management, food, care, and accommodations for couples with differing needs.
Our advisors are here to help. Just ask. BelmontVillage.com/JustAsk | 901-451-8871
Spooner Oldham on keyboards), and Jerry’s classic approach to songwriting, this album could have been made any time in the last half-century. ( at’s a compliment.) e studio is like a familiar living room to Jerry, who’s walked its floors for decades now. But Jerry and his daughter, Halley (who co-produced For the Universe and is the studio’s vice president) don’t think of the place as “retro.” It’s still a vital organism, and deeply expressive of the city outside its walls.
As Jerry told me in 2019, “People that are true-to-the-core musicians when it comes to creating something that’s going to last longer than you do, they’re … coming to places like Memphis. Because they can shift into a dif-


Jerry’s arm tattoo. “I put Howlin' Wolf on there, because he's my favorite artist.“
of the two Phillips brothers. As Guralnick writes in his Sam Phillips biography, “Jerry was different. Even at four-and-one-half he was more like his father in his bristling independence and determination to speak his own mind. … He was much more inclined to get into trouble than Knox.” at made him more of the rock-and-roller, and the only member of his family to be a Sun recording artist (something even his father could not claim, being a producer). He was still a teenager when e Jesters, a group in which he played rhythm guitar, recorded the now-classic “Cadillac Man,” featuring one Jim Dickinson on vocals. It was one of Sun’s last releases. Yet ironically, it epitomized Jerry’s rebelliousness. He wasn’t going to run the family business; he would live the music and be the rock he wanted to see in the world.
While brother Knox grew to be more actively involved in Phillips Recording and the music publishing game throughout the ’60s and after, Jerry was reluctant to do the




The staff at Twin Oaks Memorial Gardens & Funeral Home takes great pride in caring for our families, and has made a commitment to provide you with a beautiful, lasting tribute to your loved one. Honoring your loved one is our top priority, and part of that is assisting you deal with grief during this difficult time.
Everyone’s needs are different, and for that reason, families can entrust their loved one’s wishes to our staff. We have a wide range of resources to support you not only today, but in the weeks and months to come. Here, everyone is welcome.
290 GOODMAN RD E • SOUTHAVEN, MS 38671 662.349.9720 • TWINOAKSFUNERALHOME.COM



















The Farms at Bailey Station, a new LifeCare Retirement Community located in Collierville, offers Independent Living featuring expansive amenities and beautifully crafted residences, where you can live in comfortable elegance. Plus, the full continuum of high-quality care on-site at the Jordan River Health Campus. Schedule a tour today at (901) 422-5621.


Kirby Pines LifeCare Retirement Community, situated on 60 lush green acres in Memphis, offers Independent Living where residents can enjoy coming home to freshly reimagined Apartment Homes and charming, one-of-a-kind Garden Homes. All with the full continuum of high-quality care right on campus. Schedule a tour today at (901) 369-7340.
|
same. “I was a rebel,” he says. “I thought I was living under the shadow of Sam Phillips, you know. So, like, I was in the Army Reserves for a while.”
is was after e Jesters. And from there he forged his own independent path for a time. “I really was the prodigal son, you know? And then I woke up one day and said, ‘Why are you loading trucks, and why are you cleaning swimming pools, and why are you doing all this? Go back to your studio, man!’ And I did, and Knox and Sam and everybody welcomed me with open arms. ey didn’t bring up anything about my leaving or any of that. In fact, my dad told me, ‘ e reason you and I disagree a lot is because you’re just like me. You don’t want anybody to tell you what to do.’ And I said, ‘Well, you know what? You’re right.’”
“Jerry was different. Even at four-and-one-half he was m e like his father in his bristling independence and determination to speak his own mind.”
— PETER GURALNICK
By the 1970s, he was more involved at Phillips Recording again, and even co-produced John Prine’s Pink Cadillac album with his brother by that decade’s end. But through all that, he didn’t really pursue his own music. He’d played rhythm guitar as a teen, and would co-write songs here and there as he got back into record production, but it was only recently that he leaned into the role of singer-songwriter. And, in the personable way of life that all the Phillips seem to embrace, it was due to a friend paying a visit.
“Me and a guy named Jim Whitehead, who’s a piano player, were getting together every Wednesday in my home studio,” Jerry says, speaking of his home near Pickwick Lake, where he lives the life of a confirmed bachelor. “We did that for two years, just got together and had a good time. We were both kind of burned out on the music business, so we said, ‘Let’s just write some songs and have fun.’ So we started writing, and I was used to writing just by myself. I mean, I had co-written before, but this was really an eye-opening experience for me. Once we got through, we had a demo.”
Then came Covid, and a worsening of Knox’s longtime health issues. On April 15,
Tim & Kim, proudly independent for 3 years.
When we decided to open a restaurant after years in very different careers, not only did we have plenty of questions, but also a real need for a financial partner. i-bank gave us the guidance we needed to make our financial—and entrepreneurial—dreams come true.
Tim
& Kim Ware Owners, Wing Guru Whitehaven
Start your story with i-bank today, and find out why being proudly independent is the most rewarding way to bank.
i-bankonline.com



















2020, Jerry’s brother passed away, leaving a void in the family’s life and business. Sam had died 17 years earlier, in 2003. As Jerry said at the time, “It’s been a real hard thing for our family, because you know Knox was just as important as Sam in a way. He was the keeper of the history. He was the one that always knew everything about Sun. He was the one that always got things going.” Jerry, having already taken on more of Knox’s duties after years of health complications, came to a crossroads with Knox’s death. It seems to have fueled a new sense of urgency in Jerry, as both a businessman and an artist.

For the Universe was released by Omnivore Recordings on vinyl, CD, and digitally.
Both roles have caused him to take the past and the future more seriously than ever. Even as he strives to preserve and protect the business and legacy of Phillips Recording (not to mention the two radio stations in Florence, Alabama, still owned by the family), he is looking forward to what may yet come, using that classic studio to propel himself into his own future. Like the boundless vision implied by its title, For the Universe is truly lighting out for the unknown, and that’s just how Jerry likes it.
“I tried to get my dad to sit down with me, once,” he recalls. “I wanted him to play the recordings he made, starting with his fi rst record, play it, and then talk about it. And then go on to the next one. Play it, talk about it. And he just said, ‘You know, Jerry, I don’t care anything about the past. It’s just the future for me.’”
en he adds, “You know, Knox is gone, Sam’s gone, my mother’s gone. It’s me and my family now. And my daughters have been great. My family’s been great. I wouldn’t say I’m the most confident person in the world, you know what I mean? But making this record has helped me a lot. I feel more qualified to maybe go out there and do some live performances with me being the artist. Not just in the band, but the leader of the band.”

Lili Clark brings a fresh approach to the bar at Acre.
BY BRUCE VANWYNGARDEN
When you walk into Acre, it feels elegant and welcoming — at once cozy and spacious, with its high, timbered ceilings and rustic wood-framed bar. Behind that bar, you’ll usually find bar manager Lili Clark, who brings her own brand of creative drink-making to chef/owner Wally Joe’s iconic East Memphis establishment.
A 2012 graduate of St. Benedict at Auburndale, Clark says, wryly, “I grew up in the hip and happening part of town: Cordova. Strip malls, T.J. Maxx — that was the place to be.”
After a stint at the University of Memphis, Clark began working in the kitchen at Jason’s Deli, then moved on to Mulan in Cooper-Young for three years, where she gained her first experience at mixology.
“ ey had all these great ingredients — lemongrass, ai basil, various peppercorns — and they let the bartenders experiment,” she says. “When they came up with something good, the owners would say, ‘Put it on the menu.’ I wasn’t a bartender, but they let me play around. I was sort of an unofficial bar back, and that’s where I got the mindset for creating cocktails.”
Clark’s first real bartending job was at Terrace at e River Inn on Mud Island. “It was fast-paced in the summertime,” she says. “I like to call it ‘Nineties-style’ bartending: every kind of sweet liqueur, every flavor of Schnapps, lots of basic drinks. But they also had a ‘Bartender’s Surprise’ on the menu, and that was literally whatever the bartender felt like making, so I would have a lot of fun.”
Next came three years at Catherine & Mary’s, Andy Ticer and Michael Hudman’s downtown Tuscan restaurant, where Clark continued to hone her bartending skills, until getting the urge to move on.
“After three years, I wanted to expand my horizons,” she says. “I
loved it there, but I was thinking, ‘How do I move up from here?’” e answer to that question was Acre. “What drew me to
“I’ve been working on a pumpkincurry-rum drink, kind of like a pumpkin-curry daiquiri … I’m thinking of calling it ‘Harvest Moon.’ What do you think?” — Lili Clark
Acre was the fact that I would get to create the menu,” Clark says. “Wally views the cocktail menu as the bar manager’s thing. When we change it, we’ll do a tasting and he’ll say what he thinks, but he respects and trusts what you do. I feel like I have something of my own here.”
Like most bartenders I’ve interviewed, Clark understands that the trade involves some performance-art. “You’re definitely taking on a role of sorts,” she says, “but I feel like it’s authentically me. I sing and play music with the windows down on the way to work. It gets me going and kind of gets me in my groove, so I can intuitively move forward into the night ahead.”
Having been tipped off that she would be asked to make me a drink, Clark is ready with a surprise: “I was thinking I might do one for you that’s going to be on my fall menu,” she says. “I’ve been working on a pumpkin-curry-rum drink, kind of like a pumpkin-curry daiquiri.”
“Well … that’s definitely a new one for me,” I say.
“I try to use stuff that might take you by surprise, something that not everyone else is doing.”

“A pumpkin-curry daiquiri? I’d say you’ve succeeded.”
“I’d never worked with pumpkin before,” she says, “and when you think of pumpkin spice you don’t think of pumpkin curry, but it’s pretty common in Indian cuisine. You should know, you will be the first customer to taste one.”
“I’m honored,” I say, as Clark sets the cocktail on the bar. And it is a lovely drink, indeed, with a dance of flavors — herbs, spice, rum, cardamom — none of which overpower the sense
that you’re having a real cocktail. I would order one of these.
“ is is delightful,” I say. “And unexpected.”
“ at’s what I try to do,” she says. “Give you an unexpected flavor. It’s got Angostura rum, pumpkin-curry cordial, cardamom syrup, lime juice, and Montenegro Amaro. And the rosemary garnish gives it a nice aromatic touch. I’m thinking of calling it ‘Harvest Moon.’ What do you think?”
“I think that’s just perfect.”
Acre is located at 690 S. Perkins Road.


Memphis Magazine offers this curated restaurant listing as a service to our readers. Broken down alphabetically by neighborhoods, this directory does not list every restaurant in town. It does, however, include the magazine’s “Top 50” choices of must-try restaurants in Memphis, a group that is updated every August. Establishments open less than a year are not eligible for “Top 50” but are noted as “New.” is guide also includes a representative sampling of other Bluff City eating establishments. No fast-food facilities or cafeterias are listed. Restaurants are included regardless of whether they advertise in Memphis Magazine; those that operate in multiple locations are listed under the neighborhood of their original location. is guide is updated regularly, but we recommend that you call ahead to check on hours, prices, or other details. Suggestions from readers are welcome: dining@memphismagazine.com.
ALDO’S PIZZA PIES—Serving gourmet pizzas — including Mr. T Rex — salads, and more. Also 30 beers, bottled or on tap. 100 S. Main. 577-7743; 752 S. Cooper. 725-7437. L, D, $-$$
AMELIA GENE’S—Globally inspired fine-dining cuisine at the One Beale project, including Rohan duck, Wagyu filet, and an extensive cheese cart. 255 S. Front. 686-5051. D, $$-$$$
THE ARCADE—Possibly Memphis’ oldest cafe. Specialties include sweet potato pancakes, a fried peanut butter and banana sandwich, and breakfast served all day. 540 S. Main. 526-5757. B, L, D (Thurs.-Sat.), MRA, $
ARNOLD’S SMOKEHOUSE—A classic smokehouse with vegan and nonvegan options seasoned to perfection. Closed Mon. 2019 E. Person Ave. 922-5950. L, D, SB, $-$$$
AUTOMATIC SLIM’S—Longtime downtown favorite specializes in contemporary American cuisine emphasizing local ingredients; also extensive martini list. 83 S. Second. 525-7948. L, D, WB, MRA, $-$$$
BARDOG TAVERN—Classic American grill with Italian influence, Bardog offers pasta specialties such as Grandma’s NJ Meatballs, as well as salads, sliders, sandwiches, and daily specials. 73 Monroe. 275-8752. B (Mon.-Fri.), L, D, WB, MRA, $-$$
BELLE TAVERN—Serving elevated bar food, including a butcher board with a variety of meats and cheeses, as well as daily specials. 117 Barboro Alley. 249-6580. L (Sun.), D, MRA, $
BEN YAY’S GUMBO SHOP—Spiritual successor to DejaVu, offering fresh and authentic Creole staples. 51 S. Main St., 779-4125. L, D, $-$$
this Italian restaurant in the Chisca. 272 S. Main. 254-8600. D, SB, MRA, $-$$$
CHEZ PHILIPPE—Classical/contemporary French cuisine with Asian and Nordic influences, presented in a luxurious atmosphere with seasonal tasting menus from chef Keith Clinton. Afternoon tea served Thu.-Sun., noon-3:30 p.m. (reservations required). Closed Sun.Tues. The Peabody, 149 Union. 529-4188. D, MRA, $$$$
CIMAS—It’s breakfast tacos, shrimp and grits, chilaquiles verdes, and plenty of other Southern and Latin-American twists at the Hyatt Centric. 33 Beale St. 444-3232. B, L, D, $-$$$
COCOZZA AMERICAN ITALIAN—”The red sauce joint of your dreams” serves up classic Italian-American fare from the owners of Majestic Grille. Closed Sun. 110 Harbor Town Sq. 609-1111. D, $-$$
COZY CORNER—Serving up ribs, pork sandwiches, chicken, spaghetti, and more; also homemade banana pudding. Closed Mon. 735 N. Parkway. 527-9158. L, D, $
DINING SYMBOLS
B — breakfast
L — lunch
D — dinner
SB — Sunday brunch
WB — weekend brunch
MRA — member, Memphis Restaurant Association
$ — under $15 per person without drinks or desserts
$$ — under $25
$$$ — $26-$50
$$$$ — over $50
BISCUITS & JAMS—Offering sweet and savory brunch with a Cajun flare. Specialties include smoked sausage or spicy fried chicken on biscuits, lemon blueberry waffles, and rum custard French toast. No walk-ins on weekends. 24 N. B.B. King Blvd. 672-7905. B, L, WB, $-$$
BRASS DOOR IRISH PUB—Irish and New-American cuisine includes such entrees as fish and chips, burgers, shepherd’s pie, all-day Irish breakfast, and more. 152 Madison. 572-1813. L, D, SB, $-$$ BY THE BREWERY—Breakfast and lunch café, with a focus on Southern-style biscuits, salads, and soups. 496 Tennessee St. 310-4341. B, L, $
CAFE KEOUGH—European-style cafe serving quiche, paninis, salads, and more. 12 S. Main. 509-2469. B, L, D, $
CAPRICCIO GRILL ITALIAN STEAKHOUSE—Offers prime steaks, fresh seafood (lobster tails, grouper, mahi mahi), pasta, and several Northern Italian specialties. 149 Union, The Peabody. 529-4199. B, L, D, SB, MRA, $-$$$$
CAROLINA WATERSHED—This indoor/outdoor eatery, set around silos, features reimagined down-home classics, including fried green tomatoes with smoked catfish, a buttermilk fried chicken sandwich, burgers, and more. Closed Mon.-Thurs. 141 E. Carolina. 321-5553. L, D, WB, $-$$
CATHERINE & MARY’S—A variety of pastas, grilled quail, pâté, razor clams, and monkfish are among the dishes served at
CURFEW—An elevated sports bar/American tavern concept by Top Chef contestant Fabio Viviani at the Canopy Memphis Downtown hotel. 164 Union Ave. B, L, D, $-$$
DOS HERMANOS KITCHEN—Breakfast and lunch concept by Eli Townsend in the Cossitt Library. 33 S. Front. 286-2399. B, L, $
ESCO RESTAURANT AND TAPAS
Shareable dishes, turkey ribs, and seafood mac’n’cheese at this 2 Chainz franchise. 156 Lt. George W. Lee Ave. 808-3726. L, D, $$-$$$
FEAST & GRAZE—Whipped goat toast, open-faced grilled cheese, and other local pantry snacks and charcuterie boards. Closed Sun./Mon. 55 S. Main. 654-5926. L, $
FERRARO’S CHEESY CORNER & PIZZERIA
Plenty of pizzas, along with a whole new cheese-inspired menu (fancy grilled cheeses and build-your-own mac and cheese bowls). 111 Jackson. 522-2033. L, D, $
FISHBOWL AT THE PYRAMID—Burgers, fish dishes, sandwiches, and more served in a unique “underwater” setting. Bass Pro, 1 Bass Pro Drive, 291-8000. B, L, D, $-$$
FLAME RAMEN—Traditional Japanese ramen restaurant serving up bowls of noodles. 61 S. Second St. 441-6686. L, D, wheelchair accessible, $-$$
FLIGHT RESTAURANT & WINE BAR—Steaks and seafood, with such specialties as bison ribeye and Muscovy duck, all matched with appropriate wines. 39 S. Main. 521-8005. D, SB, MRA, $-$$$
FLYING FISH—Serves up fried and grilled versions of shrimp, crab, oysters, fish tacos, and catfish; also chicken and burgers. 105 S. Second. 522-8228. L, D, $-$$
GARDEN BRUNCH CAFÉ—Fish and grits, steak and eggs, and other upscale takes on Southern brunch classics. 492 S. Main St. 249-7450. B, L, $$
GOOD FORTUNE CO.—Authentic handcrafted noodles, ramen, and dumplings. 361 S. Main. 561-306-4711. L, D, $-$$
THE GENRE—Burgers, tenders, catfish, and plenty of vegan options made to order at this music-themed restaurant/lounge. 200 Poplar, Suite 105. 410-8169. B, L, D, $-$$
THE GOURMET GALLERY—A variety of elevated comfort dishes, like fried ribs and waffles, shrimp and grits, grilled salmon, and more. Closed Mon. 412 S. Main St. 848-4691. L, D, $-$$$
GROOVY GRATITUDE—Offers a vibrant selection of cold-pressed juices, handcrafted smoothies, and healthy eats like paninis and acai bowls. Closed Sun. 605 N. Second St. 417-8007. B, L, WB, $
GUS’S WORLD FAMOUS FRIED CHICKEN—Serves chicken with signature spicy batter, along with homemade beans, slaw, and pies. 310 S. Front. 527-4877; 3100 Forest Hill Irene (Germantown). 8536005; 2965 N. Germantown Pkwy. (Cordova). 373-9111; 730 S. Mendenhall. 767-2323; 505 Highway 70 W., Mason, TN. 901-294-2028. L, D, MRA, $
HAPPY MEXICAN—Quesadillas, burritos, chimichangas, vegetable and seafood dishes, and more. 385 S. Second. 529-9991; 6080 Primacy Pkwy. 683-0000; 7935 Winchester. 751-5353. L, D, $
HIVE BAGEL & DELI Bagels, bagels, and more bagels at this new downtown deli offering baked goods, sandwiches, and salads. Closed Mon./Tue. 276 S. Front St. 509-2946. B, L, $ HU. ROOF—Rooftop cocktail bar serves toasts with a variety of toppings including beef tartare with cured egg, cognac, and capers or riced cauliflower with yellow curry, currants, and almonds. Also salads, fish tacos, and boiled peanut hummus. 79 Madison. 333-1229. D, $ HUSTLE & DOUGH BAKERY & CAFE—Flaky, baked breakfast goodness every day with fresh pastries, sandwiches, and more at Arrive Hotel. 477 S. Main St., 701-7577. B, L, $
IBIS—Upscale cocktail bar serving sharable small plates, including lobster rolls, crab cakes, and lamb meatballs, alongside select larger entrees. Closed Mon.-Wed. 314 S. Main. 748-5187. D, $-$$
INKWELL—Unique craft concoctions, charcuterie plates, flatbreads, and sandwiches at this dope cocktail bar. Closed Mon.-Tue. 631 Madison Ave. 334-9411. D, $-$$
ITTA BENA—Southern and Cajun-American cuisine served here, located above B.B. King’s Blues Club on Beale St.; specialties are duck and waffles and shrimp and grits, along with steaks, chops, seafood, and pasta. 145 Beale St. 578-3031. D, MRA, $$-$$$
JEM DINING—Chef Josh Mutchnick offers a dining experience that’s memorable, refined, unpretentious, and welcoming with dishes from around the world. Closed Sun./Mon./Tue. 644 Madison Ave. 286-1635. D, $$-$$$
KINFOLK—Breakfast with a side of nostalgia in Harbor Town. Specialties include biscuit sandwiches, steak and omelet plate, and brown butter mushrooms with jammy egg over grits. 111 Harbor Town Square. 457-5463. B, L, SB, WB, $-$$
KING & UNION BAR GROCERY—Classic Southern favorites including catfish plate, pimento cheese, po-boys, chicken & waffles. Open for breakfast, lunch, and dinner with cocktails served with flair and favorite Memphis beers. Locally made confections available in the grocery. 185 Union Ave. 523-8500. B, L, D, $-$$
KOOKY CANUCK—Offers prime rib, catfish, and burgers, including the 4-lb. “Kookamonga”; also late-night menu. 87 S. Second. 578-9800; 1250 N. Germantown Pkwy. 1-800-2453 L, D, MRA, $-$$$
LITTLE BETTIE—New Haven-style pizzas and snacks from the AndrewMichael team at Wiseacre’s Downtown location. 398 S. B.B. King Blvd. 334-9411. L, D, $-$$
THE LOBBYIST AT THE CHISCA—Chef Jimmy Gentry brings his farm-to-table ideas downtown, with seasonal, and sometimes weekly, new menus, and an emphasis on creative vegetable dishes. Closed Sun. 272 S. Main St., Suite 101. 249-2170. D, $$-$$$$
LOCAL—Entrees with a focus on locally sourced products include lobster mac-and-cheese and rib-eye patty melt; menu differs by location. 95 S. Main. 473-9573. L, D, WB, $-$$
LOFLIN YARD—Beer garden and restaurant serves vegetarian fare and smoked-meat dishes, including beef brisket and pork tenderloin, cooked on a custom-made grill. Closed Mon.-Tues. 7 W. Carolina. 249-3046. L (Sat. and Sun.), D, MRA, $-$$
THE LOOKOUT AT THE PYRAMID—Serves seafood and Southern fare, including cornmeal-fried oysters, sweet tea brined chicken, and elk chops. 1 Bass Pro Dr. 620-4600/291-8200. L, D, $-$$$
LUNA RESTAURANT & LOUNGE—Serving a limited menu of breakfast and lunch items. Dinner entrees include citrus glaze salmon and Cajun stuffed chicken. 179 Madison (Hotel Napoleon). 526-0002. B, D (Mon.-Sat.), $-$$$
MACIEL’S—Entrees include tortas, fried taco plates, quesadillas, chorizo and pastor soft tacos, salads, and more. Closed Sun. 45 S. Main. 526-0037, MRA, $
THE MAJESTIC GRILLE—Features aged steaks, fresh seafood, and such specialties as roasted chicken and grilled pork tenderloin; offers a pre-theater menu and classic cocktails. Well-stocked bar. 145 S. Main. 522-8555. L, D, WB, MRA, $-$$$
McEWEN’S—Southern/American cuisine with international flavors; specialties include steak and seafood, sweet potato-crusted catfish with macaroni and cheese, and more. Closed Sun., Monroe location. 120 Monroe. 527-7085; 1110 Van Buren (Oxford). 662-234-7003. L, D, SB (Oxford only), MRA, $$-$$$
MESQUITE CHOP HOUSE—The focus here is on steaks, including prime fillet, rib-eyes, and prime-aged New York strip; also, some seafood options. 5960 Getwell (Southaven). 662-890-2467; 88 Union. 5275337. 249-5661. D, SB, $$-$$$
MOLLIE FONTAINE LOUNGE—Specializes in tapas (small plates) featuring global cuisine. Closed Sun.-Tues. 679 Adams Ave. 524-1886. D, MRA, $
MOMMA’S ROADHOUSE—This diner and dive at Highway 55 serves up smoked wings, burgers, and beer, among other solid bar-food options 855 Kentucky. 207-5111. L, D, MRA, $
THE NINE THAI & SUSHI—Serving authentic Thai dishes, including curries, as well as a variety of sushi rolls. Closed for lunch Sat. and Sun. 121 Union. 208-8347. L, D, $-$$
PAPER PLATE PAVILION—Popular food truck serves up brisket mac and cheese and more favorites at Tom Lee Park. Riverside Dr. L, $-$$
PAULETTE’S—Presents fine dining with a Continental flair, including such entrees as filet Paulette with butter cream sauce and crabmeat and spinach crepes; also changing daily specials and great views. River Inn. 50 Harbor Town Square. 260-3300. B, L, D, WB, MRA, $-$$$
PLANT BASED HEAT EXPRESS—Flavorful, 100% vegan meals, including plants, plant-based meat, and kid’s meals. No reservations. Closed Sun. 363 S. Front St. 570-5339. L, D, $-$$
PRETTY TACO Fast casual tacos with a Memphis twist, like the Soul Burger tacos. Closed Sun./Mon. 265 S. Front St. 509-8120. L, D, $-$$
PROMISE South Main soul food restaurant (think turkey necks, meatloaf, fried catfish) using old family recipes. Closed Sun./Mon. 412 S. Main. L, D, $-$$
RENDEZVOUS, CHARLES VERGOS’—Menu items include barbecued ribs, cheese plates, skillet shrimp, red beans and rice, and Greek salads. Closed Sun.-Mon. 52 S. Second. 523-2746. L (Fri.Sat.), D, $-$$
ROCK’N DOUGH—A blend of Italian and American foods like artisan pizza, salads, pasta, burgers, and house-brewed beers. 704 Madison Ave. 587-6256. L, D, $-$$
SABOR CARIBE—Serving up “Caribbean flavors” with dishes from Colombia, Venezuela, Puerto Rico, and Cuba. Closed Sunday. 662 Madison. 949-8100. L, D, $
SAGE—Restaurant and lounge features daily lunch specials and tapas with such dishes as braised short ribs, teriyaki pulled pork, and the Sage burger made with Angus beef, avocado mash, fried egg, and flash-fried sage. 94 S. Main. 672-7902. L, D, WB, $-$$
SILLY GOOSE LOUNGE—Gourmet, wood-fired pizzas and handcrafted cocktails at this downtown restaurant and lounge. 150 Peabody Place, Suite 111. 435-6915. L, D, $
SMURFEY’S SMOKEHOUSE—The beloved food truck has found a permanent home for their famous loaded nachos and fries with plans of adding breakfast soon. Closed Sun. and Mon. 149 Madison Ave. 337-7966. L, D, $-$$
SOUTH MAIN SUSHI & GRILL—Serving sushi, nigiri, and more. 520 S. Main. 249-2194. L, D, $
SOB—Elevated gastropub that serves favorites like general Tso’s cauliflower or duck fried rice. 345 S. Main. 526-0388; 5040 Sanderlin (East Memphis). 818-0821; 1329 W. Poplar Ave. 286-1360. L, D, WB, $-$$
SOUTH POINT GROCERY—Fresh and delicious sandwiches made to order at Downtown’s new grocery market. 136 Webster Ave. B, L, D, $
SUGAR GRITS—Who said breakfast has to be in the morning? The Westmorelands offer grits and other breakfast goodness all day long, in addition to other Southern-style lunch and dinner options. 150 Peabody Pl., Suite 111. 249-5206. B, L, D, $-$$
SUNRISE MEMPHIS—Serves breakfast all day, including house-made biscuits, frittatas, kielbasa or boudin plates, and breakfast platters. 670 Jefferson. 552-3144; 5469 Poplar Ave. (East Memphis). 844-6117. B, L, MRA, $








TALK SHOP—Southern-style cuisine, a breakfast bar, and plenty of other cool dishes and drinks at the Caption by Hyatt. 245 S. Front St. B, L, D, $-$$
TERRACE—Creative American and Continental cuisine includes such dishes as filet mignon, beef or lamb sliders, chicken satay, and mushroom pizzetta. Rooftop, River Inn of Harbor Town, 50 Harbor Town Square. 260-3366. D, MRA, $$
TEXAS DE BRAZIL—Serves beef, pork, lamb, and chicken dishes, and Brazilian sausage; also a salad bar with extensive toppings. 150 Peabody Place, Suite 103. 526-7600. L (Wed.-Fri.), D, WB, $$-$$$ THE GARDEN BRUNCH CAFÉ—Leaving their Nashville roots, a unique and healthy brunch spot in the heart of downtown. Closed Mon.—Thurs. 492 S. Main St. 249-7450. B, SB, WB, $-$$$
TUG’S—Famous for New Orleans gumbo, fabulous burgers, fried thin catfish, and specialty pancakes. Now serving Grisanti Crafted Pizza. 51 Harbor Town Square. 260-3344. B, L, D, WB, $$-$$$ WAHLBURGERS WILD—Wahlburgers brings its classic menu, but with a few gamey twists at the Bass Pro Pyramid. 1 Bass Pro Drive. B, L, D, $-$$
WESTY’S—Extensive menu includes a variety of wild rice dishes, sandwiches, plate lunches, and hot fudge pie. 346 N. Main. 543-3278. L, D, $
WINGMAN—Downtown lounge and hookah bar offering wings galore with ten signature sauces, and plenty of other goodies. 143 Madison Ave. L, D, WB, $-$$
MIDTOWN (INCLUDES THE MEDICAL CENTER)
ABNER’S FAMOUS CHICKEN—Fried chicken tenders and dipping sauces galore at this Mid-South staple. 1350 Concourse Ave, Suite 137. 425-2597; (East Memphis) 1591 Poplar Ave. 509-3351; (Cordova) 1100 N. Germantown Pkwy. 754-5355. L, D, $-$$
ABYSSINIA RESTAURANT—Ethiopian/Mediterranean menu includes beef, chicken, lamb, fish entrees, and vegetarian dishes; also a lunch buffet. 2600 Poplar. 321-0082. L, D, $-$$
ALCHEMY / SALT|SOY—Handcrafted cocktails and local craft beers with the Asian fusion dining concept from Salt|Soy. 940 S. Cooper. 726-4444. D, SB, $-$$
ART BAR—Inventive cocktails feature locally foraged ingredients; snacks include house-cured salt & vinegar potato chips and herb-roasted olives. Closed Mon. 1350 Concourse Avenue #280. 507-8030. D, $
ASHTAR GARDEN—Southern twists on classic brunch dishes, and plenty of cocktails. Closed Mon.-Wed. 898 Cooper St. 4431514. L, D, $-$$
BABALU TACOS & TAPAS—Spanish-style tapas with Southern flair; also taco and enchilada of the day; specials change daily. 2115 Madison. 274-0100; 6450 Poplar, 410-8909. L, D, SB, MRA, $-$$ BACK DO / MI YARD—A revamped patio space behind The Beauty Shop features rotisserie meats and fishes via Brazilian-style outdoor grill. Dinner Wed.-Sat., weather permitting. 966 S. Cooper, 272-7111. D, $$ BAIN BARBECUE & BAKERY—Brian Bain’s popular Texas-style barbecue is back, alongside an assortment of baked goods. 993 S. Cooper. 310-4141. B, L, $-$$
BAR DKDC—Features an ever-changing menu of international “street food,” from Thai to Mexican, Israeli to Indian, along with specialty cocktails. 964 S. Cooper. 272-0830. D, MRA, $
BAR KEOUGH—It’s old-school eats and cocktails at the new CooperYoung neighborhood corner bar by Kevin Keough. 247 Cooper St. D, $
BAR-B-Q SHOP—Dishes up barbecued ribs, spaghetti, bologna, other classics. Closed Sun. 1782 Madison. 272-1277. L, D, MRA, $-$$
BARI RISTORANTE ENOTECA—Authentic Southeastern Italian cuisine (Puglia) emphasizes lighter entrees. Serves fresh fish and beef dishes and a homemade soup of the day. 524 S. Cooper. 722-2244. D, SB, MRA, $-$$$
BARKSDALE RESTAURANT—Old-school diner serving breakfast and Southern plate lunches. 237 S. Cooper. 722-2193. B, L, D, $ BAYOU BAR & GRILL—New Orleans fare at this Overton Square eatery includes jambalaya, gumbo, catfish Acadian, shrimp dishes, red beans and rice, and muffalettas. 2094 Madison. 278-8626. L, D, WB, MRA, $-$$
BEAUTY SHOP—Modern American cuisine with international flair served in a former beauty shop. Serves steaks, salads, pasta, and seafood, including pecan-crusted golden sea bass. Perennial “Best Brunch” winner. Closed for dinner Sunday. 966 S. Cooper. 272-7111. L, D, SB, MRA, $-$$$
BOSCOS—Tennessee’s first craft brewery serves a variety of freshly brewed beers as well as wood-fired oven pizzas, pasta, seafood, steaks,
and sandwiches. 2120 Madison. 432-2222. L, D, SB (with live jazz), MRA, $-$$
BROADWAY PIZZA—Serving a variety of pizzas, including the Broadway Special, as well as sandwiches, salads, wings, and soul-food specials. 2581 Broad. 454-7930; 627 S. Mendenhall. 207-1546. L, D, $-$$
CAFE 1912—French/American bistro owned by culinary pioneer Glenn Hays serving such seafood entrees as seared sea scallops with charred cauliflower purée and chorizo cumin sauce; also crepes, salads, and onion soup gratinée. 243 S. Cooper. 722-2700. D, SB, MRA, $-$$$
CAFE ECLECTIC—Omelets and chicken and waffles are among menu items, along with quesadillas, sandwiches, wraps, and burgers. Menu varies by location. 603 N. McLean. 725-1718; 111 Harbor Town Square. 590-4645. B, L, D, SB, MRA, $
CAFE OLÉ—This eatery specializes in authentic Mexican cuisine; one specialty is the build-your-own quesadilla. 959 S. Cooper. 343-0103. L, D, SB, MRA, $-$$
CAFE PALLADIO—Serves gourmet salads, soups, sandwiches, and desserts in a tea room inside the antiques shop. Closed Sun. 2169 Central. 278-0129. L, $
CAMEO—Three longtime Memphis bartenders join forces for creative cocktails, cheese boards, snacks, and Sunday brunch. 1835 Union Ave., Suite 3. 305-6511. D, SB, $-$$
CELTIC CROSSING—Specializes in Irish and American pub fare. Entrees include shepherd’s pie, shrimp and sausage coddle, and fish and chips. 903 S. Cooper. 274-5151. L, D, WB, MRA, $-$$
CENTRAL BBQ—Serves ribs, smoked hot wings, pulled pork sandwiches, chicken, turkey, nachos, and portobello sandwiches. Offers both pork and beef barbecue. 2249 Central Ave. 272-9377; 4375 Summer Ave. 767-4672; 147 E. Butler. 672-7760 ; 6201 Poplar. 4177962. L, D, MRA, $-$$
COMPLICATED PILGRIM—Quick-serve coffee shop, bar, and restaurant all in one at The Memphian hotel. 21 S. Cooper St. 538-7309. B, L, D, $-$$
THE COVE—Nautical-themed restaurant and bar serving oysters, pizzas, and more. The Stoner Pie, with tamales and fritos, is a popular dish. 2559 Broad. 730-0719. L, D, $
THE CRAZY NOODLE—Korean noodle dishes range from bibam beef noodle with cabbage, carrots, and other vegetables, to curry chicken noodle; also rice cakes served in a flavorful sauce. Closed for lunch Sat.-Sun. 2015 Madison. 272-0928. L, D, $
ECCO—Mediterranean-inspired specialties range from rib-eye steak to seared scallops to housemade pastas and a grilled vegetable plate; also a Saturday brunch. Closed Sun.-Mon. 1585 Overton Park. 410-8200. B, L, D, $-$$
EVELYN & OLIVE—Jamaican/Southern fusion cuisine includes such dishes as Kingston stew fish, Rasta Pasta, and jerk rib-eye. Closed for lunch Sat. and all day Sun.-Mon. 150 N. Avalon St. 748-5422. L, D, $
EVERGREEN GRILL—Serving classic American cuisine like patty melts, burgers, phillies, and more to bring you the comforting taste of home. Closed Mon./Tue. 212 N. Evergreen St. 779-7065. L, D, X,$$-$$$
FABIOLA’S KITCHEN—Longtime caterer Fabiola Francis serves up burgers, tacos, fish, and much more. 1353 Jackson Ave. B, L, $ FARM BURGER—Serves grass-fed, freshly ground, locally sourced burgers; also available with chicken, pork, or veggie quinoa patties, with such toppings as aged white cheddar, kale coleslaw, and roasted beets. 1350 Concourse Avenue, Suite 175. 800-1851. L, D, $
THE FARMER AT RAILGARTEN—Farmer classics include panseared catfish, gulf shrimp and grits, or a Gibson donut bread pudding. Closed Mon./Tue. 2166 Central. 313-0087. D, $-$$
FINO’S FROM THE HILL—Italian deli offers old favorites such as the Acquisto as well as a new breakfast menu. Germantown location paired with Happy Glaze Donuts. 1853 Madison. 272-FINO; 7781 Farmington Blvd. (Germantown). B, L, D, $
FLAME RAMEN—Traditional Japanese ramen restaurant serving up bowls of noodles in Midtown. 1838 Union Ave. 779-8666; 61 S. Second St., Suite 160 (downtown). D, $-$$
FLIP SIDE—Pinball meets pub in the Crosstown neighborhood, with plenty of games alongside a Caribbean- and Latin-inspired menu. Closed Mon. 1349 Autumn Ave. 207-6193. L, D, $-$$
FRIDA’S—Mexican cuisine and Tex-Mex standards, including chimichangas, enchiladas, and fajitas; seafood includes shrimp and tilapia. 1718 Madison. 244-6196. L, D, $-$$
GLOBAL CAFÉ—This international food hall hosts three immigrant/ refugee food entrepreneurs serving Venezuelan, Sudanese, and Syrian cuisines. Samosas, shawarma, and kabobs are among the menu items. Closed Mon. 1350 Concourse Avenue, Suite 157. L, D, MRA, $
GOLDEN INDIA—Northern Indian specialties include tandoori chicken as well as lamb, beef, shrimp, and vegetarian dishes. 2097 Madison. 728-5111. L, D, $-$$
GOOD GROCERIES MARKET & CAFÉ—Providing fresh, healthy, cruelty-free meals, Good Groceries offers a classic American menu with a twist: instead of pork, they use duck for their BBQ. They also sell quesadillas, mac-and-cheese, sandwiches, and more. Closed Sun. 585 S. Cooper St. 325-1269. B, L, D, $
GROWLERS—Sports bar and eatery serves standard bar fare in addition to pasta, tacos, chicken and waffles, and light options. 1911 Poplar. 244-7904. L, D, $-$$
GUAC FRESH MEX—Authentic Mexican cuisine and four types of guacamole. Closed Sun. 782 Washington Ave. 587-4100. L, D, $ HATTIE B’S—Fried chicken spot features “hot chicken” with a variety of heat levels; from no heat to “shut the cluck up” sauce. Sides include greens, pimento mac-and-cheese, and black-eyed pea salad. 596 S. Cooper. 424-5900. L, D, $
HUEY’S—This family-friendly restaurant offers 13 different burgers, a variety of sandwiches, and delicious soups and salads. 1927 Madison. 726-4372; 1771 N. Germantown Pkwy. (Cordova). 7543885; 77 S. Second (downtown). 527-2700; 2130 W. Poplar (Collierville). 854-4455; 7090 Malco Blvd. (Southaven). 662-349-7097; 7825 Winchester. 624-8911; 4872 Poplar. 682-7729; 7677 Farmington Blvd. (Germantown). 318-3030; 8570 Highway 51 N. (Millington). 873-5025. L, D, MRA, $
IMAGINE VEGAN CAFE—Dishes at this fully vegan restaurant range from salads and sandwiches to full dinners, including eggplant parmesan and “beef” tips and rice; breakfast all day Sat. and Sun. 2158 Young. 654-3455. L, D, WB, $
INDIA PALACE—Tandoori chicken, lamb shish kabobs, and chicken tikka masala are among the entrees; also, vegetarian options and a daily all-you-can-eat lunch buffet. 1720 Poplar. 278-1199. L, D, $-$$
INSPIRE COMMUNITY CAFE—Serving breakfast all day, in addition to quesadillas, rice bowls, and more for lunch and dinner. 510 Tillman, Suite 110. 509-8640. B, L, D, $
JACK BROWN’S BEER AND BURGER JOINT—Another spot to satisfy your burger craving, this time with 100% American Wagyu beef. 2197 Central Ave. 512-6957. L, D, $-$$$
KNIFEBIRD—Neighborhood wine bar boasts plenty of flights, cocktails, and mocktails alongside bruschetta and charcuterie boards. Closed Sun. 2155 Central Ave. 748-5425. D, $-$$$
LAFAYETTE’S MUSIC ROOM—Serves such Southern cuisine as po’boys, shrimp and grits, and wood-fired pizzas. 2119 Madison. 2075097. L, D, WB, MRA, $-$$
LOS COMALES—Authentic Mexican cuisine, daily specials, and strong margaritas. 1322 Madison. 440-8393; 345 Madison Ave. (downtown). 590-4524; 2860 S. Perkins (East Memphis). 369-0528. L, D, $-$$ THE LIQUOR STORE—Renovated liquor store turned diner serves all-day breakfast, sandwiches, and entrees such as Salisbury steak and smothered pork chops. 2655 Broad. 405-5477; 669 S. Mendenhall Rd. (East Memphis). B, L, D, $-$$
LOUIS CONNELLY’S BAR FOR FUN TIMES & FRIENDSHIP—An upgraded dive bar with a neighborhood feel and a rockin’ SMASH burger. Closed Sun. and Mon. 322 S. Cleveland St. 433-9582. L, D, $-$$
MADISON TAVERN—Indoor and outdoor seating available, plus a full menu with a range of comfort foods and drinks on tap. 2126 Madison Ave. 417-8029. L, D, $-$$$
MARY’S B.O.T.E.—This bar of tropical escapism offers over 30 specialty drinks, pizzas, bar snacks, and a cozy interior that transports customers to the beach. 21+ only. Closed Mon. 588 S. Cooper St. No phone number. D, wheelchair accessible, $
MEMPHIS PIZZA CAFE—Homemade pizzas are specialties; also serves sandwiches, calzones, and salads. 2087 Madison. 726-5343; 5061 Park Ave. 684-1306; 7604 W. Farmington (Germantown). 7532218; 797 W. Poplar (Collierville). 861-7800; 5627 Getwell (Southaven). 662-536-1364. L, D, $-$$
MEMPHIS TOAST—Provides authentic Memphian breakfast cuisine and features themed rooms to honor iconic Memphis figures. Specialties include French toast, shrimp and grits, and their little Lucille breakfast burrito. 954 Jackson Ave. 417-7817. B, L, WB, $-$$
MEMPHIS WHISTLE—Cocktails, cocktails, and even more delicious cocktails alongside burgers, sandwiches, and other tasty snacks. 2299 Young Ave. Closed Mon.-Tue. 236-7136. D, $-$$
MOLLY’S LA CASITA—Homemade tamales, fish tacos, a vegetarian combo, and bacon-wrapped shrimp are a few of the specialties. 2006 Madison. 726-1873. L, D, MRA, $-$$
PAYNE’S BAR-B-QUE—Opened in 1972, this family-owned barbecue joint serves ribs, smoked sausage, and chopped pork sandwiches with a standout mustard slaw and homemade sauce. About as down-to-earth as it gets. 1762 Lamar. 272-1523. L, D, $-$$
PETALS OF A PEONY—Authentic Chinese restaurant serving chicken, fish, tofu, and more, smothered in spicy sauces. 2110 Madison Ave. 207-6680. L, D, $-$$$
THE PUBLIC BISTRO—Knifebird owners’ full-service American bistro with a menu by chef Gannon Hamilton. 937 S. Cooper St. Closed Sun. 509-2113. D, $-$$
ROBATA RAMEN & YAKITORI BAR—Serves ramen noodle bowls and Yakitori skewers as well as rice and noodle dishes. 2116 Madison. 410-8290. L, D, $
SALTWATER CRAB—Offers an array of seafood dishes including boils with blue crab, crab legs, lobster tails, and more, and specialty sushi like the Dynamite or Royal King rolls, in addition to signature sangrias and cocktails. 2059 Madison Ave. 922-5202. L, D, $$
THE SECOND LINE—Kelly English brings “relaxed Creole cuisine” to his newest eatery; serves a variety of po’boys and such specialties as barbecue shrimp, andouille shrimp, and pimento cheese fries. 2144 Monroe. 590-2829. L, D, WB, $-$$
SEKISUI—Japanese fusion cuisine, fresh sushi bar, grilled meats and seafood, California rolls, and vegetarian entrees. Poplar/ Perkins location’s emphasis is on Pacific Rim cuisine. Menu and hours vary at each location. 25 Belvedere. 725-0005; 1884 N. Germantown Pkwy. (Cordova). 309-8800; 4724 Poplar. 767-7770; 2130 W. Poplar (Collierville). 854-0622; 2990 Kirby-Whitten (Bartlett). 377-2727; 6696 Poplar. 747-0001. L, D, $-$$$
SEN TRANG—Serving a wide variety of Chinese and Vietnamese soups, stir-fries, and noodles. 1615 Madison Ave. 276-0006. L, D, wheelchair accessible, $-$$
SHROOMLICIOUS MEALS—Vegan eatery with a heavy blend of (as the name implies) mushrooms. Closed Mon. and Tues. 394 N. Watkins St. 205-8413. L, D, $
SLICE MIDTOWN—Serving New York-style pizza as well as subs and pasta dishes (formerly known as Little Italy). 1495 Union. 725-0280; L, D, $-$$
SMOKY CITY BBQ—Serving authentic Memphis barbeque, including burgers, ribs, wings, and daily specials. Closed Sun. 1023 Jackson Ave. 425-3115. L, D, $-$$$
SOUL FISH CAFE—Serving Southern-style soul food, tacos, and po’boys, including catfish, crawfish, oyster, shrimp, chicken, and smoked pork tenderloin. 862 S. Cooper. 725-0722; 3160 Village Shops Dr. (Germantown). 755-6988; 4720 Poplar. 590-0323. L, D, MRA, $-$$
STICKEM—Brick-and-mortar location for the popular food truck, which offers grilled meat on a stick. 1788 Madison. Closed Sunday. 474-7214. L, D, $
TEKILA MODERN MEXICAN—Mexican cuisine with a modern twist. Specialties include chicken mole, enchiladas verde, and the trio special. 1443 Union Ave. 510-5734. L, D, WB, wheelchair accessible, $-$$$
TAMBOLI’S PASTA & PIZZA—Pasta-maker Miles Tamboli whips up Italian soul food with seasonal menus featuring dishes like crispy fried chicken or creamy bucatini with pecorino cheese. Serves dinner Tues.-Sat. 1761 Madison. 410-8866. D, $-$$
TAKASHI BISTRO—Fusion restaurant with an open kitchen that lets customers watch chefs prepare a variety of Japanese and Thai cuisine. 1680 Union Ave., Suite 109. 800-2936. L, D, $-$$.
TJ MULLIGAN’S—Cold drinks, comfort food, and plenty of live entertainment. 2021 Madison. 725-0770; 1817 Kirby Pkwy. (East Memphis). 755-2481; 8070 Trinity Rd. Suite 1 (Cordova). 756-4480; 2821 N. Houston Levee Rd. (Lakeland). 377-9997. L, D, $-$$
TONICA—Paella and other Spanish-inspired dishes with an Italian touch, alongside an extensive list of gin and tonics. 1545 Overton Park. Closed Mon.-Wed. D, $-$$
TSUNAMI—Features Pacific Rim cuisine (Asia, Australia, South Pacific, etc.); also a changing “small plate” menu. Chef Ben Smith is a Cooper-Young pioneer. Specialties include Asian nachos and roasted sea bass. Closed Sunday. 928 S. Cooper. 274-2556. D, MRA, $$-$$$
TUYEN’S ASIAN BISTRO—A variety of Asian dishes from the minds and chefs behind Saigon Le. Closed Sun. 288 N. Cleveland. L, D, $-$$
VIBE FOODS—By way of Colorado, superfood bar serves up clean and delicious meals and juices. Closed Sun. 1350 Concourse Ave. 572-1127; 3139 Poplar Ave. (East Memphis). 207-2535. B, L, $-$$
ZINNIE’S—Dive bar classic reopens with a makeover and signature Zinnaloni sandwich. 1688 Madison. 726-5004. L, D, $
SOUTH MEMPHIS (INCLUDES PARKWAY VILLAGE, FOX MEADOWS, SOUTH MEMPHIS, WINCHESTER, AND WHITEHAVEN) BALA’S BISTRO—Authentic West African cuisine available to order or by the pound, alongside traditional American dishes and an extensive vegan menu. 4571 Elvis Presley Blvd. 509-3024. L, D, $-$$
CACHE 42 KITCHEN & COCKTAILS—Elevated fine dining (think golden rack of lamb or lobster queso) and cocktail lounge at MoneyBagg Yo’s restaurant; menu by chef Daris Leatherwood. Brunch and lunch options coming soon. 4202 Hacks Cross Rd., Suite 121. 494-5458. D, $-$$
COLETTA’S—Longtime eatery serves such specialties as homemade ravioli, lasagna, and pizza with barbecue or traditional toppings. 1063 S. Parkway E. 948-7652; 2850 Appling Rd. (Bartlett). 383-1122. L, D, $-$$
CURRY BOWL—Specializes in Southern Indian cuisine, serving Tandoori chicken, biryani, tikka masala, and more. Weekend buffet. 4141 Hacks Cross Rd. 207-6051. L, D, $
DELTA’S KITCHEN—The premier restaurant at The Guest House at Graceland serves Elvis-inspired dishes — like Nutella and Peanut Butter Crepes for breakfast — and upscale Southern cuisine — including lamb chops and shrimp and grits — for dinner. 3600 Elvis Presley Blvd. 443-3000. B, D, $-$$$
DWJ KOREAN BARBECUE—This authentic Korean eatery serves kimbap, barbecued beef short ribs, rice and noodles dishes, and hot pots and stews. 3750 Hacks Cross Rd., Suite 101. 746-8057; 2156 Young. 207-6204. L, D, $-$$
FABULOUS FLAVORS & FRIENDS ”The Candy Lady” Precious Thompson Jones comes up with a little bit of everything: omelettes, quesadillas, t-bones and waffles, and plenty of soul food. 2063 E. Brooks Rd. 314-0735. L, D, $
THE FOUR WAY—Legendary soul-food establishment dishing up such entrees as fried and baked catfish, chicken, and turkey and dressing, along with a host of vegetables and desserts. Around the corner from the legendary Stax Studio. Closed Mon. 998 Mississippi Blvd. 507-1519. L, D, $
HERNANDO’S HIDEAWAY No one cares how late it gets; not at Hernando’s Hideaway. Live music, killer happy hour, and plenty of bar fare at this South Memphis hang. 3210 Old Hernando Rd. 917-982-1829. L, D, $
INTERSTATE BAR-B-Q—Specialties include chopped pork-shoulder sandwiches, ribs, hot wings, spaghetti, chicken, and turkey. 2265 S. Third. 775-2304; 150 W. Stateline Rd. (Southaven). 662-393-5699. L, D, $-$$
JIM & SAMELLA’S—It’s a revolving menu of soul food delight from Chef Talbert Fleming, with anything from Southern ribs to fried tamales. 841 Bullington Ave. 265-8761. L, D, $
LEONARD’S—Serves wet and dry ribs, barbecue sandwiches, spaghetti, catfish, homemade onion rings, and lemon icebox pie; also a lunch buffet. 5465 Fox Plaza. 360-1963. L, $-$$
MARLOWE’S—In addition to its signature barbecue and ribs, Marlowe’s serves Southern-style steaks, chops, lasagna, and more. 4381 Elvis Presley Blvd. 332-4159. D, MRA, $-$$
UNCLE LOU’S FRIED CHICKEN—Featured on Diners, Drive-Ins and Dives for good reason: fried chicken (mild, hot, or home-style); jumbo burgers four patties high; strawberry shortcake, and assorted fruit pies. 3633 Millbranch. 332-2367. L, D, MRA, $ SUMMER/BERCLAIR/ RALEIGH/BARTLETT
901 HOT POT & KOREAN BBQ—All-you-can-eat hot pot and Korean BBQ, from short ribs to garlic shrimp. 2965 N. Germantown Pkwy. 512-4963. L, D, $$-$$$
BISCUITS & JAMS—Biscuits, waffles, French toast, and plenty of sharables at this Bartlett breakfast spot. Closed Mon./Tue. 5806 Stage Rd. 672-7905. B, L, $
BRYANT’S BREAKFAST—Slingin’ famous biscuits, plate lunches, chicken fried steak, and other breakfast classics since 1968. 3965 Summer Ave. 324-7494. B, L, $
CEVICHERIA AND GRILL CHILEMON—Ceviche, of course, but also plenty of other postres, aperitivos, and mixed grilled meat and seafood feasts. Closed Sun. 4509 Summer Ave. 672-7905. L, D, $
CHEF FLAVAS AND BARTLETT BREAKFAST FACTORY ”Flavaful” sandwiches, soups, pastas, and more from the makers of the popular local spinach artichoke dip. Traditional breakfast options served by Bartlett Breakfast Factory. Closed Sun./Mon. 6301 Stage Rd. 779-2200. B, L, D, $-$$
DIM SUM KING—All the best from a selection of authentic Chinese dishes: roasted duck, sizzling hot plate, Cantonese BBQ, and plenty more. 5266 Summer Ave. Suite 65. 766-0831. L, D, $-$$
ELWOOD’S SHACK—Casual comfort food includes tacos, pizza, and sandwiches. Specialties include meats smoked in-house (chicken, turkey, brisket, pork), barbecue pizza, and steelhead trout tacos. 4523 Summer. 761-9898; 4040 Park Ave. 754-2520. B, L, D, $
EXLINES’ BEST PIZZA—Serves pizza, Italian dinners, sandwiches, and salads. 6250 Stage Rd. 382-3433; 2935 Austin Peay. 388-4711; 2801 Kirby Parkway. 754-0202; 7730 Wolf River Blvd. (Germantown). 753-4545; 531 W. Stateline Rd. 662-342-4544. L, D, MRA, $
FANATIC SPORTS BAR AND WING FANATIC—Sports bar and hot wing joint folded into one, with plenty of screens to watch the big game. 2857 Appling Way. 695-3243. L, D, $-$$
LA TAQUERIA GUADALUPANA—Fajitas and quesadillas are just a few of the authentic Mexican entrees offered here. A bonafide Memphis institution. 4818 Summer. 685-6857; 5848 Winchester. 365-4992. L, D, $
LOTUS—Authentic Vietnamese-Asian fare, including lemon-grass chicken and shrimp, egg rolls, Pho soup, and spicy Vietnamese vermicelli. 4970 Summer. 682-1151. D, $
MORTIMER’S—Contemporary American entrees include trout almondine, chicken dishes, and hand-cut steaks; also sandwiches, salads, and daily/nightly specials. A Memphis landmark since the Knickerbocker closed. Closed for lunch Sat.-Sun. 590 N. Perkins. 7619321. L, D, $-$$
NAGASAKI INN—Chicken, steak, and lobster are among the main courses; meal is cooked at your table. 3951 Summer. 454-0320. D, $$
NAM KING—General Tso’s chicken, hot and sour soup, and homemade chicken wings are back at the longtime Raleigh Chinese eatery. 3624 Austin Peay Highway, Suite 3. 373-4411. L, D, $-$$
ÓRALE TACOS & BAKERY—Tacos, enchiladas, and other traditional Southern Mexican dishes alongside baked pan dulces. 2204 Whitten Rd. 571-1786. B, L, D, $-$$
PANDA GARDEN—Sesame chicken and broccoli beef are among the Mandarin and Cantonese entrees; also seafood specials and fried rice. Closed for lunch Saturday. 3735 Summer. 323-4819. L, D, $-$$
QUEEN OF SHEBA—Featuring Middle Eastern favorites and Yemeni dishes such as lamb haneeth and saltah. 4792 Summer. 207-4174. L, D, $
SIDE PORCH STEAK HOUSE—In addition to steak, the menu includes chicken, pork chops, and fish entrees; homemade rolls are a specialty. Closed Sun./Mon. 5689 Stage Rd. 377-2484. D, $-$$
TORTILLERIA LA UNICA—Individual helping of Mexican street food, including hefty tamales, burritos, tortas, and sopes. 5015 Summer Ave. 685-0097. B, L, D, $
UNIVERSITY NEIGHBORHOOD DISTRICT (INCLUDES CHICKASAW GARDENS AND HIGHLAND STRIP)
A-TAN—Serves Chinese and Japanese hibachi cuisine, complete with sushi bar. A specialty is Four Treasures with garlic sauce. 3445 Poplar, Suite 17, University Center. 452-4477. L, D, $-$$$
THE BLUFF—New Orleans-inspired menu includes alligator bites, nachos topped with crawfish and andouille, gumbo, po’boys, and fried seafood platters. 535 S. Highland. 454-7771. L, D, $-$$ BROTHER JUNIPER’S—This little cottage is a breakfast mecca, offering specialty omelets, including the open-faced San Diegan omelet; also daily specials, and homemade breads and pastries. Closed Mon. 3519 Walker. 324-0144. B, $ CELEBRITY’S SOUL FOOD—Classic soul food dishes coupled with a Hollywood-esque VIP experience. 431 S. Highland St., Suite 105. L, D, $$
CHAR RESTAURANT—Specializing in modern Southern cuisine, this eatery offers homestyle sides, charbroiled steaks, and fresh seafood. 431 S. Highland, Suite 120. 249-3533. L, D, WB, MRA, $-$$$ EL PORTON—Fajitas, quesadillas, and steak ranchero are just a few of the menu items. 2095 Merchants Row (Germantown). 754-4268; 8361 Highway 64. 380-7877; 3448 Poplar (Poplar Plaza). 452-7330; 1805 N. Germantown Parkway (Cordova). 624-9358; 1016 W. Poplar (Collierville). 854-5770. L, D, MRA, $-$$
PLANT BASED HEAT All of your favorite Southern-style recipes, but deliciously transformed into a vegan format. Specialties include the spicy fye junt burger, or the chopped ‘n’ smoked BBQ jackfruit sandwich. Closed Sun. 669 S. Highland St.; 363 S. Front St. (downtown). L, D, $
SAM’S DELI—Everything from sandwiches to bibimbap bowls at this local favorite. Closed Mon./Tue. 643 S. Highland St. 454-5582. L, D, $ EAST MEMPHIS (INCLUDES POPLAR/I-240)
ACRE—Features seasonal modern American cuisine in an avantegarde setting using locally sourced products; also small plates and enclosed garden patio. Closed for lunch Sat. and all day Sun. 690 S. Perkins. 818-2273. L, D, $$-$$$
AGAVOS COCINA & TEQUILA—Camaron de Tequila, tamales, kabobs, and burgers made with a blend of beef and chorizo are among the offerings at this tequila-centric restaurant and bar. 2924 Walnut Grove. 433-9345. L, D, $-$$
AMERIGO—Traditional and contemporary Italian cuisine includes pasta, wood-fired pizza, steaks, and cedarwood-roasted fish. 1239 Ridgeway, Park Place Mall. 761-4000. L, D, SB, MRA, $-$$$
ANDALUSIA— Authentic Moroccan cuisine, including tagines, brochettes, and briouates. 5101 Sanderlin Ave., Suite 103. 236-7784. L, D, $-$$
ANDREW MICHAEL ITALIAN KITCHEN—Traditional Italian cuisine with a menu from two of the city’s top chefs that changes seasonally with such entrees as Maw Maw’s ravioli. Closed Sun.-Mon. 712 W. Brookhaven Circle. 347-3569. D, MRA, $$-$$$
ANOTHER BROKEN EGG CAFE—Offering several varieties of eggs Benedict, waffles, omelets, pancakes, beignets, and other breakfast fare; also burgers, sandwiches, and salads. 6063 Park Ave. 729-7020; 65 S. Highland. 623-7122. B, L, WB, $
ANTIGUA MEXICAN BAR & GRILL—Tortas, tacos, and other authentic Mexican cuisine alongside freshly-made salsa, guacamole, and white queso dip. 717 N. White Station Rd. 761-1374. L, D, $-$$
BANGKOK ALLEY—Thai fusion cuisine includes noodle and curry dishes, chef-specialty sushi rolls, coconut soup, and duck and seafood entrees. Closed for lunch Sat. and all day Sun. at Brookhaven location; call for hours. 715 W. Brookhaven Circle. 590-2585; 2150 W. Poplar at Houston Levee (Collierville). 854-8748. L, D, $-$$
BELLE MEADE SOCIAL—Upscale Americana cuisine including lamb lollipops, spicy tuna stack, and steak & noodle salad. 518 Perkins Extd. 480-7054. L, D, $-$$$
BELMONT GRILL—Burgers, steak sandwiches, and other classic American fare at one of Memphis’ longstanding bars. 4970 Poplar. 767-0305. L, D, $-$$
BENIHANA—This Japanese steakhouse serves beef, chicken, and seafood grilled at the table; some menu items change monthly; sushi bar also featured. 912 Ridge Lake Blvd. 767-8980. L, D, $$-$$$
BIG BAD BREAKFAST—Fresh biscuits, house-made cured meats, jams, jellies, and more for the most important meal of the day. 6450 Poplar. 881-3346. B, L, $-$$
BOG & BARLEY—An all-Irish fine dining experience by the owners of Celtic Crossing, and a full bar with plenty of beer and 25-year-old Macallan. 6150 Poplar, Suite 124. 805-2262. L, D, WB, $-$$ BROOKLYN BRIDGE ITALIAN RESTAURANT—Specializing in such homemade entrees as spinach lasagna and lobster ravioli; a seafood specialty is horseradish-crusted salmon. Closed Sun. 1779 Kirby Pkwy. 755-7413. D, $-$$$
BRYANT’S BREAKFAST—Three-egg omelets, pancakes, and The Sampler Platter are among the popular entrees here. Possibly the best biscuits in town. Closed Mon. and Tues. 3965 Summer. 324-7494. B, L, $ CAPITAL GRILLE—Known for its dry-aged, hand-carved steaks; among the specialties are bone-in sirloin, and porcini-rubbed Delmonico; also seafood entrees and seasonal lunch plates. Closed for lunch Sat.Sun. Crescent Center, 6065 Poplar. 683-9291. L, D, $$$-$$$$ CASABLANCA—Lamb shawarma is one of the fresh, homemade specialties served at this Mediterranean/Moroccan restaurant; fish entrees and vegetarian options also available. 5030 Poplar. 725-8557; 1707 Madison. 421-6949. L, D, $-$$
CHUKIS TACOS 2—Traditional homestyle Mexican recipes. 3445 Poplar Ave., Suite 1. 888-4139. B, L, D, $-$$
CIAO BELLA—Among the Italian and Greek specialties are lasagna, seafood pasta, gourmet pizzas, and vegetarian options. 5101 Sanderlin Ave. 205-2500. D, MRA, $-$$$ CITY SILO TABLE + PANTRY—With a focus on clean eating, this establishment offers fresh juices, as well as comfort foods re-imagined with wholesome ingredients. 5101 Sanderlin. 729-7687. Germantown: 7605 W. Farmington Blvd., Suite 2. 236-7223. B, L, D, $ COASTAL FISH COMPANY—Upscale offerings of international fish varieties utilizing styles ranging from the Carribbean, East Coast, West Coast, China, Philippines, and more. 415 Great View Dr. E., Suite 101. 266-9000. D, $$-$$$
CORKY’S—Popular barbecue emporium offers both wet and dry ribs, plus a full menu of other barbecue entrees. Wed. lunch buffets, Cordova and Collierville. 5259 Poplar. 685-9744; 1740 N. Germantown Pkwy. (Cordova). 737-1911; 743 W. Poplar (Collierville). 405-4999; 6434 Goodman Rd., Olive Branch. 662-893-3663. L, D, MRA, $-$$
DAN MCGUINNESS PUB—Serves fish and chips, shepherd’s pie, burgers, and other Irish and American fare; also lunch and dinner specials. 4694 Spottswood. 761-3711; 3964 Goodman Rd. 662-8907611. L, D, $
DORY—Chef David Krog whips up Southern specialties with classic French techniques and locally sourced ingredients. Current specialties include pork tenderloin, beef bourguignon, or cocoa-dusted chocolate truffles, with new weekly additions. 716 W. Brookhaven Circle. 310-4290. L, D, $$-$$$
ERLING JENSEN—For decades, Chef Erling has presented “globally inspired” cuisine to die for. Specialties are rack of lamb, big-game entrees, and fresh fish dishes. 1044 S. Yates. 763-3700. D, MRA, $$-$$$
ERLING JENSEN SMALL BITES—Enjoy Erling Jensen’s specialty dishes in a sharable, small-plate format alongside TopGolf Swing suites. 5069 Sanderlin Ave. 587-9464. L, D, $-$$$
FLEMING’S PRIME STEAKHOUSE—Serves wet-aged and dry-aged steaks, prime beef, chops, and seafood, including salmon, Australian lobster tails, and a catch of the day. 6245 Poplar. 761-6200. D, MRA, $$$-$$$$
FOLK’S FOLLY ORIGINAL PRIME STEAK HOUSE
Specializes in prime steaks, as well as lobster, grilled Scottish salmon, Alaskan king crab legs, rack of lamb, and weekly specials. 551 S. Mendenhall. 762-8200. D, MRA, $$$-$$$$
FORMOSA—Offers Mandarin cuisine, including broccoli beef, hotand-sour soup, and spring rolls. Closed Mon. 6685 Quince. 753-9898. L, D, $-$$
FOX RIDGE PIZZA & GRILL—Pizzas, calzones, sub sandwiches, burgers, and meat-and-two plate lunches are among the dishes served at this eatery, which opened in 1979. 711 W. Brookhaven Circle. 758-6500. L, D, $
FRATELLI’S—Serves hot and cold sandwiches, salads, soups, and desserts, all with an Italian/Mediterranean flair. Closed Sun. 750 Cherry Rd., Memphis Botanic Garden. 766-9900. L, $
HALF SHELL—Specializes in seafood, such as king crab legs; also serves steaks, chicken, pastas, salads, sandwiches, a ”voodoo menu”; oyster bar at Winchester location. 688 S. Mendenhall. 682-3966; 7825 Winchester. 737-6755. L, D, WB, MRA, $-$$$
HEN HOUSE—Hybrid wine/cocktail bar and tasting room with plenty of cosmopolitan eats. Closed Sun. 679 S. Mendenhall. 499-5436. D, $-$$$
HIGH POINT PIZZA—Serves a variety of pizzas, subs, salads, and sides. Closed Mon. A neighborhood fixture. 477 High Point Terrace. 452-3339. L, D, $-$$
HOG & HOMINY—The casual sister to Andrew Michael Italian Kitchen serves brick-oven-baked pizzas, including the Red-Eye with pork belly, and small plates with everything from meatballs to beef and cheddar hot dogs; and local veggies. Closed for lunch Mon. 707 W. Brookhaven Cir. 207-7396. L, D, SB, MRA. $-$$$
HOUSTON’S—Serves steaks, seafood, pork chops, chicken dishes, sandwiches, salads, and Chicago-style spinach dip. Famous for first-class service. 5000 Poplar. 683-0915. L, D, X $-$$$
LA BAGUETTE—An almond croissant and chicken salad are among specialties at this French-style bistro. Closed for dinner Sun. 3088 Poplar. 458-0900. B, L, D (closes at 7), MRA, $
LAS DELICIAS—Popular for its guacamole, house-made tortilla chips, and margaritas, this restaurant draws diners with its chicken enchiladas, meat-stuffed flautas, and Cuban torta with spicy pork. Closed Sun. 4002 Park Ave. 458-9264; 5689 Quince. 800-2873. L, D, $
LIBRO AT LAURELWOOD—Bookstore eatery features a variety of sandwiches, salads, and homemade pasta dishes, with Italian-inspired options such as carbonara and potato gnocchi. Closed for dinner Sun. 387 Perkins Ext. (inside Novel). 800-2656. B, L, D, SB, $-$$
LITTLE ITALY EAST—New York-style pizzas galore and homemade pasta. Closed Sun. 6300 Poplar Ave., Ste. 113. 729-7432. L, $-$$
LOST PIZZA—Offering pizzas (with dough made from scratch), pasta, salads, sandwiches, tamales, and more. 2855 Poplar. 572-1803; 5960 Getwell (Southaven). 662-892-8684. L, D, $-$$
MAGNOLIA & MAY—Southern-inspired, family-owned, casual dining restaurant serving up a variety of sandwiches, chef-inspired dishes, and craft cocktails. Popular items include shrimp and grits and
the double cheeseburger. Closed Mon. 718 Mt. Moriah Rd. 676-8100. L, D, WB, MRA. $$-$$$
MAHOGANY MEMPHIS—Upscale Southern restaurant offers such dishes as coffee-rubbed lamb chops and baked Cajun Cornish hen. Closed for dinner Sun. and all day Mon.-Tues. 3092 Poplar, Suite 11. 623-7977. L, D, SB, $-$$$
MANDE DIBI WEST AFRICAN BBQ GRILL—Pairs traditional West African BBQ with Memphis BBQ for a menu that offers a wide variety of flavors, including daily specials and vegan-friendly options. 6825 Winchester Rd. 672-8995. L, D, $-$$$
MARCIANO MEDITERRANEAN AND ITALIAN CUISINE—Veal Saltimbocca with angel-hair pasta and white wine sauce is among the entrees; also steaks, seafood, and gourmet pizza. 780 E. Brookhaven Cir. 682-1660. D, $-$$
MAYURI INDIAN CUISINE—Serves tandoori chicken, masala dosa, tikka masala, as well as lamb and shrimp entrees; also a daily lunch buffet, and dinner buffet on Fri.-Sat. 6524 Quince Rd. 753-8755. L, D, $-$$
MELLOW MUSHROOM—Large menu includes assortment of pizzas, salads, calzones, hoagies, vegetarian options, and 50 beers on tap. 5138 Park Ave. 562-1211; 9155 Poplar, Shops of Forest Hill (Germantown). 907-0243. L, D, $-$$
MOSA ASIAN BISTRO—Specialties include sesame chicken, Thai calamari, rainbow panang curry with grouper fish, and other Pan Asian/fusion entrees. Closed Mon. 850 S. White Station Rd. 683-8889. L, D, MRA, $ NAM KING—Offers luncheon and dinner buffets, dim sum, and such specialties as fried dumplings, pepper steak, and orange chicken. 4594 Yale. 373-4411. L, D, $
NAPA CAFE—Among the specialties are miso-marinated salmon over black rice with garlic spinach and shiitake mushrooms. Closed Sun. 5101 Sanderlin, Suite 122. 683-0441. L, D, MRA, $$-$$$
ONE & ONLY BBQ—On the menu are pork barbecue sandwiches, platters, wet and dry ribs, smoked chicken and turkey platters, a smoked meat salad, barbecue quesadillas, Brunswick Stew, and Millie’s homemade desserts. 1779 Kirby Pkwy. 751-3615; 567 Perkins Extd. 249-4227. L, D, $
ONO POKÉ—This eatery specializes in poké — a Hawaiian dish of fresh fish salad served over rice. Menu includes a variety of poké bowls, like the Kimchi Tuna bowl, or customers can build their own by choosing a base, protein, veggies, and toppings. 3145 Poplar. 618-2955. L, D, $
OWEN BRENNAN’S—New Orleans-style menu of beef, chicken, pasta, and seafood; jambalaya, shrimp and grits, and crawfish etouffee are specialties. Closed for dinner Sun. The Regalia, 6150 Poplar. 761-0990. L, D, SB, MRA, $-$$$
PARK + CHERRY—The Dixon offers casual dining within the museum. Seasonal menu features sandwiches, like rustic chicken salad on croissant, as well as salads, snacks, and sweets. Closed for breakfast Sun. and all day Mon. 4339 Park (Dixon Gallery and Gardens). 761-5250. L, $ PATRICK’S—Serves barbecue nachos, burgers, and entrees such as fish and chips; also plate lunches and daily specials. 4972 Park. 682-2852. L, D, MRA, $
PETE & SAM’S—Serving Memphis for 60-plus years; offers steaks, seafood, and traditional Italian dishes, including homemade ravioli, lasagna, and chicken marsala. 3886 Park. 458-0694. D, $-$$$
PF CHANG’S CHINA BISTRO—Specialties are orange peel shrimp, Mongolian beef, and chicken in lettuce wraps; also vegetarian dishes, including spicy eggplant. 1181 Ridgeway Rd., Park Place Centre. 818-3889. L, D, $-$$
PHO SAIGON—Vietnamese fare includes beef teriyaki, roasted quail, curry ginger chicken, vegetarian options, and a variety of soups. 2946 Poplar. 458-1644. L, D, $
PYRO’S FIRE-FRESH PIZZA—Serving gourmet pizzas cooked in an open-fire oven, wide choice of toppings, and large local and craft beer selection. 1199 Ridgeway. 379-8294; 2035 Union Ave. 208-8857; 2286 N. Germantown Pkwy. (Cordova). 207-1198; 3592 S. Houston Levee (Collierville). 221-8109. L, D, MRA, $
THE READY ROOM—Duck wontons, bananas “Oscar,” and plenty of other bar snacks and entrees at Hook Point Brewing Co.’s taproom. Closed Mon./ Tues. 715 W. Brookhaven Cir. 487-6931. L, D, WB, $-$$
RED HOOK CAJUN SEAFOOD & BAR—Cajun-style array of seafood including shrimp, mussels, clams, crawfish, and oysters. 3295 Poplar. 207-1960. L, D, $-$$
RED KOI—Classic Japanese cuisine offered at this family-run restaurant; hibachi steaks, sushi, seafood, chicken, and vegetables. 5847 Poplar. 767-3456. L, D, X $-$$
RED PIER CAJUN SEAFOOD & BAR—Owners of Red Hook bring more Cajun-style seafood dishes. 5901 Poplar Ave. 512-5923. L, D, $-$$$
RESTAURANT IRIS—French Creole-inspired classics, such as Gulf shrimp and rice grits congee served with lap chong sausage and boiled peanuts, are served at this newly remodeled restaurant owned by Chef Kelly
English, a Food and Wine “Top Ten.” 4550 Poplar. 590-2828. L, D, $$-$$$
RIVER OAKS—Chef Jose Gutierrez’s French-style bistro serves seafood and steaks, with an emphasis on fresh local ingredients. Closed for lunch Sat. and all day Sun. 5871 Poplar Ave. 683-9305. L, D, $$$
RONNIE GRISANTI’S ITALIAN RESTAURANT— This Memphis institution serves some family classics such as Elfo’s Special and handmade ravioli, along with house-made pizza and fresh oysters. Closed Sun. 6150 Poplar, Suite 122. 850-0191. D, $-$$$
ROTOLO’S CRAFT & CRUST—Louisiana-based pizza company’s first Memphis location, whipping up pizza pies with homemade sauces and fresh ingredients, pasta, wings, and other shareables. 681 S. White Station. 454-3352. L, D, $-$$
RUTH’S CHRIS STEAK HOUSE—Offers prime steaks cut and aged in-house, as well as lamb, chicken, and fresh seafood, including lobster. 6120 Poplar. 761-0055. D, $$$-$$$$
SALSA—Mexican-Southern California specialties include carnitas, enchiladas verde, and fajitas; also Southwestern seafood dishes such as snapper verde. Closed Sun. Regalia Shopping Center, 6150 Poplar, Suite 129. 683-6325. L, D, $-$$
SEASONS 52—This elegant fresh grill and wine bar offers a seasonally changing menu using fresh ingredients, wood-fire grilling, and brick-oven cooking; also a large international wine list and nightly piano bar. Crescent Center, 6085 Poplar. 682-9952. L, D, $$-$$$
STAKS—Offering pancakes, including birthday cake and lemon ricotta. Menu includes other breakfast items such as beignets and French toast, as well as soups and sandwiches for lunch. 4615 Poplar. 509-2367; 3660 S. Houston Levee Road, Suite 104 (Collierville). 286-4335; 7704 Poplar (Germantown). 800-1951; 2902 May Blvd. (Southaven). B, L, WB, $
SWANKY’S TACO SHOP—Taco-centric eatery offers tortas, flatbreads, quesadillas, chimichangas, burgers, and more. 4770 Poplar. 730-0763; 6641 Poplar (Germantown). 737-2088; 272 S. Main. 779-3499. L, D, $
THREE LITTLE PIGS—Pork-shoulder-style barbecue with tangy mild or hot sauce, freshly made coleslaw, and baked beans. 5145 Quince Rd. 685-7094. B, L, D, $
TOPS BAR-B-Q—Specializes in pork barbecue sandwiches and sandwich plates with beans and slaw; also serves ribs, beef brisket, and burgers. 1286 Union. 725-7527; 4183 Summer. 324-4325; 5391 Winchester. 794-7936; 3970 Rhodes. 323-9865; 6130 Macon. 3710580. For more locations, go online. L, D, $ TORCHY’S TACOS—Plenty of Tex-Mex variety, with creative monthly special tacos. 719 S. Mendenhall. 343-8880. B, L, D, $ VENICE KITCHEN—Specializes in “eclectic Italian” and Southern Creole, from pastas, including the “Godfather,” to hand-tossed pizzas, including the “John Wayne”; choose from 50 toppings. 368 Perkins Ext. 767-6872. L, D, SB, $-$$
WANG’S MANDARIN HOUSE—Offers Mandarin, Cantonese, Szechuan, and spicy Hunan entrees, including the golden-sesame chicken; next door is East Tapas, serving small plates with an Asian twist. 6065 Park Ave., Park Place Mall. 763-0676. L, D, $-$$
WASABI—Serving traditional Japanese offerings, hibachi, sashimi, and sushi. The Sweet Heart roll, wrapped — in the shape of a heart — with tuna and filled with spicy salmon, yellowtail, and avocado, is a specialty. 5101 Sanderlin Rd., Suite 105. 421-6399. L, D, $-$$
THE WING GURU—A staple of the Memphis wing scene, featuring everything from classic buffalo to exquisite lemon pepper. 5699 Mt. Moriah Rd. 509-2405; 875 W. Poplar Ave., Suite 6 (Collierville). 2217488; 8253 Highway 51 North, Suite 103 (Millington). 872-0849; 4130 Elvis Presley Blvd (Whitehaven) 791-4726; 5224 Airline Rd., Suite 107 (Arlington). 209-0349. L, D, $-$$
WOMAN’S EXCHANGE TEA ROOM—Chicken-salad plate, beef tenderloin, soups-and-sandwiches, vegetable plates, and homemade desserts are specialties. Closed Sat.-Sun. 88 Racine. 327-5681. L, $
CORDOVA
THE BLUE ROOM RESTAURANT—An elevated take on traditional Southern recipes, located in the U of M Kemmons Wilson Culinary Institute. Closed Mon. 1245 N. Germantown Pkwy., Suite 101. 249-7512. D, SB, $$-$$$
BOMBAY HOUSE—Indian fare includes lamb korma and chicken tikka; also, a daily luncheon buffet. 1727 N. Germantown Pkwy. 755-4114. L, D, $-$$
THE BUTCHER SHOP—Serves steaks ranging from 8-oz. filets to a 20-oz. porterhouse; also chicken, pork chops, fresh seafood. 107 S. Germantown Rd. 757-4244. L (Fri. and Sun.), D, $$-$$$




Mon, Nov 18 and Tue, Nov 19 7:00 PM Channel 10


GREEN BAMBOO—Pineapple tilapia, pork vermicelli, and the soft egg noodle combo are Vietnamese specialties here. 990 N. Germantown Parkway, Suite 104. 753-5488. L, D, $-$$
JIM ’N NICK’S BAR-B-Q—Serves barbecued pork, ribs, chicken, brisket, and fish, along with other homemade Southern specialties. 2359 N. Germantown Pkwy. 388-0998. L, D, $-$$
EL MERO TACO—This food truck turned restaurant serves up Mexican and Southern-style fusion dishes, including fried chicken tacos, chorizo con papas tacos, and brisket quesadillas. 8100 Macon Station, Suite 102. 308-1661. Closed Sun.-Mon. L, D, WB, $ OPTIONS Burgers, wings, philly cheesesteaks, and more comfort food options. Closed Mon.-Thu. 7940 Fischer Steel Rd. 245-6048. D, SB, $-$$
POKÉ WORLD—Serves up Hawaiian poké bowls filled with rice and diced, raw fish. Also offers Taiwanese bubble tea and rolled ice cream for dessert. 1605 N. Germantown Pkwy., Suite 111. 623-7986. East Memphis: 575 Erin Dr. 779-4971. L, D, $
SHOGUN JAPANESE RESTAURANT—Entrees include tempura, teriyaki, and sushi, as well as grilled fish and chicken entrees. 2324 N. Germantown Pkwy. 384-4122. L, D, $-$$
TANNOOR GRILL—Brazilian-style steakhouse with skewers served tableside, along with Middle Eastern specialties; vegetarian options also available. 830 N. Germantown Pkwy. 443-5222. L, D, $-$$$
GERMANTOWN
BLUE HONEY BISTRO—Entrees at this upscale eatery include brown butter scallops served with Mississippi blue rice and herbcrusted beef tenderloin with vegetables and truffle butter. Closed Sun. 9155 Poplar, Suite 17. 552-3041. D, $-$$$
THE CRAZY COOP—Plenty of hot wings and sauces, plus sandwiches and other dinner plates. 1315 Ridgeway Rd. 748-5325; 7199 Stage Rd. (Bartlett). 433-9212. L, D, $-$$
DIMSUM MEM—Traditional Chinese food truck takes over the New Asia space. 2075 Exeter Rd., Suite 90. L, D, $-$$
GERMANTOWN COMMISSARY—Serves barbecue sandwiches, sliders, ribs, shrimp, and nachos, as well as smoked barbecued bologna sandwiches; Mon.-night all-you-can-eat ribs. 2290 S. Germantown Rd. S. 754-5540. L, D, MRA, $-$$
LAS TORTUGAS DELI MEXICANA—Authentic Mexican food prepared from local food sources; specializes in tortugas — grilled bread scooped out to hold such powerfully popular fillings as brisket, pork, and shrimp; also tingas, tostados. Closed Sun. 1215 S. Germantown Rd. 751-1200; 6300 Poplar. 623-3882. L, D, $-$$
LIMELIGHT—Wolf River Hospitality Group brings Wagyu beef, duck gnocchi, and other fine dining dishes on a rotating seasonal menu. Closed Mon./Tue. 7724 Poplar Pike. 791-2328. D, $-$$$
LOCAL LIME—Tacos and margaritas in a casual environment, plus other goodies like the Mexican caramel apple crisp skillet. Closed Mon. 7605 W. Farmington Blvd., Suite 1. 224-2204. L, D, $-$$$
MOONDANCE GRILL—From the owners of Itta Bena and Lafayette’s. Serves steak cooked sous vide and seafood dishes including Abita-barbecued shrimp and pan-seared sand dab, in addition to an extensive wine and cocktail list. 1730 S. Germantown Road, Suite 117. 755-1471. L, D, $$-$$$
NOODLES ASIAN BISTRO—Serves a variety of traditional Asian cuisine, with emphasis on noodle dishes, such as Singapore Street Noodles and Hong Kong Chow Fun. 7850 Poplar, Suite 12. 755-1117. L, D, $ PETALS OF A PEONY—Authentic Sichuan cuisine, from crispy duck to peony fried chicken. Be prepared for spice! 1250 N. Germantown Pkwy. 787-8886. L, D, $-$$
PETRA CAFÉ—Serves Greek, Italian, and Middle Eastern sandwiches, gyros, and entrees. Hours vary; call. 6641 Poplar. 754-4440; 547 S. Highland. 323-3050. L, D, $-$$
ROCK’N DOUGH PIZZA CO.—Specialty and custom pizzas made from fresh ingredients; wide variety of toppings. 7850 Poplar, Suite 6. 779-2008. L, D, SB, MRA, $$
ROYAL PANDA—Hunan fish, Peking duck, Royal Panda chicken and shrimp, and a seafood combo are among the specialties. 3120 Village Shops Dr. 756-9697. L, D, $-$$
SAKURA—Sushi, tempura, and teriyaki are Japanese specialties here. 2060 West St. 758-8181; 4840 Poplar. 572-1002; 255 New Byhalia Rd. 316-5638. L, D, $-$$
SOUTHERN SOCIAL—Shrimp and grits, stuffed quail, and Aunt Thelma’s Fried Chicken are among the dishes served at this upscale Southern establishment. 2285 S. Germantown Rd. 754-5555. D, SB, MRA, $-$$$ STONEY RIVER STEAKHOUSE AND GRILL—Specializes in hand-cut steaks, a fresh seafood selection, and plenty of house specials. 7515 Poplar Ave., Suite 101. 207-1100. L, D, $$-$$$$
SUFI’S MEDITERRANEAN GRILL & BAR—Offers authentic Mediterranean and Persian cuisine, from hummus shawarma to traditional moussaka. Closed Mon. 7609 Poplar Pike. 779-2200. L, D, $-$$$
TAZIKI’S—Mediterranean-inspired dishes all made from scratch. 7850 Poplar Ave., Suite 26. 612-2713. East Memphis: 540 S. Mendenhall Rd. 290-1091. Bartlett: 7974 US-64. 203-0083. L, D, $
THE TOASTED YOLK CAFE—Churro donuts, signature Eggs Benedict, and plenty other boozy brunch options at this franchise’s first Tennessee location. 9087 Poplar Ave., Ste. 11. B, L, $-$$
UNCLE GOYO’S—More than 30 dishes with a focus on authentic Mexican cuisine, from the brains behind TacoNganas. 1730 S. Germantown Rd. L, D, $-$$
WEST STREET DINER—This home-style eatery offers breakfast, burgers, po’boys, and more. 2076 West St. 757-2191. B, L, D (Mon.-Fri.), $
ZEN JAPANESE FINE CUISINE—A full sushi bar and plenty of authentic Japanese dishes, like Hibachi or Wagyu beef. 1730 S. Germantown Rd. 779-2796. L, D, X, $-$$$
COLLIERVILLE
CAFE PIAZZA BY PAT LUCCHESI—Specializes in gourmet pizzas (including create-your-own), panini sandwiches, and pasta. Closed Sun. 139 S. Rowlett St. 861-1999. L, D, $-$$
CIAO BABY—Specializing in Neapolitan-style pizza made in a woodfired oven. Also serves house-made mozzarella, pasta, appetizers, and salads. 890 W. Poplar, Suite 1. 457-7457. L, D, $
COLLIERVILLE COMMISSARY—Serves barbecue sandwiches, sliders, ribs, shrimp, and nachos, as well as smoked barbecued bologna sandwiches. 3573 S. Houston Levee Rd. 979-5540. L, D, MRA, $-$$
DAVID GRISANTI’S ON MAIN—Serving Northern Italian cuisine and traditional Grisanti family recipes. Closed Sun./Mon. 148 N. Main. 861-1777. L, D, $-$$$
DYER’S CAFE—Juicy hamburgers, split dogs, and milkshakes at the historic Collierville restaurant. 101 N. Center St. 850-7750. L, D, $-$$
EL MEZCAL—Serves burritos, chimichangas, fajitas, and other Mexican cuisine, as well as shrimp dinners and steak. 9947 Wolf River, 853-7922; 402 Perkins Extd. 761-7710; 694 N. Germantown Pkwy. (Cordova). 755-1447; 1492 Union. 274-4264; 11615 Airline Rd. (Arlington). 8671883; 9045 Highway 64 (Lakeland). 383-4219; 7164 Hacks Cross Rd. (Olive Branch). 662-890-3337; 8834 Hwy. 51 N. (Millington). 872-3220; 7424 Highway 64 (Bartlett). 417-6026. L, D, $
EMERALD THAI RESTAURANT—Spicy shrimp, pad khing, lemongrass chicken, and several noodle, rice, and vegetarian dishes are offered at this family restaurant. Closed Sunday. 8950 Highway 64 (Lakeland, TN). 384-0540. L, D, $-$$
FIREBIRDS—Specialties are hand-cut steaks, slow-roasted prime rib, and wood-grilled salmon and other seafood, as well as seasonal entrees. 4600 Merchants Circle, Carriage Crossing. 850-1637; 8470 Highway 64 (Bartlett). 379-1300. L, D, $-$$$
JIM’S PLACE GRILLE—Features American, Greek, and Continental cuisine. Closed for lunch Sat. and all day Sun. 3660 Houston Levee. 861-5000. L, D, MRA, $-$$$
MAROON BREW CO.—Family-friendly restaurant serving up gourmet hot dogs, smash burgers, chicken, and shareables, all made to pair with beers brewed on-site. Closed Mon. 642 W. Poplar Ave., Collierville. 799-0354. L, D, $-$$
MULAN ASIAN BISTRO—Hunan Chicken, tofu dishes, and orange beef served here; sushi and Thai food, too. 2059 Houston Levee. 8505288; 2149 Young. 347-3965; 4698 Spottswood. 609-8680. L, D, $-$$
NASHOBA—Offers live music, sports games, and pub classics. Specialties are hot honey flatbread pizza, brisket fried rice, and the Nashoba burger. 4600 Merchants Park Circle, Suite 111, Collierville. 630-4683. L, D, wheelchair accessible, $-$$
OSAKA JAPANESE CUISINE—Featuring an extensive sushi menu as well as traditional Japanese and hibachi dining. Hours vary for lunch; call. 3670 Houston Levee. 861-4309; 3402 Poplar. 249-4690; 7164 Hacks Cross (Olive Branch). 662-890-9312; 2200 N. Germantown Pkwy. (Cordova). 425-4901. L, D, $-$$$
RAVEN & LILY—Eatery offers innovative Southern-inspired cuisine with such dishes as crispy shrimp and cauliflower salad, spiced lamb sausage and parmesan risotto, and bananas foster pain perdu. Closed Mon. 120 E. Mulberry. 286-4575. L, D, SB, $-$$
STIX—Hibachi steakhouse with Asian cuisine features steak, chicken, and a fillet and lobster combination, also sushi. A specialty is Dynamite Chicken with fried rice. 4680 Merchants Park Circle, Avenue Carriage Crossing. 854-3399. 150 Peabody Place, Suite 115 (Downtown). 207-7638 L, D, $-$$
WOLF RIVER BRISKET CO.—From the owners of Pyro’s Fire Fresh Pizza, highlights include house-smoked meats: prime beef brisket, chicken, and salmon. Closed Sun. 9947 Wolf River Boulevard, Suite 101. 316-5590; 1350 Concourse Ave., Suite 165. 791-4389 L, D, $-$$
ZOPITA’S ON THE SQUARE—Cafe offers sandwiches, including smoked salmon and pork tenderloin, as well as salads and desserts. Closed Sun. 114 N. Main. 457-7526. L, D, $
BOZO’S HOT PIT BAR-B-Q—Barbecue, burgers, sandwiches, and subs. 342 Highway 70 (Mason, TN). 901-294-3400. L, D, $-$$
CITY GROCERY—Southern eclectic cuisine; shrimp and grits is a specialty. Closed for dinner Sun. 152 Courthouse Square (Oxford, MS). 662-232-8080. L, D, SB, $$-$$$
COMO STEAKHOUSE—Steaks cooked on a hickory charcoal grill are a specialty here. Upstairs is an oyster bar. Closed Sun. 203 Main St. (Como, MS). 662-526-9529. D, $-$$$
ELFO GRISANTI’S NORTHERN ITALIAN CUISINE—Grisanti family classics like lasagna, homemade ravioli, garlic bread, and Northern Italian pizza. Closed Sun. 5627 Getwell Rd. (Southaven, MS). 662-4704497. L, D, $-$$
CHICAGO STEAKHOUSE AT THE GOLDSTRIKE—1010 Casino Center Dr., Robinsonville, MS, 1-888-24KSTAY / 662-357-1225
FAIRBANKS AT THE HOLLYWOOD—1150 Casino Strip Blvd., Robinsonville, MS, 1-800-871-0711
IGNITE STEAKHOUSE AT SOUTHLAND CASINO RACING—1550 N. Ingram Blvd., West Memphis, AR, 1-800-467-6182
JACK BINION’S STEAK HOUSE AT HORSESHOE—1021 Casino Center Drive, Robinsonville, MS, 1-800-303-SHOE
LUCKY 8 ASIAN BISTRO AT HORSESHOE—1021 Casino Center Drive, Robinsonville, MS, 1-800-303-SHOE
SOUTHLAND CASINO HOTEL'S THE KITCHENS—1550 N. Ingram Blvd., West Memphis, AR, 1-800-467-6182
THE STEAKHOUSE AT THE FITZ—711 Lucky Ln., Robinsonville, MS, 1-888-766-LUCK, Ext. 8213
TWAIN’S STEAKHOUSE AT SAM’S TOWN TUNICA—1477 Casino Strip Resorts Boulevard, Robinsonville, MS, 1-800-456-0711
MANILA FILIPINO RESTAURANT—Entrees include pork belly cutlet with lechon sauce, and shrimp and vegetables in tamarind broth; also daily combos, rice dishes, and chef specials. Closed Sun.-Mon. 7849 Rockford (Millington, TN). 209-8525. L, D, $
MARSHALL STEAKHOUSE—Rustic steakhouse serves premium Angus beef steaks, seafood dishes, rack of lamb, and more. 2379 Highway 178 (Holly Springs, MS). 628-3556. B, L, D, $-$$$
MEMPHIS BARBECUE COMPANY—Offers spare ribs, baby backs, and pulled pork and brisket. 709 Desoto Cove (Horn Lake, MS). 662-536-3762. L, D, $-$$
PIG-N-WHISTLE—Offers pork shoulder sandwiches, wet and dry ribs, catfish, nachos, and stuffed barbecue potatoes. 6084 Kerr-Rosemark Rd. (Millington, TN). 872-2455. L, D, $
SAINT LEO’S—Offering sophisticated pizzas, pastas, sandwiches, and salads. A James Beard nominee for Best New Restaurant in 2017. 1101 Jackson (Oxford, MS). 662-234-4555. D, L, WB, $-$$
SIMON’S—A unique dining experience situated in a charming small town. Closed Sun./Mon. 201 N. Main St. (Bolivar, TN). 731403-3474. L, D, $$-$$$$
SNACKBAR—An intriguing mix of “French Bistro with North Mississippi Cafe.” Serving a confit duck Croque Monsieur, watermelon-cucumber chaat, pan-fried quail, plus a daily plate special and a raw bar. 721 N. Lamar (Oxford, MS). 662-236-6363. D, $-$$$
TEKILA MODERN MEXICAN—Modern interpretations of classic dishes from all over Mexico. 6343 Getwell Rd. (Southaven, MS). 662-510-5734. B, L, D, $-$$
WILSON CAFE—An impressive culinary destination in the heart of the Arkansas Delta. Serving jambalaya, Waygu flatiron, butternut ravioli, swordfish & shrimp kabobs, burgers. 2 N. Jefferson (Wilson, AR). 870655-0222. L, D, WB, $-$$$

above: Little remained of the DC-3 after it plunged into the Mississippi River on the night of February 10, 1944. Vessels from the U.S. Army Corps of Engineers, such as the Arkansas II (shown here) assisted with the recovery efforts, but all they pulled up with hooks and dredges were pieces of the plane. Investigators never determined a cause for the crash, at the time the secondworst aviation disaster in American history.


Dear Editor,
I’ve been an aviator since 1962. I’m amazed at the thoroughness of your article about the Sun Country Special [September 2024]. Most authors of aviation-related stories omit crucial data. Yours did not.
I seriously considered every aeronautical and mechanical possibility of the cause of this crash, and believe it’s only to be found in the bird feathers penetrating the passengers’ luggage.
The low altitude (descending from 5,000 feet); the throttles being jockeyed from cruise power to full retard, then back to full power; the probability of caved-in windscreens (windshields); and the possibility of clogged carburetor air intakes (which may well cause a rich mixture resulting in backfiring; and most importantly the Mississippi Flyway used by hundreds of thousands of waterfowl at night (when pilots can’t see them) — all these details add up to bird strikes. Tornadoes have caused hay straw to be driven into telephone poles. The knowledge of the bird feathers says it all.
I also wanted to add that one of the engines the DC-3 used (either Wright Cyclone or Pratt & Whitney) had its carburetor intake mounted on the front. If anything — such as a bird — blocked the carburetor there would be no air to the engine. Hence, the backfiring and explosions heard by some witnesses.
It is a great subject, and very well written.
From an old pilot, many thanks,
Eric Mingledorff memphis
Dear Editor, W hat a great story! I don’t doubt that it could have been a “bird strike.” Having seen a few busted helicopter windshields and cabins full of feathers and geese flesh in my long aeromedical career as a flight nurse with the air ambulance service Hospital Wing, I can easily imagine this happening near the fields and river at night back then.
Barbara Gale Wells millington
Dear Editor,
G reat article! I could see how a bird strike or hitting a flock of waterfowl could bring down the plane. All it would take is a few birds in one or both engines and one through the glare shield to disorient or knock out the pilot. That low, they would not have time to recover.
Joe Larkins
memphis
Paying respects to a legend.
BY FRANK MURTAUGH

It took me more than three decades and a 250-mile drive from Memphis into the heart of Alabama, but I have proof that Bear Bryant was, in fact, mortal. Not long ago, I paid a visit to Elmwood Cemetery in Birmingham and on a gray, rainy Saturday afternoon, found the resting place of college football’s most iconic coach, certainly as measured in the Yellowhammer State (or those states bordering it).
Legends, they tell us, never die. But men do. And Paul W. Bryant died on January 26, 1983, four weeks after coaching his final game, a Crimson Tide victory over Illinois in the 1982 Liberty Bowl in Memphis. He took to his grave the most wins in the history of his sport at the time (323) and six national championships as coach of his alma mater.
But Bryant’s numbers are but dressing to his legend, one built on the kind of toughness a man displays in wrestling a bear at age 13 or incorporating methods just this side of institutional abuse in building a football team. (Read e Junction Boys, the story of a 10-day summer camp conducted by Bryant in 1954, his fi rst year as head coach at Texas A & M.)
To be clear, I’m no fan of the Crimson Tide and will never sport a houndstooth hat in honor of a football coach, living or dead. I was born in Knoxville, the son of University of Tennessee alumni. (My dad was a junior halfback at Central High School here in Memphis in 1958 when Bryant took over in Tuscaloosa.) e third Saturday in October was rarely pleasant in Big Orange country during Bryant’s tenure at Alabama. His teams went 17-6-2 against the Vols, enjoying a dominant
11-game winning streak (1971-81) during which they allowed UT as many as 20 points just once.
Cry me a river, say fans in Oxford, Baton Rouge, and especially Auburn. e Bear dominated the Southeastern Conference, helped integrate the SEC, and did it all with a cigarette and stiff drink nearby. If we could wake the dead for one quote and one quote only, I’d like to ask Bear Bryant what he thinks of Twitter. Or TikTok. ( e quote would be a single word before another sip of bourbon.)
Birmingham’s Elmwood Cemetery is enormous: more than 400 acres with more than 120,000 human beings interred. ere is but one gravestone for Bear Bryant, though, and it attracts so many pilgrims that red stripes (crimson stripes) have been painted along the narrow roads leading to Block 30.
Even upon locating Block 30, I needed some direction to fi nd the Bear’s resting place. e man coordinating a grave-digging crew kindly directed me: “He’s over there, across from that tree, in a triangle.” is was an awkward inquiry, a person much more recently deceased than the Bear being laid to rest nearby as I pursued a personal mission. But it was taken with grace — he’d answered this question before — and note the present tense in the directions I received. Bear Bryant was the coach at Alabama … but he is still “over there,” near a tree in an Alabama graveyard. And honestly, everywhere else college football is held in high regard.
Near a large marker with the family names Bryant and Folmar, I finally found Bryant’s marker. And that’s all it can be called: a marker. No larger than two feet by one foot, the granite stone is inscribed, “Paul William Bryant, Sr. / Sept. 11, 1913 / Jan. 26, 1983.” It is almost precisely the size and style of my father’s marker in Jackson, Tennessee. By this measure, the Bear and my dad are equals. Dad would chuckle at the notion and point out that he was, in fact, a better fisherman than the coaching legend. Bryant’s stone had several coins on it, and a single red flower. Never forgotten, to say the least.
Each of us can become a legend, if only to one other family member, friend, or beneficiary. It’s the numbers we reach — and how we reach them — that make a legend grow, and Bear Bryant’s is beyond measure. (Schools in Alabama were let out the day of his death, a Wednesday.) I’ll relish my journey to the Bear’s resting place for the irony of that tiny headstone representing a man so tremendous in the memories of so many. Measure a man not by the size of his tombstone, but by the endurance of his impact. For some, there’s no cemetery large enough.



Imagine having a transitional living space to enjoy the best of the outdoors in your own backyard. With Phantom Screens, it’s possible. Fully customizable and professionally installed, Phantom Screens appear at the touch of a button providing fresh air and shade from the sun without worrying about the bugs. They preserve your home’s design and won’t get in the way of your view by retracting completely out of sight when not in use.


